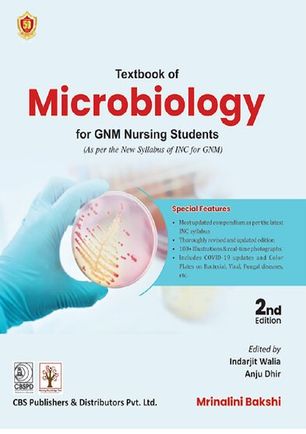
cover

| Number |
Cover |
TextBook for Nursing |
Author |
Edition |
| 0 |
 |
Advanced Health Assessment and Diagnostic Reasoning |
Jacqueline Rhoads, Sandra Wiggins Petersen |
4 |
| 1 |
 |
Davis's Comprehensive Manual of Laboratory and Diagnostic Tests with Nursing Implications |
Anne M Van Leeuwen Mickey L Bladh |
8 |
| 2 |
 |
Disaster Nursing and Emergency Preparedness for Chemical, Biological and Radiological Terrorism and Other Hazards |
Tener Goodwin Veenema |
2 |
| 3 |
 |
Patient Care in Radiography_ With an Introduction to Medical Imaging |
Ruth Ann Ehrlich RT(R), Joan A. Daly RT(R) MBA |
1 |
| 4 |
 |
Advanced clinical skills for gu nurses |
Matthew Grundy-Bowers, Jonathan Davies |
1 |
| 5 |
 |
Advanced health assessment and diagnostic reasoning |
Jacqueline Rhoads, Sandra Wiggins Petersen |
3 |
| 6 |
 |
Advanced Nursing Skills Principles and Practice |
Molly Courtenay, Michele Butler |
1 |
| 7 |
 |
Advanced Practice and Leadership in Radiology Nursing |
Kathleen A. Gross |
1 |
| 8 |
 |
Advanced practice in healthcare dynamic developments in nursing and allied health professions |
Paula McGee, Chris Inman |
4ed |
| 9 |
 |
Advanced Practice Nursing Core Concepts for Professional Role Development, |
Dr. Michalene Jansen, Mary Zwygart-Stauffacher |
4 |
| 10 |
 |
Advanced Practice Nursing Emphasizing Common Roles |
Dr Joan Stanley |
2 |
| 11 |
 |
Advanced Practice Nursing Essential Knowledge for the Profession |
Susan M. DeNisco, Anne M. Barker |
3 |
| 12 |
 |
Advanced Practice Nursing Essential Knowledge for the Profession |
Lynne M Dunphy, Jill Winland-Brown, Brian o. Porter, Debera J. Thomas |
4 |
| 13 |
 |
Advanced Practice Nursing Essentials of Role Development |
Lucille A. Joel |
2nd Edition |
| 14 |
 |
Advanced practice nursing in the care of older adults |
Laurie Kennedy-Malone , Lori Martin-Plank , Evelyn Groenke Duffy |
2 |
| 15 |
 |
Advanced practice nursing roles core concepts for professional development |
Kathryn A Blair |
6 |
| 16 |
 |
Advanced Practice Nursing An Integrative Approach, |
Ann B. Hamric, Judith A. Spross, Charlene M. Hanson |
4 |
| 17 |
 |
Advanced Practice Nursing Emphasizing Common Roles, |
Joan M. Stanley |
3 |
| 18 |
 |
Advanced Practice Palliative Nursing [1 ed.] |
Constance Dahlin, Patrick J. Coyne, Betty R. Ferrell |
1 |
| 19 |
 |
Care of the Obese in Advanced Practice Nursing Communication, Assessment, and Treatment |
Lisa L.M. Maher |
1 |
| 20 |
 |
Case Studies in Gerontological Nursing for the Advanced Practice Nurse |
Meredith Wallace Kazer, Leslie Neal-Boylan |
1 |
| 21 |
 |
Clinical Consult to Psychiatric Nursing for Advanced Practice |
Jacqueline Rhoads, Patrick Murphy |
1 |
| 22 |
 |
Clinical Leadership in Nursing and Healthcare Values into Action |
David Stanley |
2 |
| 23 |
 |
Clinical Nursing Skills and Techniques |
Anne Griffin Perry, Patricia A. Potter, Wendy R. Ostendorf |
8 |
| 24 |
 |
Clinical Nursing Skills Pearson New International Edition |
Sandra F. Smith, Donna J. Duell , Barbara Martin |
8 |
| 25 |
 |
Clinical Skills in Nursing: The return of the practical room? |
Maggie Nicol BSc(Hons), MSc, RGN, DN, PGDip(Ed), Sally Glen MA(Ed), MA(Philosophy), DipEd(Lond), DipNEd, DN(Lond), RN, RSCN, RNT (eds.) |
|
| 26 |
 |
Comprehensive Systematic Review for Advanced Nursing Practice |
Cheryl Holly, Susan Warner Salmond, Marie K. Saimbert |
1 |
| 27 |
 |
Contemporary medical surgical nursing [2nd ed] |
Rick Daniels, RN |
2 |
| 28 |
 |
Critical Care Nursing Monitoring and Treatment for Advanced Nursing Practice |
Kathy Booker |
1 |
| 29 |
 |
Davis's Guide to Clinical Nursing Skills |
Jacqueline Rhoads, Bonnie Juve Meeker |
1 |
| 30 |
 |
Delmar's Fundamental and Advanced Nursing Skills, |
Gaylene Altman |
2 |
| 31 |
 |
Diet therapy in advanced practice nursing nutrition prescriptions for improved patient outcomes |
Katie Ferraro, Cheryl Haas Winter |
1 |
| 32 |
 |
ECG Interpretation Made Incredibly Easy! |
Jessica Shank Coviello |
6 |
| 33 |
 |
Essentials of Nursing Leadership & Management, Second Edition [2nd Edition] |
Patricia Kelly |
2 |
| 34 |
 |
Foundations of Adult Health Nursing |
Lois White, Gena Duncan, Wendy Baumle |
3 |
| 35 |
 |
Fundamental Nursing Skills |
Penelope Ann Hilton |
1 |
| 36 |
 |
Fundamentals of Nursing |
Sue C. DeLaune, Patricia Kelly Ladner |
4ed |
| 37 |
 |
Role Development for Doctoral Advanced Nursing Practice |
Michael Dreher, Mary Ellen Smith Glasgow |
1 |
| 38 |
 |
Health Policy and Advanced Practice Nursing Impact and Implications |
Kelly A. Goudreau, Mary C. Smolenski |
1 |
| 39 |
 |
International Council of Nurses Advanced Nursing Practice |
Madrean Schober, Fadwa Affara |
1 |
| 40 |
 |
Introduction to Advanced Nursing Practice An International Focus |
Madrean Schober (auth.) |
1 |
| 41 |
 |
Outcome assessment in advanced practice nursing |
Ruth M. Kleinpell |
3 |
| 42 |
 |
Law and Ethics in Advanced Practice Nursing |
Ms. Diane Kjervik, Edith Ann Brous |
1 |
| 43 |
 |
Lippincott's Advanced Skills for Nursing Assistants A Humanistic Approach to Caregiving |
Pamela J. Carter, Amy Stegen |
1 |
| 44 |
 |
Managing Your Practice A Guide for Advanced Practice Nurses (Springer Series on Nursing Management and Leadership) |
Joyce J. Fitzpatrick, Ann Glasgow, Jane Young |
1 |
| 45 |
 |
Maternal, Neonatal, and Women's Health Nursing |
Lynna Y. Littleton, Joan C. Engebretson |
1 |
| 46 |
 |
Nurse Practitioners Evolution of Advanced Practice (Advanced Practice Nursing) |
Mathy D. Mezey, Diane O. McGivern, Eileen M. Sullivan-Marx |
4 |
| 47 |
 |
Nurse's manual of laboratory and diagnostic tests |
Bonita Morrow Cavanaugh |
4 |
| 48 |
 |
Nursing Informatics for the Advanced Practice Nurse Patient Safety, Quality, Outcomes, and Interprofessionalism |
Susan McBride, Mari Tietze |
1 |
| 49 |
 |
Nursing leadership and management the advanced practice role |
Denise M. Korniewicz |
1 |
| 50 |
 |
Nursing Medical Emergency Patients |
Philip Jevon, Melanie Humphreys, Beverly Ewens |
1 |
| 51 |
 |
Oxford handbook of clinical skills for children's and young people's nursing |
Paula Dawson, Louise Cook, Laura-Jane Holliday, Helen Reddy |
1 |
| 52 |
 |
Philosophies and Theories for Advanced Nursing Practice |
Janie B. Butts, Karen L. Rich |
1 |
| 53 |
 |
Physical Health and Well-Being in Mental Health Nursing Clinical Skills for Practice |
Michael Nash |
1 |
| 54 |
 |
Physical health and well-being in mental health nursing clinical skills for practice |
Michael Nash |
2 |
| 55 |
 |
Population-based nursing concepts and competencies for advanced practice |
Ann L. Cupp Curley, Patty A. Vitale |
2 |
| 56 |
 |
Primary Care Art and Science of Advanced Practice Nursing |
Lynne M. Dunphy, Jill E. Winland-Brown, Brian O. Porter, Debera J. Thomas |
3 |
| 57 |
 |
Professional development, reflection and decision-making in nursing and health care |
Melanie Jasper, Megan Rosser, Gail Mooney |
2 |
| 58 |
 |
Psychiatric Nursing Certification Review Guide for the Generalist and Advanced Practice Psychiatric and Mental Health Nurse, |
Victoria Mosack |
3 |
| 59 |
 |
Advanced Practice in Endocrinology Nursing |
Sofia Llahana, Cecilia Follin, Christine Yedinak, Ashley Grossman |
1 |
| 60 |
 |
Strategic Planning for Advanced Nursing Practice |
Madrean Schober (auth.) |
1 |
| 61 |
 |
Taylor s Clinical Nursing Skills A Nursing Process Approach |
Pamela Lynn |
5 |
| 62 |
 |
The Doctor of Nursing Practice Essentials A New Model for Advanced Practice Nursing |
Mary Zaccagnini, Kathryn White |
1 |
| 63 |
 |
Women's Health Care in Advanced Practice Nursing |
Catherine Ingram Fogel, Nancy Fugate Woods |
1 |
| 64 |
 |
A nurse's handbook of obstetrics, for use in training-schools |
Joseph Brown Cooke |
|
| 65 |
 |
Pediatric nursing care plans for the hospitalized child |
Sharon Ennis Axton |
|
| 66 |
 |
Fluids & Electrolytes Made Incredibly Easy! |
|
6 |
| 67 |
 |
Fundamentals of Anatomy and Physiology For Nursing and Healthcare Students |
Ian Peate, Muralitharan Nair |
2 |
| 68 |
 |
Fundamentals of Applied Pathophysiology: An Essential Guide for Nursing and Healthcare Students [Third Edition] |
Ian Peate |
3 |
| 69 |
 |
Maternal-newborn nursing demystified |
Joyce Y Johnson |
1 |
| 70 |
 |
Nursing Pharmacology Made Incredibly Easy [Incredibly Easy! Series] |
Judith Schilling McCann |
3 |
| 71 |
 |
Brunner & Suddarth's textbook of Medical-Surgical Nursing 13ed |
Janice L. Hinkle, Kerry H. Cheever |
13 |
| 72 |
 |
Chronic Disease Nursing A Rheumatology Example |
Susan M Oliver |
1 |
| 73 |
 |
Clinical Decision Making Case Studies in Medical-Surgical Nursing |
Gina M. Ankner |
2 |
| 74 |
 |
Community, Public, and Population Health Nursing |
|
|
| 75 |
 |
Comprehensive Neonatal Nursing Care |
Carole Kenner, Leslie B. Altimier, Marina V. Boykova |
6 |
| 76 |
 |
Davis Success Series Pediatric Success A Course Review Applying Critical Thinking Skills to Test Taking |
Beth Richardson |
1 |
| 77 |
 |
Davis's success series Med-surg success a Q & A review applying critical thinking to test taking |
Kathryn Cadenhead Colgrove |
3 |
| 78 |
 |
Davis's Success Series Pediatric Success NCLEX-style Q&A Review |
Beth Richardson |
1 |
| 79 |
 |
Davis's Success Series Maternal and Newborn Success A Course Review Applying Critical Thinking to Test Taking |
Margot Desevo |
1 |
| 80 |
 |
Development of Neonatal Nursing Care Clinical Competency-Based Assessment Tool for Nurse ... |
Ellemes Everret Phuma |
|
| 81 |
 |
Drug Therapy in Rheumatology Nursing |
Sarah Ryan |
2 |
| 82 |
 |
Essentials of Pediatric Nursing |
Terri Kyle, Susan Carman |
2nd |
| 83 |
 |
Essentials of pharmacology for nurses |
Paul Barber and Deborah Robertson |
3 |
| 84 |
 |
Ethics in paediatric nursing [1 ed.] |
Gosia M. Brykczyńska (auth.), Gosia M. Brykczyńska RGN,RSCN,Onc. Cert,RNT,BA,BSc,Cert Ed (eds.) |
1 |
| 85 |
 |
Fast Facts for the Neonatal Nurse A Nursing Orientation and Care Guide in a Nutshell |
Michele R. Davidson |
|
| 86 |
 |
Focus on Adult Health's Handbook of Laboratory Diagnostic Tests, 1E |
Leigh W. Moore |
1 |
| 87 |
 |
Focus on Nursing Pharmacology , Fifth Edition |
Amy M. Karch |
5 |
| 88 |
 |
Foundations of Maternal & Pediatric Nursing [3 ed.] |
Lois White, Gena Duncan, Wendy Baumle |
3 |
| 89 |
 |
Fundamentals of pharmacology An applied approach for nursing and health |
Alan GALBRAITH SHANE BULLOCK, ELIZABETH MANIAS, BARRY HUNT, ANN RICHARDS |
2nd |
| 90 |
 |
Handbook of Neurosurgery, Neurology, and Spinal Medicine for Nurses and Advanced Practice Health Professionals |
Michael Y. Wang, Andrea L. Strayer, Odette A. Harris, Cathy M. Rosenberg, Praveen V. Mummaneni (Editors) |
1 |
| 91 |
 |
Infection Prevention and Control at Neonatal Intensive Care Units |
|
|
| 92 |
 |
Innovations in Paediatric Ambulatory Care A Nursing Perspective |
Edward Alan Glasper, Susan Lowson (eds.) |
1 |
| 93 |
 |
Introduction to the Anatomy and Physiology of Children A guide for students of nursing, child care and health 2nd edition |
Janet MacGregor |
2 |
| 94 |
 |
Introductory Maternity and Pediatric Nursing, 2nd Edition |
N. Jayne Klossner, Nancy T. Hatfield |
2 |
| 95 |
 |
Introductory Medical-Surgical Nursing, 10th Edition (Lippincott's Practical Nursing) |
Barbara K. Timby, Nancy E. Smith |
10 |
| 96 |
 |
Introductory Clinical Pharmacology 7th ed |
Susan Beggs |
7th |
| 97 |
 |
Lab Notes Guide to Lab and Diagnostic Tests (2005) |
Tracey Hopkins |
|
| 98 |
 |
Laboratory Tests and Diagnostic Procedures with Nursing Diagnoses (8th Edition) |
Jane Vincent Corbett, Angela Denise Banks |
8 |
| 99 |
 |
Lehne's Pharmacology for Nursing Care |
Jacqueline Rosenjack Burchum, Laura D. Rosenthal |
10 |
| 100 |
 |
Lippincott Manual of Nursing Practice |
Sandra M. Nettina |
10 |
| 101 |
 |
Lippincott Manual of Nursing Practice Pocket Guide Maternal-Neonatal Nursing |
Elizabeth Jacqueline Mills, Amy Moshier |
|
| 102 |
 |
Lippincott Manual of Nursing Practice Pocket Guide Pediatric Nursing |
Naina D. Chohan, Julie Munden |
|
| 103 |
 |
Lippincott's Fast Facts for NCLEX-RN |
|
|
| 104 |
 |
Lippincott's Q&A Review for NCLEX-RN |
Diane M. Billings |
10 |
| 105 |
 |
Maternal and Infant Assessment for Breastfeeding and Human Lactation: A Guide for the Practitioner |
Cynthia Turner-Maffei, Barbara O'Connor, Anna Cadwell Blair, Lois D. W. Arnold, Elyse M. Blair |
2nd |
| 106 |
 |
Maternal, Neonatal, and Women's Health Nursing (Maternal, Neonatal, & Women's Health Nursing) |
Lynna Y. Littleton, Joan C. Engebretson |
|
| 107 |
 |
Maternal-Neonatal Facts Made Incredibly Quick! (Incredibly Easy! Series) |
|
2 |
| 108 |
 |
Maternal-Neonatal Nursing in a Flash |
Kimberly Attwood, Darlene Nebel Cantu, Cheryl Zauderer R |
|
| 109 |
 |
Maternal-neonatal nursing made incredibly easy! |
Stephanie C. Butkus |
3 |
| 110 |
 |
Maternity and Pediatric Nursing |
Susan Scott Ricci, Terri Kyle |
|
| 111 |
 |
Medical-Surgical Nursing Demystified, [Third ed.] |
Jim Keogh |
3 |
| 112 |
 |
Medical-Surgical Nursing Assessment and Management of Clinical Problems |
Sharon L. Lewis, Linda Bucher, Shannon Ruff Dirksen, Margaret McLean |
9 |
| 113 |
 |
Microbiology and Infection Control for Health Professionals |
GARY LEE AND PENNY BISHOP |
5 |
| 114 |
 |
Mosby's 2014 Nursing Drug Reference, 27e |
Linda Skidmore-Roth, RN, MSN, NP |
27th |
| 115 |
 |
Mosby's Pocket Guide to Pediatric Assessment |
Joyce K. Engel |
5th |
| 116 |
 |
Neonatal Certification Review for the CCRN and RNC High-Risk Examination |
Keri R. Rogelet, ANN J. Brorsen |
|
| 117 |
 |
Neonatal Nursing |
Doreen Crawford, Maryke Morris |
1 |
| 118 |
 |
Neonatal Nursing Care Handbook |
Carole kenner, Judy Wright lott |
2 |
| 119 |
 |
Nurse's Manual of Laboratory and Diagnostic Tests 4Ed |
Bonita Morrow Cavanaugh |
4 |
| 120 |
 |
Nurse's 5-minute clinical consult Diseases |
Julie M. Catagnus, Amy Moshier (Ediotrs) |
1 |
| 121 |
 |
Nursing Care in Pediatric Respiratory Disease |
Concettina Tolomeo |
1 |
| 122 |
 |
Nursing Care of the Pediatric Neurosurgery Patient |
Cathy C. Cartwright, Donna C. Wallace (Editors) |
3 |
| 123 |
 |
Nursing Diagnosis Handbook: An Evidence-Based Guide to Planning Care [Paperback ed.] |
Betty J. Ackley, Gail B. Ladwig, Mary Beth Flynn Makic |
11 |
| 124 |
 |
Nursing pharmacology made incredibly easy! [3rd edition] |
Lippincott Williams,Wilkins |
3 |
| 125 |
 |
Orthopaedic and Trauma Nursing An Evidence-based Approach to Musculoskeletal Care |
Sonya Clarke and Julie Santy-Tomlinson |
|
| 126 |
 |
Orthopedic and Sports Medicine Case Studies for Advanced Practice Nurses |
Karen M. Myrick |
|
| 127 |
 |
Overview of Down Syndrome ppt |
Donna Riedle RN, IPMG |
|
| 128 |
 |
Paediatric Advanced Life Support A Practical Guide for Nurses |
Philip Jevon |
2nd |
| 129 |
 |
Paediatric Intensive Care Nursing [1 ed.] |
Michaela Dixon, Doreen Crawford |
1 |
| 130 |
 |
Paediatric Neurosurgery for Nurses Evidence-based care for children and their families |
Joanna Smith and Catherine Martin |
|
| 131 |
 |
Paediatric Nursing in Australia Principles for Practice |
Jennifer Fraser, Donna Waters, Elizabeth Forster, Nicola Brown |
2nd |
| 132 |
 |
Paediatrics A Clinical Guide for Nurse Practitioners |
Katie Barnes |
1 |
| 133 |
 |
Pathophysiology (Copstead), 5E |
Lee-Ellen C. Copstead, Jacquelyn L. Banasik |
5th |
| 134 |
 |
Pathophysiology Concepts of Altered Health States |
Sheila C. Grossman, Carol Mattson Porth |
9 |
| 135 |
 |
Pathophysiology Made Incredibly Easy Lippincott 5th edition |
|
5th |
| 136 |
 |
Pathophysiology Made Incredibly Easy! (Incredibly Easy! Series), 4th Edition |
|
4th |
| 137 |
 |
Pediatric Nursing Demystified |
Joyce Y. Johnson, Jim Keogh |
|
| 138 |
 |
Pediatric Nursing Made Incredibly Easy |
Mikki Meadows-Oliver |
2nd |
| 139 |
 |
Pediatric Nursing Test Success An Unfolding Case Study Review |
Susan Parnell Scholtz, Vicki A. Martin, Frances H. Cornelius |
|
| 140 |
 |
Pediatric Nursing Caring for Children and Their Families |
Nicki. L.Potts, Barbara L. Mandleco |
3 |
| 141 |
 |
Pediatric Nursing Content Review PLUS Practice Questions |
MARGOT R. DE SEVO |
|
| 142 |
 |
Pediatric Oncology Nursing Advanced Clinical Handbook (Pediatric Oncology) |
Deborah Tomlinson, Nancy E. Kline |
|
| 143 |
 |
Pelvic Dysfunction in Men Diagnosis and Treatment of Male Incontinence and Erectile Dysfunction (Wiley Series in Nursing) |
|
|
| 144 |
 |
Perspectives in paediatric oncology nursing |
Faith Gibson, Louise Soanes, B Sepion |
1 |
| 145 |
 |
Pharmacology Clear and Simple A Guide to Drug Classifications and Dosage Calculations 2ed |
Cynthia J. Watkins |
2nd |
| 146 |
 |
Pharmacology Clear and Simple A Guide to Drug Classifications and Dosage Calculations |
Cynthia J. Watkins |
3rd |
| 147 |
 |
Pharmacology for Health Professionals |
Bronwen Bryant and Kathleen Knights |
4th |
| 148 |
 |
Pharmacology for Health Professionals Second Edition |
W. Renee Acosta |
2nd |
| 149 |
 |
Pharmacology for Nurses, A Pathophysiological Approach, 4th Edition |
Michael Adams, Leland Norman Holland, Carol Quam Urban |
4th |
| 150 |
 |
Pharmacology Mnemonics for the Family Nurse Practitioner |
Nachole Johnson |
|
| 151 |
 |
Pharmacology Success NCLEX-Style Q&A Review 3ed |
Colgrove Doherty |
3rd |
| 152 |
 |
Pharmacology Nursing Process 7thEdition |
Linda K. Bennington |
7th |
| 153 |
 |
Pharmacology: A Patient-Centered Nursing Process Approach [8 ed.] |
Linda E. McCuistion, Joyce LeFever Kee, Evelyn R. Hayes |
8 |
| 154 |
 |
Physical Assessment of the Newborn A Comprehensive Approach to the Art of Physical Examination |
Ellen P. Tappero, Mary Ellen Honeyfield, |
6 |
| 155 |
 |
Pressure Ulcer Prevention and Treatment Following Spinal Cord Injury |
Susan L. Garber, Andrea K. Biddle |
2 |
| 156 |
 |
Principles of Pediatric Nursing Caring for Children (7th Edition) |
Jane W. Ball, Ruth C. Bindler, Kay J. Cowen, Michele R. Shaw |
7 |
| 157 |
 |
Principles of Pediatric Nursing Caring for Children, 5th Edition |
Jane W. Ball, Ruth C. Bindler, Kay J. Cowen |
5th |
| 158 |
 |
Rheumatology Nursing |
Jackie Hill |
2 |
| 159 |
 |
Rheumatology nursing A creative approach |
Jackie Hill |
2 |
| 160 |
 |
Study Guide for Medical-Surgical Nursing: Assessment and Management of Clinical Problems, 9e [9 ed.] |
Sharon L. Lewis RN PhD FAAN, Shannon Ruff Dirksen RN PhD, Linda Bucher RN PhD CEN |
9 |
| 161 |
 |
Study Guide for Pharmacology and the Nursing Process |
Julie S. Snyder |
7 |
| 162 |
 |
Thesis - The Effect of an Osteoporosis Prevention Program on Knowledge and Self-Efficacy |
|
|
| 163 |
 |
Transformative Nursing in the NICU Trauma-Informed Age-Appropriate Care |
Mary E. Coughlin |
1 |
| 164 |
 |
Transition from Pediatric to Adult Healthcare Services for Adolescents and Young Adults with Long-term Conditions An International Perspective on Nurses' Roles and Interventions |
Cecily L. Betz, Imelda T. Coyne |
1 |
| 165 |
 |
Understanding Medical-Surgical Nursing 5ed |
Linda S. Williams, Paula D. Hopper |
5 |
| 166 |
 |
Winningham's Critical Thinking Cases in Nursing Medical-Surgical, Pediatric, Maternity, and Psychiatric, 5e |
Mariann Harding, Julie S. Snyder, Barbara A. Preusser |
5 |
| 167 |
 |
Evidence-Based Practice of Critical Care |
Clifford S. Deutschman, Patrick J. Neligan |
2 |
| 168 |
 |
Bates' Pocket Guide to Physical Examination and History Taking |
Lynn Bickley |
7 |
| 169 |
 |
Bates Guide to Physical Examination & History Taking |
Lynn S. Bickley |
12 |
| 170 |
 |
Student Laboratory Manual for Bates' Nursing Guide to Physical Examination and History Taking |
Jo Anne Kirk |
1 |
| 171 |
 |
Bates' Nursing Guide to Physical Examination and History Taking |
Beth Hogan-Quigley, Mary Louise Palm, Lynn S. Bickley |
11 |
| 172 |
 |
Emergency nursing : 5-tier triage protocols |
Julie K. Briggs, Valerie G. A. Grossman, |
|
| 173 |
 |
Emergency Triage |
Kevin Mackway-Jones, Janet Marsden, Jill Windle |
3 |
| 174 |
 |
Lewis's Medical-Surgical Nursing E-Book: Assessment and Management of Clinical Problems |
Mariann M. Harding |
11 |
| 175 |
 |
Wound Care Essentials: Practice Principles |
Author(s): Sharon Baranoski, Elizabeth A. Ayello |
|
| 176 |
 |
Clinical Companion for Medical-Surgical Nursing: Patient-Centered Collaborative Care, 8e [8 ed.] |
Chris Winkelman |
8 |
| 177 |
 |
Pediatric Nurse Practitioner Certification Review Guide: Primary Care, Fifth Edition [5 ed.] |
Joanne Silbert Flagg, Elizabeth Sloand |
5th |
| 178 |
 |
Venous Thromboembolism: A Nurse's Guide to Prevention and Management [1 ed.] |
Ellen Welch |
1 |
| 179 |
 |
Daviss Diseases & Disorders A Nursing Therapeutics Manual |
Marilyn Sawyer Sommers |
6 |
| 180 |
 |
Pharmacology for nurses [Second edition.] |
Blaine Templar Smith, Diane F. Pacitti |
2 |
| 181 |
 |
Claytons Basic Pharmacology for Nurses [18th Edition] |
Michelle Willihnganz, Samuel Gurevitz, Bruce Clayton |
18 |
| 182 |
 |
Focus on Nursing Pharmacology [8 ed.] |
Amy M. Karch |
8 |
| 183 |
 |
Mosbys Pharmacology Memory Notecards: Visual, Mnemonic, and Memory Aids for Nurses [Spiral-bound ed.] |
JoAnn Zerwekh |
|
| 184 |
 |
Basic Pharmacology for Nurses: E-Book |
illihnganz, Michelle;Clayton, Bruce D |
17th |
| 185 |
 |
Illustrated pharmacology for nurses |
Simonsen, Terje |
|
| 186 |
 |
Pharmacology : a 2-in-1 reference for nurses [1 ed.] |
Harold, Catherine; Priff, Nancy |
|
| 187 |
 |
Basic Pharmacology for Nurses [12th ed.] |
Bruce D. Clayton; Yvonne N. Stock |
12 |
| 188 |
 |
Adult Cardiac Surgery: Nursing Care and Management [1 ed.] |
Helen L. Inwood |
1 |
| 189 |
 |
Nursing Care and ECMO [1 ed.] |
Chirine Mossadegh, Alain Combes |
1 |
| 190 |
 |
Auscultation Skills: Breath & Heart Sounds [5 ed.] |
Jessica Shank Coviello |
5 |
| 191 |
 |
Breath Sounds Made Incredibly Easy! [1 ed.] |
Janice Hausauer, Nancy Haynes |
1 |
| 192 |
 |
Ward-based Critical Care A Guide for Health Professionals |
Ann M. Price, Sally A. Smith, Alistair Challiner |
2 |
| 193 |
 |
Acute Stroke Nursing [1 ed.] |
Jane Williams, Lin Perry, Caroline Watkins |
1 |
| 194 |
 |
Chest X-ray Interpretation for Radiographers, Nurses and Allied Health Professionals 1st Edition |
Karen Sakthivel-Wainford |
|
| 195 |
 |
Med-surg success : a Q & A review applying critical thinking to test taking [Third edition.] |
Kathryn Cadenhead Colgrove |
3 |
| 196 |
 |
Targeted Therapies in Lung Cancer: Management Strategies for Nurses and Practitioners |
Marianne Davies, Beth Eaby-Sandy |
|
| 197 |
 |
Caring For Patients With Mesothelioma Principle and Guidlines |
Mary Hesdorffer, Gleneara E. Bates-Pappas |
|
| 198 |
 |
Brunner & Suddarth's Textbook of Medical-Surgical Nursing 14th Edition [14 ed.] |
Janice L Hinkle, Kerry H. Cheever |
14 |
| 199 |
 |
Essential Pathophysiology For Nursing And Healthcare Students |
Ann Richards, Sharon Edwards |
1 |
| 200 |
 |
Mosbys Pharmacology Memory Notecards: Visual, Mnemonic, and Memory Aids for Nurses [Spiral-bound ed.] |
JoAnn Zerwekh |
|
| 201 |
 |
Introduction to Clinical Pharmacology - E-Book [9th ed.] |
Hosler, Shirley,Visovsky, Constance G.,Zambroski, Cheryl H |
9 |
| 202 |
 |
Gaharts 2019 Intravenous Medications: A Handbook for Nurses and Health Professionals [Spiral-bound ed.] |
Betty L Gahart, Adrienne R. Nazareno, Meghan Q. Ortega |
35 |
| 203 |
 |
Compact Clinical Guide to Mechanical Ventilation: Foundations of Practice for Critical Care Nurses [1st ed.] |
Sandra Goldsworthy, Leslie Graham |
|
| 204 |
 |
Renal nursing: care and management of people with kidney disease [Fifth edition] |
Nicola Thomas |
5 |
| 205 |
 |
AACN essentials of critical care nursing [Fourth ed.] |
Suzanne M. Burns, Sarah A. Delgado (Editors) |
4 |
| 206 |
 |
AACN essentials of progressive care nursing [Fourth ed.] |
Suzanne M. Burns, Sarah A. Delgado |
4 |
| 207 |
 |
Advanced Health Assessment and Diagnostic Reasoning [4th Edition] |
Jacqueline Rhoads, Sandra Wiggins Petersen |
4 |
| 208 |
 |
Surgical Instrumentation An Interactive Approach |
RENEE NEMITZ |
3 |
| 209 |
 |
Saunders Comprehensive Review for the Nclex-Pn Examination [7 ed.] |
Linda Anne Silvestri, Angela Elizabeth Silvestri |
7 |
| 210 |
 |
Lippincotts Q&A Review for NCLEX-RN [11, revised] |
Diane Billings, Desiree Hensel |
11 |
| 211 |
 |
Davis's Q&A for the NCLEX-RN Examination [1 ed.] |
Kathleen A. Ohman |
|
| 212 |
 |
Acute Cardiac Care: A Practical Guide for Nurses |
Angela Kucia, Tom Quinn |
|
| 213 |
 |
Fast Facts for the Cardiac Surgery Nurse: Caring for Cardiac Surgery Patients [3 ed.] |
Tanya Hodge |
3 |
| 214 |
 |
Cardiac Surgery Essentials for Critical Care Nursing (Hardin, Cardiac Surgery Essentials for Critical Care Nursing) [1 ed.] |
Sonya Hardin, Roberta Kaplow |
1 |
| 215 |
 |
PHARMACOTHERAPEUTICS FOR ADVANCED PRACTICE NURSE PRESCRIBERS |
Teri Moser Woo, Marylou V. Robinson |
4 |
| 216 |
 |
Nurse to nurse. ECG interpretation |
Peggy Jenkins |
|
| 217 |
 |
E-Z ECG rhythm interpretation [1 ed.] |
Henry B. Geiter |
|
| 218 |
 |
Lippincott Manual of Nursing Practice Series: ECG Interpretation [1 ed.] |
Jennifer Lynn Kowalak,Carol Turkington |
|
| 219 |
 |
LPN Expert Guides: ECG Interpretation [1 ed.] |
Louise Quinn |
|
| 220 |
 |
ECG interpretation : a 2-in-1 reference for nurses [1 ed.] |
Springhouse |
|
| 221 |
 |
Electrocardiography for healthcare professionals [4th edition] |
Kathryn A. Booth, Thomas O’Brien |
4 |
| 222 |
 |
Manual of I.V. Therapeutics: Evidence-Based Practice for Infusion Therapy [6 ed.] |
Lynn D. Phillips ,Lisa Gorski |
6 |
| 223 |
 |
Manual of I.V. Therapeutics: Evidence-Based Practice for Infusion Therapy [7 ed.] |
Lisa A Gorski |
7 |
| 224 |
 |
Daviss Diseases and Disorders: A Nursing Therapeutics Manual [6th Edition] |
Marilyn Sawyer Sommers |
6 |
| 225 |
 |
Chest X-ray Interpretation for Radiographers, Nurses and Allied Health Professionals |
Karen Sakthivel-Wainford |
|
| 226 |
 |
Cardiac Electrophysiology 2: An Advanced Visual Guide for Nurses, Techs, and Fellows [1 ed.] |
Paul D. Purves, George J. Klein, Lorne J. Gula, Peter Leong-Sit, Jaimie Manlucu, Allan C. Skanes, Raymond Yee |
|
| 227 |
 |
Emergency and Trauma Care for Nurses and Paramedics [2nd Edition] |
Kate Curtis, Clair Ramsden |
2 |
| 228 |
 |
Transformative Nursing in the NICU: Trauma-Informed Age-Appropriate Care [Paperback ed.] |
Mary E. Coughlin |
|
| 229 |
 |
Nurse to nurse: trauma care |
Donna Nayduch |
|
| 230 |
 |
Aesthetic Procedures: Nurse Practitioner's Guide to Cosmetic Dermatology [1st ed. 2020] |
Beth Haney |
|
| 231 |
 |
the NURSE PRACTITIONER IN UROLOGY a manual for nurse practitioners, physician. [2 ed.] |
Susanne A. Quallich, Michelle J. Lajiness (Editors) |
2 |
| 232 |
 |
Management of Fecal Incontinence for the Advanced Practice Nurse [1st ed.] |
Donna Z. Bliss |
|
| 233 |
 |
2018 Nurses Drug Handbook [17th ed.] |
Jones And Bartlett |
17 |
| 234 |
 |
EKGs for the Nurse Practitioner and Physician Assistant [2 ed.] |
Maureen Knechtel |
2 |
| 235 |
 |
Pharmacology Mnemonics for the Family Nurse Practitioner |
Nachole Johnson |
|
| 236 |
 |
Lehnes Pharmacotherapeutics for Nurse Practitioners and Physician Assistants |
Laura Rosenthal; Jacqueline Burchum |
|
| 237 |
 |
Nurse Anesthesia [6th Edition] |
John J. Nagelhout, Sass Elisha |
6 |
| 238 |
 |
Guidelines for Nurse Practitioners in Ambulatory Obstetric Settings [2nd ed.] |
Nancy J. Cibulka, Mary Lee Barron |
2 |
| 239 |
 |
Trauma Certified Registered Nurse (Tcrn) Examination Review: Think in Questions, Learn by Rationales [Paperback ed.] |
Kendra Menzies Kent |
|
| 240 |
 |
Nurse Practitioner Certification Examination and Practice Preparation [Paperback ed.] |
Margaret A. Fitzgerald |
5 |
| 241 |
 |
Adult-Gerontology Nurse Practitioner Certification Intensive Review: Fast Facts and Practice Questions (Book + Free App) [Third edition] |
Maria T. Codina Leik |
3 |
| 242 |
 |
Chemistry and physics for nurse anesthesia : a student-centered approach [Third edition.] |
David Shubert, Sharon Niemann, John Leyba |
3 |
| 243 |
 |
Adult-Gerontology and Family Nurse Practitioner |
Elizabeth V August, Conrad Fischer, Craig Sorkin |
|
| 244 |
 |
The Nurse Practitioner in Urology [1 ed.] |
Michelle Lajiness, Susanne Quallich (Editors) |
1 |
| 245 |
 |
Nurse Educator's Guide to Best Teaching Practice: A Case-Based Approach [1 ed.] |
Keeley C. Harmon, Joe Ann Clark, Jeffery M. Dyck, Vicki Moran |
|
| 246 |
 |
Guidelines for nurse practitioners in gynecologic settings |
Joellen W. Hawkins, Diane M. Roberto-Nichols, J. Lynn Stanley-Haney |
11 |
| 247 |
 |
Cases in diagnostic reasoning : acute & critical care nurse practitioner |
Suzanne M. Burns, Sarah A. Delgado |
|
| 248 |
 |
The Advanced Practice Nurse Cardiovascular Clinician |
Kelley M. Anderson |
|
| 249 |
 |
Fast Facts for the New Nurse Practitioner [2nd edition] |
Nadine M. Aktan |
2 |
| 250 |
 |
Trauma Care: Initial Assessment and Management in the Emergency Department (Essential Clinical Skills for Nurses) |
Cole E.(ed.) |
|
| 251 |
 |
Mastering Pharmacogenomics: A Nurses Handbook for Success [1 ed.] |
Dale Halsey Lea, Dennis J. Cheek, Daniel Brazeau, Gayle Brazeau |
|
| 252 |
 |
Pharmacology Case Studies for Nurse Prescribers |
Donna Scholefield, Alan Sebti, Alison Harris |
|
| 253 |
 |
Fast Facts for the Neonatal Nurse: A Nursing Orientation and Care Guide in a Nutshell [1 ed.] |
Michele R. Davidson |
|
| 254 |
 |
Dermatology for the Advanced Practice Nurse [1 ed.] |
Faye Lyons, Lisa Ousley |
|
| 255 |
 |
The Gerontology Nurse's Guide to the Community-Based Health Network [1 ed.] |
Brenda L. Bonham Howe |
|
| 256 |
 |
To Comfort Always: A Nurse's Guide to End-Of-Life Care [2 ed.] |
Linda Norlander |
2 |
| 257 |
 |
The Nurse Mentor'S Handbook: Supporting Students In Clinical Practice [2nd ed] |
Danny Walsh |
2 |
| 258 |
 |
Differential Diagnosis for the Advanced Practice Nurse [Paperback ed.] |
Marilee Murphy Jensen, Jacqueline Rhoads |
|
| 259 |
 |
Pearson Nurses Drug Guide 2015 |
Billie Ann Wilson, Margaret T. Shannon, Kelly M. Shields |
|
| 260 |
 |
Fast Facts for the Antepartum and Postpartum Nurse: A Nursing Orientation and Care Guide in a Nutshell [1 ed.] |
Michele R. Davidson |
|
| 261 |
 |
The student nurse toolkit : an essential guide for surviving your course |
Ian Peate |
1 |
| 262 |
 |
McGraw-Hill nurse's drug handbook [Seventh edition] |
Patricia Dwyer Schull |
7 |
| 263 |
 |
NANDA nursing diagnoses: definitions & classification 2018-2020 [Eleventh edition] |
T. Heather Herdman, Shigemi Kamitsuru (Editors) |
11 |
| 264 |
 |
The Nurse Practitioner's Guide to Nutrition [2 ed.] |
Lisa Hark, Kathleen Ashton, Darwin Deen |
2 |
| 265 |
 |
Mosby's dictionary of medicine, nursing & health professions [10 ed.] |
Company, C V Mosby Publishing |
10 |
| 266 |
 |
Henkes Med-Math Dosage Calculation, Preparation & Administration |
Susan Buchholz |
9th |
| 267 |
 |
Introducing Pharmacology For Nursing and Healthcare |
Roger McFadden |
3rd |
| 268 |
 |
Rapid infection control nursing (Rapid series) |
Shona Ross, Sarah Furrows |
1 |
| 269 |
 |
Oxford Handbook of Clinical Skills in Adult Nursing |
Jacqueline Randle, Frank Coffey, Martyn Bradbury |
1 |
| 270 |
 |
Mosby's Pharmacology Memory NoteCards 5ed |
Zerwekh |
5th |
| 271 |
 |
McGraw-Hill Education TEAS Review [3 ed.] |
Cara Cantarella, Wendy Hanks |
3 |
| 272 |
 |
Cardiac Diagnosis for Acute Care: The NPs and PAs Guide to a Comprehensive History and Deciphering the Differential [1st ed.] |
Leslie E. Janik |
|
| 273 |
 |
Laboratory and Diagnostic Tests with Nursing Implications |
Joyce LeFever Kee |
9 |
| 274 |
 |
Wound care essentials 5th ed 2020 |
Sharon Baranoski, Elizabeth A. Ayello |
5 |
| 275 |
 |
Clinical Application of Urologic Catheters, Devices and Products |
Diane K. Newman, Eric S. Rovner, Alan J. Wein |
|
| 276 |
 |
Schuster A Clinical Judgment Approach to Patient Care FIFTH EDITION |
Pamela McHugh Schuste |
5 |
| 277 |
 |
Small Animal Dermatology for Technicians and Nurses [Reprint ed.] |
Kim Horne (editor), Marcia Schwassmann (editor), Dawn Logas (editor) |
|
| 278 |
 |
All-in-One Nursing Care Planning Resource: Medical-Surgical, Pediatric, Maternity, and Psychiatric-Mental Health [4th ed.] |
Pamela L. Swearingen |
4 |
| 279 |
 |
Pediatric Nursing and Health Care |
Teklebrhan Tema, Tsegaye Asres |
|
| 280 |
 |
A Manual of Oral and Maxillofacial Surgery for Nurses [1 ed.] |
Colin Yates |
1 |
| 281 |
 |
ESC Textbook of Cardiovascular Nursing (The European Society of Cardiology Series) |
Catriona Jennings (editor), Felicity Astin (editor), Donna Fitzsimons (editor), Ekaterini Lambrinou (editor), Lis Neubeck (editor), David R Thompson (editor) |
|
| 282 |
 |
LAST MINUTE HISTOLOGY: Quick Review Of Histology And Cell biology For Medical And Nursing Students (1st edition) [1 ed.] |
Sivajith P R |
1 |
| 283 |
 |
Practical Cardiology for Veterinary Nurses |
Charlotte Pace |
|
| 284 |
 |
Nursing Care of the Pediatric Neurosurgery Patient [1st Edition.] |
Cathy Cartwright, Donna C. Wallace |
1 |
| 285 |
 |
Nursing Care of the Pediatric Neurosurgery Patient [2 ed.] |
Jennifer A. Disabato DNP, CPNP-PC, AC (auth.), Cathy C. Cartwright, Donna C. Wallace (eds.) |
2 |
| 286 |
 |
Nursing Care of the Pediatric Neurosurgery Patient [18 ed.] |
Jennifer A. Disabato MS, RN, CPNP (auth.), Cathy C. Cartwright RN, MSN, PCNS, Donna C. Wallace RN, MS, CPNP (eds.) |
18 |
| 287 |
 |
CNN Exam Flashcard Study System: CNN Test Practice Questions & Review for the Certified Nephrology Nurse Exam |
Mometrix Nursing Certification Test Team |
|
| 288 |
 |
Fundamentals of intravitreal injections : a guide for ophthalmic nurse practitioners and allied health professionals [2 edition.] |
Jonathan C. Park, Salman Waqar |
2 |
| 289 |
 |
Fundamentals Of Intravitreal Injections: A Guide For Ophthalmic Nurse Practitioners And Allied Health Professionals |
Waqar Salman, Park Jonathan C |
|
| 290 |
 |
Ophthalmic nursing [5 edition] |
Lee, Agnes, Shaw, Mary E |
5 |
| 291 |
 |
The Spinal Cord Injured Patient, 2nd Edition [1 ed.] |
Bok Y. Lee, Lee E. Ostrander |
1 |
| 292 |
 |
A Nurse’s Survival Guide to the Ward [Updated 3rd Edition] |
Ann Richards, Sharon Edwards |
3 |
| 293 |
 |
The Ophthalmic Study Guide: For Nurses and Health Professionals [2 ed.] |
Dorothy Field, Marina Forbes |
2 |
| 294 |
 |
The Care and Management of Spinal Cord Injuries [1 ed.] |
George M. Bedbrook Kt., O.B.E., O.ST.J. Hon. M.D. (W.A.), M.S.(Melb.), D.P.R.M. (Syd.), F.R.C.S., F.R.A.C.S. (auth.) |
1 |
| 295 |
 |
Patient and Person: Interpersonal Skills in Nursing |
Jane Stein-Parbury |
|
| 296 |
 |
Tabbner's Nursing Care: Theory and Practice [6 ed.] |
Gabby Koutoukidis, Kate Stainton, Jodie Hughson |
6 |
| 297 |
 |
Using Evidence to Guide Nursing Practice [2nd ed.] |
Mary Courtney, Helen McCutcheon |
2 |
| 298 |
 |
Sedation and sleep in critical care |
Jan Foster, Suzanne S Prevost |
|
| 299 |
 |
Sleep Disorders and Sleep Promotion in Nursing Practice [1 ed.] |
Nancy Redeker, Geoffry Phillips McEnany |
1 |
| 300 |
 |
Occupational Health Nurses and Respiratory Protection: Improving Education and Training: Letter Report [1 ed.] |
Institute of Medicine, Board on Health Sciences Policy, Committee on the Respiratory Protection Curriculum for Occupational Health Nursing Programs, Catharyn T. Liverman, Andrea M. Schultz, M. E. Bonnie Rogers, Linda Hawes Clever |
1 |
| 301 |
 |
AACN Essentials of Progressive Care Nursing [5 ed.] |
Sarah A. Delgado |
5 |
| 302 |
 |
Adult-Gerontology Practice Guidelines [Team IRA] [3 ed.] |
Jill C. Cash MSN APN FNP-BC (editor), Cheryl A. Glass MSN APRN WHNP-BC (editor) |
3 |
| 303 |
 |
Compassion Fatigue and Burnout in Nursing: Enhancing Professional Quality of Life [3 ed.] |
Vidette Todaro-Franceschi |
3 |
| 304 |
 |
Alexander’s Care of the Patient in Surgery [15th Edition] |
Jane C. Rothrock |
15 |
| 305 |
 |
Alexander’s Care of the Patient in Surgery [16 ed.] |
Jane C. Rothrock |
16 |
| 306 |
 |
Alexander's Care of the Patient in Surgery [14 ed.] |
Jane C. Rothrock |
14 |
| 307 |
 |
Anxiety Management in Adult Day Surgery: A Nursing Perspective [1 ed.] |
Mark Mitchell |
1 |
| 308 |
 |
Day Surgery: Contemporary Approaches to Nursing Care (Wiley Series in Nursing) [1 ed.] |
Fiona Timmins, Catherine McCabe |
1 |
| 309 |
 |
Minor Veterinary Surgery: A Handbook for Veterinary Nurses [1 ed.] |
Julian G. Hoad BVetMed BSc(Hons) MRCVS |
1 |
| 310 |
 |
Plastic and Reconstructive Surgery, An Issue of Perioperative Nursing Clinics, 1e [1 ed.] |
Debbie Hickman Mathis |
1 |
| 311 |
 |
Robotic Surgery and Nursing |
Gongxian Wang, Yu Zeng, Xia Sheng |
|
| 312 |
 |
Transdisciplinary Perioperative Care in Colorectal Surgery: An Integrative Approach [1 ed.] |
Kok-Yang Tan (eds.) |
1 |
| 313 |
 |
Guide for Advanced Nursing Care of the Adult with Congenital Heart Disease |
Serena Francesca Flocco, Hajar Habibi, Federica Dellafiore, Christina Sillman |
|
| 314 |
 |
Valvular Heart Disease: A Guide for Cardiovascular Nurses and Allied Health Professionals [1st ed. 2022] |
Marian C. Hawkey (editor), Sandra B. Lauck (editor) |
1 |
| 315 |
 |
Congenital Heart Disease: The Nursing Care Handbook [1st ed.] |
Serena Francesca Flocco, Angelo Lillo, Federica Dellafiore, Eva Goossens |
1 |
| 316 |
 |
Nursing by Heart: Transformational Self-Care for Nurses |
Julie Skinner |
|
| 317 |
 |
Electronic Fetal Heart Rate Monitoring: The 5-Tier System |
Julian T Parer, Tekoa L. King, Tomaki Ikeda |
|
| 318 |
 |
Financial Management for Nurse Managers: Merging the Heart with the Dollar |
John Michael Leger (editor), Janne Dunham-Taylor (editor) |
|
| 319 |
 |
Opening my heart: a journey from nurse to patient and back again |
Shalof, Tilda |
|
| 320 |
 |
The Heart's Truth : Essays on the Art of Nursing |
Cortney Davis, Martin Kohn, Carol C. Donley |
|
| 321 |
 |
Auscultation Skills: Breath & Heart Sounds, 4th Edition |
Lippincott |
4 |
| 322 |
 |
Caring for the Heart Failure Patient: A Textbook for the Healthcare Professional |
Stewart, Simon |
|
| 323 |
 |
Improving Outcomes in Chronic Heart Failure: A Practical Guide to Specialist Nurse Intervention |
Simon Stewart, Lynda Blue |
|
| 324 |
 |
Emotional Labour in Health Care : The Unmanaged Heart of Nursing (Critical Studies in Health and Society) |
Cath Theodosius |
|
| 325 |
 |
Heart and Soul. The Story of Florence Nightingale |
Gena K. Gorrell |
|
| 326 |
 |
Heart Failure: A Clinical Nursing Handbook (Wiley Series in Nursing) |
Christopher Nicholson |
|
| 327 |
 |
Heart Failure: Providing Optimal Care (American Heart Association Monograph Series) |
Mariell Jessup, Kathleen M. McCauley |
|
| 328 |
 |
Issues in Heart Failure Nursing |
Chris Jones |
8 |
| 329 |
 |
Neonatal Resuscitation Textbook |
Association, American Heart, Pediatrics, American Academy of |
|
| 330 |
 |
Bachelor of Science in Nursing (B.Sc.N) |
IGNOU |
|
| 331 |
 |
Certificate in Community Health (BPCCHN) |
IGNOU |
|
| 332 |
 |
Certificate in Maternal and Child Health Nursing (CMCHN) (Part 1) |
IGNOU |
|
| 333 |
 |
Certificate in Maternal and Child Health Nursing (CMCHN) (Part 6) |
IGNOU |
|
| 334 |
 |
Certificate in Newborn and Infant Nursing (CNIN) |
IGNOU |
|
| 335 |
 |
Diploma in Nursing Administration(DNA) |
IGNOU |
|
| 336 |
 |
Clara Barton: In the Service of Humanity |
David H Burton |
|
| 337 |
 |
Yoga for Nurses |
Ingrid Kollak PhD RN |
|
| 338 |
 |
Importing Care, Faithful Service: Filipino and Indian American Nurses at a Veterans Hospital |
Stephen M. Cherry |
|
| 339 |
 |
American Indian Health and Nursing |
Margaret P. Moss |
|
| 340 |
 |
મુખ્ય સેવિકા book mukhya sevika |
મુખ્ય સેવિકા book mukhya sevika |
|
| 341 |
 |
Text atlas of wound management [2nd ed.] |
Vincent Falanga, Jaymie Panuncialman |
2 |
| 342 |
 |
Moving with the Times: Gender, Status and Migration of Nurses in India |
Sreelekha Nair |
|
| 343 |
 |
Nursing and Empire: Gendered Labor and Migration from India to the United States |
Sujani K. Reddy |
|
| 344 |
 |
Nursing Research and Statistics |
Nursing Research Society Of India |
|
| 345 |
 |
Renal Nursing: a Guide to Practice |
Bobbee Terrill |
|
| 346 |
 |
Renal Nursing |
Nicola Thomas |
4 |
| 347 |
 |
Oxford Handbook of Renal Nursing |
Althea Mahon, Karen Jenkins, Lisa Burnapp |
|
| 348 |
 |
Advanced renal care |
Nicola Thomas |
|
| 349 |
 |
Renal Nursing: A Practical Approach |
Bobbee Terrill |
|
| 350 |
 |
Bacteriology for Nurses |
Geoffrey A. Taylor (Auth.) |
|
| 351 |
 |
Medicine Management Skills for Nurses |
Claire Boyd |
|
| 352 |
 |
Clinical Rotation Manual for the Acute Care Nurse Practitioner Student |
Nichole Miller |
|
| 353 |
 |
Acute Care Nursing: Recognising and Responding to Medical Emergencies |
Ian Pete, Helen Dutton |
|
| 354 |
 |
Huszar’s Basic Dysrhythmias and Acute Coronary Syndromes: Interpretation and Management Text & Pocket Guide Package - E-Book |
Keith Wesley |
|
| 355 |
 |
Acute and Chronic Wounds: Current Management Concepts |
Ruth Bryant, Denise Nix |
5 |
| 356 |
 |
Lippincott Certification Review: Pediatric Acute Care Nurse Practitioner |
Andrea M. Kline, Catherine Haut |
|
| 357 |
 |
Acute Care for Elders: A Model for Interdisciplinary Care |
Michael L. Malone, Elizabeth A. Capezuti, Robert M. Palmer (eds.) |
|
| 358 |
 |
Initial Management of Acute Medical Patients: A Guide for Nurses and Healthcare Practitioners |
Ian Wood, Michelle Garner |
|
| 359 |
 |
LeMone and Burke's Adult Nursing: Acute and Ongoing Care |
Priscilla LeMone, Mr Ian Peate, Murilitharan Nair, Laureen Hemming, Karen Wild |
|
| 360 |
 |
Clinical Wisdom and Interventions in Acute and Critical Care: A Thinking-in-Action Approach, 2nd Edition |
Patricia Benner, Patricia Kyriakids &, Daphne Stannard |
2 |
| 361 |
 |
Compact Clinical Guide to Acute Pain Management : An Evidence-Based Approach for Nurses |
Yvonne D'Arcy, FAANP CNS APN-C MS Yvonne D'Arcy |
|
| 362 |
 |
Acute Care Nurse Practitioner Certification Study Question Book, Second Edition |
Sally K. Miller |
2 |
| 363 |
 |
A Summary of the October 2009 Forum on the Future of Nursing : Acute Care |
Institute of Medicine, at the Institute of Medicine Committee on the Robert Wood Johnson Foundation Initiative on the Future of Nursing |
|
| 364 |
 |
Cancer in Children and Young People: Acute Nursing Care |
Faith Gibson, Louise Soanes |
|
| 365 |
 |
Acute Medicine A Handbook for Nurse Practitioners |
Lisa Carroll |
|
| 366 |
 |
Essential Guide to Acute Care |
Nicola Cooper, Kirsty Forrest, Paul Cramp |
2 |
| 367 |
 |
Acute Mental Health Nursing: From Acute Concerns to the Capable Practitioner |
Marc Harrison, Damian Mitchell, David Howard |
|
| 368 |
 |
Principles of Nursing in Kidney Care: Under the Auspices of EDTNAERCA and EKPF |
Afra Masià-Plana, Anastasia Liossatou |
|
| 369 |
 |
Kidney Transplantation: A Guide to the Care of Kidney Transplant Recipients |
Dianne B. McKay (auth.), Dianne B. McKay, Steven M. Steinberg (eds.) |
|
| 370 |
 |
Nursing the Highly Dependent Child Or Infant: A Manual of Care |
Michaela Dixon |
|
| 371 |
 |
Primary Care of the Premature Infant, 1e |
Dara Brodsky MD, Mary Ann Ouellette MS APRN IBCLC |
|
| 372 |
 |
Maternal Infant Nursing Care Plans |
Karla, Rnc, Msn, Luxner |
|
| 373 |
 |
Child and Infant Pain: Principles of Nursing Care and Management |
Bernadette Carter (auth.) |
|
| 374 |
 |
A textbook of community nursing |
Chilton, Sue |
|
| 375 |
 |
Adult nursing : preparing for practice [1 ed.] |
Barton, Dave, Le May, Andrée |
1 |
| 376 |
 |
Children and young people's nursing : principles for practice |
Davies, Ruth, Davies, Alyson |
|
| 377 |
 |
Competencies for Advanced Nursing Practice [1 ed.] |
Sue Hinchliff, Rosemary Rogers |
1 |
| 378 |
 |
Nursing Practice and Health Care 5E: A Foundation Text |
Sue Hinchliff, Sue Norman, Jane Schober |
5 |
| 379 |
 |
Patients' Rights, Law and Ethics for Nurses: A practical guide |
Buka, Paul |
2 |
| 380 |
 |
Student nurses' guide to professional practice and development |
Schober, Jane E., Ash, Carol |
|
| 381 |
 |
Compression and Chronic Wound Management [1st ed.] |
Raj Mani, Kittipan Rerkasem, Harikrishna K.R. Nair, Vijay Shukla |
1 |
| 382 |
 |
Chronic Illness Care: Principles and Practice |
Timothy P. Daaleman, Margaret R. Helton |
|
| 383 |
 |
Chronic Illness: Impact And Intervention [8 ed.] |
Pamala D. Larsen, Ilene Morof Lubkin |
8 |
| 384 |
 |
What Nurses Know...Chronic Fatigue Syndrome |
Lorraine Steefel |
|
| 385 |
 |
Translating Chronic Illness Research into Practice |
Debbie Kralik, Barbara Paterson, Vivien Coates |
|
| 386 |
 |
Guided Care: A New Nurse-Physician Partnership in Chronic Care [1 ed.] |
Dr. Jean Giddens PhD RN, Ms. Katherine Frey MPH, Ms. Lisa Reider MHS, Ms. Tracy Novak MHS |
1 |
| 387 |
 |
Self Management of Chronic Disease: Alzheimer's Disease [1 ed.] |
Sabine Bährer-Kohler |
1 |
| 388 |
 |
Managing Long-term Conditions and Chronic Illness in Primary Care: A Guide to Good Practice [1 ed.] |
Judith Carrier |
1 |
| 389 |
 |
Nursing Care of Children and Young People with Chronic Illness [1 ed.] |
Fay Valentine, Lesley Lowes |
1 |
| 390 |
 |
Managing Chronic Obstructive Pulmonary Disease [1 ed.] |
Laura Blackler, Christine Jones, Caroline Mooney |
1 |
| 391 |
 |
Chronic Cardiac Care: A Practical Guide to Specialist Nurse Management [1 ed.] |
Simon Stewart, Sally Inglis, Anna Hawkes |
1 |
| 392 |
 |
Managing Chronic Disorders |
Springhouse |
|
| 393 |
 |
Teaching Nursing Care of Chronic Illness: A Storied Approach to Whole Person Care (Springer Series on the Teaching of Nursing) [1 ed.] |
Pamela Minden RN PhD CS, Colleen Gullickson RN PhD APNP BC |
1 |
| 394 |
 |
The Holistic Nursing Approach to Chronic Disease [1 ed.] |
Carolyn Chambers Clark EdD ARNP FAAN |
1 |
| 395 |
 |
American Holistic Nurses' Association Guide to Common Chronic Conditions: Self-Care Options to Complement Your Doctor's Advice [1 ed.] |
Carolyn Chambers Clark |
1 |
| 396 |
 |
Chronic Illness in Children : An Evidence-Based Approach [1 ed.] |
Laura L. Hayman, Margaret M. Mahon, J. Rick Turner |
1 |
| 397 |
 |
Annual Review of Nursing Research, Volume 18, 2000: Focus on Chronic Illness [1 ed.] |
Joyce J. Fitzpatrick, Jean Goeppinger |
1 |
| 398 |
 |
Inflammatory Bowel Disease Nursing Manual [1st ed.] |
Andreas Sturm, Lydia White |
1 |
| 399 |
 |
Coeliac Disease: Nursing Care and Management (Wiley Series in Nursing) [1 ed.] |
Helen Griffiths |
1 |
| 400 |
 |
Handbook of Pathophysiology: Foundations of Health & Disease [3th edition] |
Corwin E .J. |
3 |
| 401 |
 |
Comprehensive Nursing Care for Parkinson's Disease [1 ed.] |
Lisette K. Bunting-Perry, Gwyn M. Vernon |
1 |
| 402 |
 |
Infection Management for Geriatrics in Long-Term Care Facilities, 2nd edition (Infectious Disease and Therapy) [2 ed.] |
Thomas T. Yoshikawa, Joseph G. Ouslander |
2 |
| 403 |
 |
Vascular Disease: A Handbook for Nurses [1st ed.] |
Haytham Al-Khaffaf, Sharon Dorgan |
1 |
| 404 |
 |
Study Guide for The Human Body in Health and Disease [6th ed.] |
Linda Swisher |
6 |
| 405 |
 |
The Art and Science of Personalising Care with Older People with Diabetes |
Trisha Dunning |
|
| 406 |
 |
Care of People with Diabetes: A Manual of Nursing Practice |
Trisha Dunning |
|
| 407 |
 |
Diabetes education: art, science and evidence |
Trisha Dunning (editor) |
|
| 408 |
 |
Diabetes Mellitus: A Practical Handbook |
Sue K. Milchovich RN BSN CDE, Barbara Dunn-Long RD |
10 |
| 409 |
 |
What Nurses Know ... Diabetes |
Rita Girouard Mertig |
|
| 410 |
 |
Educating Your Patient with Diabetes |
Katie Weinger EdD, RN, Ashley Leighton BA (auth.), Katie Weinger, Catherine A. Carver (eds.) |
|
| 411 |
 |
Care of People with Diabetes: A Manual of Nursing Practice Third Edition |
Trisha Dunning |
3 |
| 412 |
 |
Care of People with Diabetes: A Manual of Nursing Practice, 2nd edition |
Trisha Dunning |
2 |
| 413 |
 |
Using Insulin Pumps in Diabetes: A Guide for Nurses and Other Health Professionals |
Jill Rodgers(auth.) |
|
| 414 |
 |
The Nurse's Guide To Teaching Diabetes Self-Management |
Rita Girouard Mertig |
|
| 415 |
 |
Handbook of Diabetes Management |
Donna Zazworsky, Jane Nelson Bolin, Vicki Gaubeca |
|
| 416 |
 |
Nursing Care of Older People with Diabetes |
Trisha Dunning |
|
| 417 |
 |
Get Set for Nursing |
Graeme Smith |
|
| 418 |
 |
In the Company of Nurses: The History of the British Army Nursing Service in the Great War |
Yvonne McEwen |
|
| 419 |
 |
Pressure Ulcers in the Aging Population: A Guide for Clinicians [1 ed.] |
Gregory A. Compton M.D., C.M.D. (auth.), David R. Thomas, MD, Gregory A. Compton, MD (eds.) |
1 |
| 420 |
 |
Fundamentals Of Intravitreal Injections: A Guide For Ophthalmic Nurse Practitioners And Allied Health Professionals |
Jonathan C Park, Michael D Cole, Salman Waqar |
|
| 421 |
 |
NANDA International Nursing Diagnoses: Definitions and Classification 2021-2023 [12th Edition] |
T. Heather Herdman, Shigemi Kamitsuru, Camila Takáo Lopes |
12 |
| 422 |
 |
Handbook of Neuroscience Nursing : Care of the Adult Neurosurgical Patient [1 ed.] |
Denita Ryan |
1 |
| 423 |
 |
Comprehensive Tracheostomy Care: The National Tracheostomy Safety Project Manual [1 ed.] |
Brendan McGrath |
1 |
| 424 |
 |
The Gale Encyclopedia of Nursing and Allied Health [1st ed.] |
Kristine M. Krapp |
1 |
| 425 |
 |
Interpersonal Relations in Nursing: A Conceptual Frame of Reference for Psychodynamic Nursing |
Hildegard E. Peplau RN, BA, MA, EdD (auth.) |
|
| 426 |
 |
The midwife's labour and birth handbook [Fourth edition] |
Chapman, Vicky, Charles, Cathy |
4 |
| 427 |
 |
Making Sense of Fluids and Electrolytes |
Adeleye, Abisola,Milovanovic, Zoja |
|
| 428 |
 |
Maternal-newborn nursing : the critical components of nursing care [Second edition.] |
Roberta F. Durham, Linda Chapman |
2 |
| 429 |
 |
Maternal-Newborn Nursing: The Critical Components of Nursing Care [1 ed.] |
Linda Chapman, Roberta F., RN, Ph.D. Durham |
1 |
| 430 |
 |
The Survival Nurse : Running an Emergency Nursing Station under Adverse Conditions |
Ragnar Benson |
|
| 431 |
 |
Mosby's Pocket Dictionary of Medicine, Nursing & Health Professions [9 ed.] |
Marie T. O’Toole |
9 |
| 432 |
 |
Mosby's 2024 Nursing Drug Reference (Skidmore Nursing Drug Reference) (by Team-IRA) [37 ed.] |
Linda Skidmore-Roth RN MSN NP |
37 |
| 433 |
 |
Mosby's Drug Guide for Nursing Students with Update - E-Book |
Linda Skidmore-Roth |
|
| 434 |
 |
Mosby's Drug Guide For Nursing Students [14 ed.] |
Linda Skidmore-Roth |
14 |
| 435 |
 |
Mosby's 2023 Nursing Drug Reference [36 ed.] |
Linda Skidmore-Roth |
36 |
| 436 |
 |
Pharmacology and the Nursing Process [10 ed.] |
Linda Lane Lilley RN PhD, Shelly Rainforth Collins PharmD, Julie S. Snyder MSN RN-BC |
10 |
| 437 |
 |
Mosby's 2021 Nursing Drug Reference [34 ed.] |
Skidmore Linda |
34 |
| 438 |
 |
Brown and Mulholland’s Drug Calculations: Ratio and Proportion Problems for Clinical Practice [12 ed.] |
Ann Tritak-Elmiger EdD RN, Margaret Daingerfield EdD RN CNE |
12 |
| 439 |
 |
Clayton's Basic Pharmacology for Nurses [19 ed.] |
Michelle J. Willihnganz, Samuel L. Gurevitz, Bruce D. Clayton |
19 |
| 440 |
 |
Workbook and Competency Evaluation Review for Mosby's Textbook for Nursing Assistants [10 ed.] |
Sheila A. Sorrentino, Leighann Remmert, Relda T. Kelly |
10 |
| 441 |
 |
Mosby's Textbook for Nursing Assistants - Soft Cover Version [10 ed.] |
Sheila A. Sorrentino PhD RN, Leighann Remmert MS RN |
10 |
| 442 |
 |
Lilley's Pharmacology for Canadian Health Care Practice [4 ed.] |
Kara Sealock RN EdD MEd CNCC (C) CCNE, Cydnee Seneviratne RN BScN MN PhD, Linda Lane Lilley RN PhD |
4 |
| 443 |
 |
Foundations and Adult Health Nursing E-Book [Eighth edition] |
Cooper, Kim D.,Gosnell, Kelly |
8 |
| 444 |
 |
Clayton’s Basic Pharmacology for Nurses [18th Edition] |
Michelle Willihnganz, Samuel Gurevitz, Bruce Clayton |
18 |
| 445 |
 |
Study Guide for Lewis's Medical-Surgical Nursing: Assessment and Management of Clinical Problems [11 ed.] |
Harding Kwong Roberts Hagler Reinisch |
11 |
| 446 |
 |
Fundamentals of Nursing: Active Learning for Collaborative Practice |
Barbara L. Yoost, Lynne R. Crawford |
|
| 447 |
 |
Nutritional Foundations and Clinical Applications: A Nursing Approach [7 ed.] |
Michele Grodner EdD CHES, Sylvia Escott-Stump MA RD LDN, Suzanne Dorner MSN RN CCRN |
7 |
| 448 |
 |
Nursing Interventions Classification NIC [Unknown Binding ed.] |
Gloria M. Bulechek, Howard K. Butcher, Joanne McCloskey Dochterman, Cheryl M. Wagner |
|
| 449 |
 |
Prioritization, Delegation, and Assignment: Practice Exercises for the NCLEX Examination [Paperback ed.] |
Linda A. LaCharity |
4 |
| 450 |
 |
Mosby’s Pharmacology Memory Notecards: Visual, Mnemonic, and Memory Aids for Nurses [Spiral-bound ed.] |
JoAnn Zerwekh |
|
| 451 |
 |
Leading and Managing in Nursing [Paperback ed.] |
Patricia S. Yoder-Wise |
|
| 452 |
 |
Mosby’s 2019 Nursing Drug Reference E-Book [32nd ed.] |
Linda Skidmore-Roth |
32 |
| 453 |
 |
Evidence-Based Practice for Nursing and Healthcare Quality Improvement [1 ed.] |
Geri LoBiondo-Wood, Judith Haber, Marita G. Titler |
1 |
| 454 |
 |
Mosby's Textbook for Long-Term Care Nursing Assistants: E-Book |
Kostelnick, Clare |
|
| 455 |
 |
Gerontologic Nursing: E-Book [6th ed] |
Meiner, Sue E.,Yeager, Jennifer J |
6 |
| 456 |
 |
Foundations for Population Health in Community/Public Health Nursing, 5e [5 ed.] |
Marcia Stanhope RN DSN FAAN, Jeanette Lancaster RN PhD FAAN |
5 |
| 457 |
 |
Wong's Nursing Care of Infants and Children [11 ed.] |
Marilyn J. Hockenberry PhD RN PPCNP-BC FAAN, David Wilson MS RN C (NIC) |
11 |
| 458 |
 |
Nursing Research: Methods and Critical Appraisal for Evidence-Based Practice [Paperback ed.] |
Geri Lobiondo-Wood, Judith Haber |
|
| 459 |
 |
Mosby’s 2018 Nursing Drug Reference [Paperback ed.] |
Linda Skidmore-Roth |
|
| 460 |
 |
LPN to RN Transitions [Paperback ed.] |
Lora Claywell |
|
| 461 |
 |
Calculate with Confidence [Paperback ed.] |
Deborah Gray Morris |
|
| 462 |
 |
Mosby's 2017 nursing drug reference [30th edition] |
Skidmore-Roth, Linda |
30 |
| 463 |
 |
Maternal Child Nursing Care [6 ed.] |
Shannon E. Perry, Marilyn J. Hockenberry, Deitra Leonard Lowdermilk, David Wilson, Kathryn Rhodes Alden, Mary Catherine Cashion |
6 |
| 464 |
 |
Calculation of Drug Dosages: A Work Text, 10e [Tenth edition] |
Sheila J. Ogden RN MSN, Linda K Fluharty RN MSN |
10 |
| 465 |
 |
Mosby's Medical Dictionary - E-Book: Mosby's Medical Dictionary - E-Book |
coll. |
9 |
| 466 |
 |
Study Guide for Medical-Surgical Nursing: Assessment and Management of Clinical Problems [Paperback ed.] |
Sharon L. Lewis, Shannon Ruff Dirksen, Linda Bucher |
|
| 467 |
 |
Contemporary Nursing: Issues, Trends, & Management [Paperback ed.] |
Barbara Cherry, Susan R. Jacob |
7 |
| 468 |
 |
Mosby’s Textbook for Nursing Assistants - Soft Cover Version [Paperback ed.] |
Sheila A. Sorrentino, Leighann Remmert |
|
| 469 |
 |
Health Assessment for Nursing Practice [Paperback ed.] |
Susan F. Wilson, Jean Foret Giddens |
|
| 470 |
 |
Wong’s Essentials of Pediatric Nursing [Paperback ed.] |
Marilyn J. Hockenberry, Cheryl C. Rodgers, David M. Wilson |
|
| 471 |
 |
Mosby's Textbook for Nursing Assistants: E-Book [Ninth edition] |
Remmert, Leighann N.,Sorrentino, Sheila A |
9 |
| 472 |
 |
Mosby’s Pocket Dictionary of Medicine, Nursing & Health Professions [8th Edition] |
Mosby, Marie T. O’Toole |
8 |
| 473 |
 |
Maternity and Women’s Health Care [Paperback ed.] |
Deitra Leonard Lowdermilk, Shannon E. Perry, Mary Catherine Cashion, Kathryn Rhodes Alden |
|
| 474 |
 |
Public Health Nursing: Population-Centered Health Care in the Community [Paperback ed.] |
Marcia Stanhope, Jeanette Lancaster |
|
| 475 |
 |
Conceptual Foundations: The Bridge to Professional Nursing Practice [6 ed.] |
Elizabeth E. Friberg |
6 |
| 476 |
 |
Priorities in Critical Care Nursing [Paperback ed.] |
Linda D. Urden, Kathleen M. Stacy, Mary E. Lough |
|
| 477 |
 |
The nurse, the math, the meds : drug calculations using dimensional analysis [Third edition.] |
Mulholland, Joyce M., Turner, Susan J. |
3 |
| 478 |
 |
Basic Geriatric Nursing [6 ed.] |
Patricia A. Williams RN MSN CCRN |
6 |
| 479 |
 |
Review of Hemodialysis for Nurses and Dialysis Personnel [9 ed.] |
Judith Kallenbach |
9 |
| 480 |
 |
Mosby's 2013 Nursing Drug Reference [26th ed] |
Skidmore-Roth, Linda |
26 |
| 481 |
 |
Mosby's Drug Guide for Nursing Students [11 ed.] |
Linda Skidmore-Roth RN MSN NP |
11 |
| 482 |
 |
Mosby's Pocket Guide to Nursing Skills & Procedures [8 ed.] |
Anne Griffin Perry, Patricia A. Potter |
8 |
| 483 |
 |
Contemporary Nursing: Issues, Trends, and Management [6th ed.] |
Barbara Cherry, Susan R. Jacob |
6 |
| 484 |
 |
Clinical Cases: Fundamentals of Nursing Case Studies [1st ed.] |
Natashia Scully, Damian Wilson |
1 |
| 485 |
 |
Wong’s Nursing Care of Infants and Children [10th ed.] |
Marilyn J. Hockenberry, David Wilson |
10 |
| 486 |
 |
Gerontologic Nursing [5 ed.] |
Sue E. Meiner |
5 |
| 487 |
 |
Mosby's comprehensive review of practical nursing for the NCLEX-PN examination [Seventeenth edition. /] |
Eyles, Mary O |
17 |
| 488 |
 |
Mosby's nursing drug reference [27th ed] |
Skidmore-Roth, Linda |
27 |
| 489 |
 |
Mosby's Pocketbook of Mental Health [2 ed.] |
Eimear Muir-Cochrane, Patricia Barkway, Debra Nizette |
2 |
| 490 |
 |
Nursing Diagnosis Handbook: An Evidence-Based Guide to Planning Care, 10e [10 ed.] |
Betty J. Ackley MSN EdS RN, Gail B. Ladwig MSN RN |
10 |
| 491 |
 |
2014 Intravenous Medications: A Handbook for Nurses and Health Professionals, 30e [30 ed.] |
Betty L. Gahart RN, Adrienne R. Nazareno PharmD |
30 |
| 492 |
 |
Nursing Theorists and Their Work, 8e [8 ed.] |
Martha Raile Alligood PhD RN ANEF |
8 |
| 493 |
 |
Nursing Care Plans: Diagnoses, Interventions, and Outcomes, 8e [8 ed.] |
Meg Gulanick PhD APRN FAAN, Judith L. Myers RN MSN |
8 |
| 494 |
 |
Fundamentals of nursing [Eighth edition] |
Patricia Ann Potter, Anne Griffin Perry, Patricia A Stockert, Amy Hall |
8 |
| 495 |
 |
Ebersole and Hess’ Gerontological Nursing & Healthy Aging [4 ed.] |
Theris A. Touhy, Kathleen F Jett |
4 |
| 496 |
 |
Calculate with Confidence, 6e [6 ed.] |
Deborah C. Gray Morris RN BSN MA LNC |
6 |
| 497 |
 |
Maternal Child Nursing Care [5th ed.] |
Shannon E. Perry, Marilyn J. Hockenberry, Deitra Leonard Lowdermilk, David Wilson |
5 |
| 498 |
 |
Study Guide for Maternal Child Nursing Care [5th ed.] |
Shannon E. Perry, Marilyn J. Hockenberry, Deitra Leonard Lowdermilk, David Wilson |
5 |
| 499 |
 |
Mosby’s Essentials for Nursing Assistants [5 ed.] |
Sheila A. Sorrentino, Leighann Remmert |
5 |
| 500 |
 |
2013 Mosby's nursing drug reference [26th ed] |
Skidmore-Roth, Linda |
26 |
| 501 |
 |
Mosby’s Drug Guide for Nursing Students [With 2014 Update] [10th Edition] |
Linda Skidmore-Roth |
10 |
| 502 |
 |
Study Guide for Basic Pharmacology for Nurses [16 ed.] |
Bruce D. Clayton, Michelle Willihnganz |
16 |
| 503 |
 |
Mosby's Comprehensive Review of Nursing for the NCLEX-RN® Examination [20 ed.] |
Patricia M. Nugent |
20 |
| 504 |
 |
Mosby's Guide to Nursing Diagnosis--E-Book [4 ed.] |
Gail B. Ladwig |
4 |
| 505 |
 |
Clinical Companion for Fundamentals of Nursing: Just the Facts, 8e [8 ed.] |
Patricia A. Potter RN MSN PhD FAAN, Anne Griffin Perry RN EdD FAAN, Patricia Stockert RN BSN MS PhD, Amy Hall RN BSN MS PhD CNE, Veronica Peterson BA RN BSN MS |
8 |
| 506 |
 |
Study Guide for Fundamentals of Nursing, 8e [8 ed.] |
Patricia A. Potter RN MSN PhD FAAN, Anne Griffin Perry RN EdD FAAN, Patricia Stockert RN BSN MS PhD, Amy Hall RN BSN MS PhD CNE, Geralyn Ochs RN ACNP-BC ANP-BC |
8 |
| 507 |
 |
Health Assessment for Nursing Practice [5 ed.] |
Susan F. Wilson, Jean Foret Giddens |
5 |
| 508 |
 |
Nursing Interventions Classification [6th ed.] |
Gloria M. Bulechek, Howard K. Butcher, Joanne M. McCloskey Dochterman, Cheryl Wagner |
6 |
| 509 |
 |
Mosby’s Pharmacology Memory NoteCards - E-Book: Visual, Mnemonic, and Memory Aids for Nurses [3 ed.] |
JoAnn Zerwekh, Jo Carol Claborn, Tom Gaglione |
3 |
| 510 |
 |
Mosby's 2014 Nursing Drug Reference - E-Book |
Linda Skidmore-Roth |
7 |
| 511 |
 |
Mosby's 2012 Nursing Drug Reference [25 ed.] |
Linda Skidmore-Roth MSN, NP |
25 |
| 512 |
 |
ACCCN's Critical Care Nursing - E-Book |
Doug Elliott |
|
| 513 |
 |
Nutritional Foundations and Clinical Applications: A Nursing Approach [5th Edition] |
Michele Grodner, Sara Long Roth, Bonnie C. Walkingshaw |
5 |
| 514 |
 |
Swearingen's Manual of Medical Surgical Nursing: A Care Planning Resource [7 ed.] |
Frances D. Monahan, Marianne Neighbors, Carol J. Green |
7 |
| 515 |
 |
Essential communication skills for nursing and midwifery [2nd ed] |
Philippa Sully, Joan Dallas |
2 |
| 516 |
 |
Workbook and Competency Evaluation Review for Mosby's Textbook for Long-Term Care Nursing Assistants, 6e [6 ed.] |
Sheila A. Sorrentino PhD RN |
6 |
| 517 |
 |
Breastfeeding: A Guide for the Medical Profession [6th ed.] |
Ruth A. Lawrence, Robert Lawrence |
6 |
| 518 |
 |
Mosby's Comprehensive Review of Nursing [9 ed.] |
Dolores F. Saxton |
9 |
| 519 |
 |
Medical-Surgical Nursing in Canada [4 ed.] |
Sharon L. Lewis, Shannon Ruff Dirksen, Margaret M. Heitkemper, Linda Bucher |
4 |
| 520 |
 |
Saunders Nursing Drug Handbook 2024 (by Team-IRA) |
Robert J. Kizior,Keith Hodgson,, KEITH J. HODGSON, RN, BSN, CCRN |
|
| 521 |
 |
Saunders Comprehensive Review for the NCLEX-RN® Examination [9 ed.] |
Linda Anne Silvestri PhD RN FAAN, Angela Elizabeth Silvestri PhD APRN FNP-BC CNE |
9 |
| 522 |
 |
Saunders Nursing Drug Handbook 2023 |
Keith J. Hodgson, Robert J. Kizior |
|
| 523 |
 |
Saunders 2022-2023 Clinical Judgment and Test-Taking Strategies [7 ed.] |
Linda Anne Silvestri, Angela Elizabeth Silvestri, Eileen H. Gray |
7 |
| 524 |
 |
Saunders Nursing Drug Handbook 2021 [1 ed.] |
Robert J. Kizior, Keith Hodgson |
1 |
| 525 |
 |
Saunders 2020-2021 Strategies for Test Success: Passing Nursing School and the NCLEX Exam [6 ed.] |
Linda Anne Silvestri PhD RN FAAN, Angela Elizabeth Silvestri PhD APRN FNP-BC CNE |
6 |
| 526 |
 |
Saunders 2020-2021 Strategies for Test Success - E-Book: Saunders 2020-2021 Strategies for Test Success - E-Book |
Linda and Angela Silvestri |
|
| 527 |
 |
Saunders Q&A Review for the NCLEX-RN Examination [8 ed.] |
Linda Anne Silvestri , Angela E. Silvestri |
8 |
| 528 |
 |
Varcarolis' Foundations of Psychiatric-Mental Health Nursing: A Clinical Approach [9 ed.] |
Margaret Jordan Halter |
9 |
| 529 |
 |
Policy & Politics in Nursing and Health Care [8 ed.] |
Diana J. Mason, Elizabeth Lynne Dickson, (Gloria) Adriana Perez, Monica R. McLemore |
8 |
| 530 |
 |
Lehne’s Pharmacotherapeutics for Advanced Practice Nurses and Physician Assistants [2nd Edition] |
Laura D. Rosenthal, Jacqueline Rosenjack Burchum |
2 |
| 531 |
 |
Pharmacology: A Patient-Centered Nursing Process Approach [10 ed.] |
Linda E. McCuistion |
10 |
| 532 |
 |
Saunders Comprehensive Review for the NCLEX-RN® Examination, 8e [8 ed.] |
Linda Anne Silvestri PhD RN FAAN, Angela Elizabeth Silvestri PhD APRNFNP-BC CNE |
8 |
| 533 |
 |
Core Curriculum for Oncology Nursing [6 ed.] |
ONS, Jeannine Brant PhD APRN AOCN FAAN (editor) |
6 |
| 534 |
 |
Saunders Nursing Drug Handbook 2019 E-Book |
Hodgson, Barbara B.,Kizior, Robert J |
|
| 535 |
 |
Study Guide for Foundations of Maternal-Newborn and Women’s Health Nursingg [7th ed.] |
Sharon Murray, Emily McKinney, Karen Holub, Renee Jones |
7 |
| 536 |
 |
Study Guide for Introduction to Maternity and Pediatric Nursing [Paperback ed.] |
Gloria Leifer |
|
| 537 |
 |
Introduction to Maternity and Pediatric Nursing [Paperback ed.] |
Gloria Leifer |
|
| 538 |
 |
Foundations of Maternal-Newborn and Women’s Health Nursing [Paperback ed.] |
Sharon Smith Murray |
|
| 539 |
 |
Understanding Nursing Research: Building an Evidence-Based Practice [Paperback ed.] |
Susan K. Grove, Jennifer R Gray |
|
| 540 |
 |
Community/Public Health Nursing: Promoting the Health of Populations [Paperback ed.] |
Mary A. Nies, Melanie McEwen |
|
| 541 |
 |
Physical Examination and Health Assessment |
Carolyn Jarvis |
7 |
| 542 |
 |
Physical Examination and Health Assessment - Canadian Edition, 3e |
Carolyn Jarvis |
3 |
| 543 |
 |
Pediatric Primary Care |
Catherine E. Burns et al. |
|
| 544 |
 |
Pediatric Primary Care [6th ed.] |
Catherine E. Burns et al. |
6 |
| 545 |
 |
Lehne's Pharmacotherapeutics for Advanced Practice Providers |
Laura Rosenthal, Jacqueline Burchum |
|
| 546 |
 |
Saunders 2018-2019 Strategies for Test Success: Passing Nursing School and the NCLEX Exam [Paperback ed.] |
Linda Anne Silvestri, Angela Silvestri |
|
| 547 |
 |
Dewit's fundamental concepts and skills for nursing [5th ed] |
Williams, Paul |
5 |
| 548 |
 |
Study Guide for Dewit’s Fundamental Concepts and Skills for Nursing [Paperback ed.] |
Patricia A. Williams |
|
| 549 |
 |
Saunders Q & A Review for the Nclex-Rn® Examination [Paperback ed.] |
Linda Anne Silvestri, Angela Silvestri |
|
| 550 |
 |
Varcarolis’ Foundations of Psychiatric-Mental Health Nursing: A Clinical Approach [8 ed.] |
Margaret Jordan Halter |
8 |
| 551 |
 |
Pharmacology: A Patient-Centered Nursing Process Approach [9 ed.] |
Linda E. McCuistion, Jennifer J. Yeager, Mary Beth Winton, Kathleen Dimaggio |
9 |
| 552 |
 |
Medical-Surgical Nursing: Concepts for Interprofessional Collaborative Care, Single Volume [Hardcover ed.] |
Donna D. Ignatavicius, M. Linda Workman, Cherie Rebar |
|
| 553 |
 |
Drain’s Perianesthesia Nursing: A Critical Care Approach [7th Edition] |
Jan Odom-Forren |
7 |
| 554 |
 |
Saunders Nursing Drug Handbook 2019 E-Book: Saunders Nursing Drug Handbook 2019 E-Book |
Kizior, Robert J.,Hodgson, Barbara B.,Keith J. Hodgson |
|
| 555 |
 |
Medical-Surgical Nursing: Concepts for Interprofessional Collaborative Care [9 ed.] |
Donna D. Ignatavicius, M. Linda Workman, Cherie Rebar |
9 |
| 556 |
 |
Professional Nursing: Concepts & Challenges [Paperback ed.] |
Beth Perry Black |
8 |
| 557 |
 |
Saunders nursing drug handbook. 2017 |
Hodgson, Barbara B.,Hodgson, Keith J.,Kizior, Robert J.,Witmer, James B |
|
| 558 |
 |
Medical-Surgical Nursing: Concepts & Practice [Paperback ed.] |
Susan C. deWit, Holly Stromberg, Carol Dallred |
|
| 559 |
 |
Saunders Nursing Drug Handbook 2016, 1e [1 ed.] |
Robert J. Kizior BS RPh, Barbara B. Hodgson RN OCN |
1 |
| 560 |
 |
Lehne’s Pharmacology for Nursing Care [9th ed.] |
Jacqueline Burchum, Laura Rosenthal |
9 |
| 561 |
 |
Teaching in Nursing: A Guide for Faculty |
Diane M. Billings, Judith A. Halstead |
|
| 562 |
 |
Policy & Politics in Nursing and Health Care [Paperback ed.] |
Diana J. Mason, Judith K. Leavitt, Mary W. Chaffee |
|
| 563 |
 |
Study Guide for Pharmacology: A Patient-Centered Nursing Process Approach [8 ed.] |
Linda E. McCuistion, Joyce LeFever Kee, Evelyn R. Hayes |
8 |
| 564 |
 |
Saunders Comprehensive Review for the NCLEX-RN Examination [6 ed.] |
Linda Anne Silvestri |
6 |
| 565 |
 |
Professional Nursing: Concepts & Challenges, 7e [7 ed.] |
Beth Black RN MSN PhD |
7 |
| 566 |
 |
Saunders Nursing Drug Handbook 2014 |
Barbara B. Hodgson RN OCN, Robert J. Kizior BS RPh |
|
| 567 |
 |
Foundations of Maternal-Newborn and Women's Health Nursing [6th ed.] |
Sharon Smith Murray, Emily Slone McKinney |
6 |
| 568 |
 |
Study Guide for Foundations of Maternal-Newborn and Women's Health Nursing, 6e [6 ed.] |
Sharon Smith Murray MSN RN C, Emily Slone McKinney MSN RN C |
6 |
| 569 |
 |
Varcarolis' Foundations of Psychiatric Mental Health Nursing: A Clinical Approach [7th ed.] |
Margaret Jordan Halter |
7 |
| 570 |
 |
Strategies, Techniques, & Approaches to Critical Thinking: A Clinical Reasoning Workbook for Nurses, 5e [5 ed.] |
Sandra Luz Martinez de Castillo EdD RN |
5 |
| 571 |
 |
Interpersonal Relationships: Professional Communication Skills for Nurses [6 ed.] |
Elizabeth Arnold, Kathleen Underman Boggs |
6 |
| 572 |
 |
Study Guide for The Human Body in Health and Illness [5th Edition] |
Barbara Herlihy |
5 |
| 573 |
 |
Maternal-Child Nursing [4 ed.] |
Emily Slone McKinney, MSN, RN, C, Susan R. James, PhD, MSN, RN, Sharon Smith Murray, MSN, RN, C, Kristine Nelson, RN, MN, Jean Ashwill, MSN, RN |
4 |
| 574 |
 |
Saunders Q & a Review Cards for the NCLEX-RN® Exam--E-Book [2 ed.] |
Linda Anne Silvestri |
2 |
| 575 |
 |
Medical-Surgical Nursing: Patient-Centered Collaborative Care, Single Volume, 7e [7 ed.] |
Donna D. Ignatavicius MS RN ANEF, M. Linda Workman PhD RN FAAN |
7 |
| 576 |
 |
Pharmacology for Nursing Care [8th ed.] |
Richard A. Lehne |
8 |
| 577 |
 |
The Practice of Nursing Research: Appraisal, Synthesis, and Generation of Evidence [7 ed.] |
Susan K. Grove, Nancy Burns, Jennifer R. Gray |
7 |
| 578 |
 |
Jarvis's physical examination & health assessment: pocket companion [Australian and New Zealand ed] |
Cole, Clare,Hill, Olivia,Saunders, Rosemary |
|
| 579 |
 |
AACN Procedure Manual for Critical Care |
Debra J. Lynn-McHale Wiegand |
|
| 580 |
 |
Introduction to Critical Care Nursing6: Introduction to Critical Care Nursing |
Mary Lou Sole, Deborah Goldenberg Klein, Marthe J. Moseley |
6 |
| 581 |
 |
Policy & Politics in Nursing and Health Care [Sixth Edition] |
Diana J. Mason, Judith K. Leavitt, Mary W. Chaffee |
6 |
| 582 |
 |
Saunders Comprehensive Review for the NCLEX-RN Examination [5 ed.] |
Linda Anne Silvestri |
5 |
| 583 |
 |
Community Health Care Nursing, 4th edition [4 ed.] |
David Sines, Mary Saunders, Janice Forbes-Burford |
4 |
| 584 |
 |
Pharmacology for Nursing Care, 7th Edition (PART 1) [7th ed.] |
Richard A. Lehne |
7 |
| 585 |
 |
Pharmacology for Nursing Care, 7th Edition (PART 2) [7th ed.] |
Richard A. Lehne |
7 |
| 586 |
 |
Pharmacology for Nursing Care [7th ed.] |
R. Lehne |
7 |
| 587 |
 |
Handbook of Nurse Anesthesia [4 ed.] |
John J. Nagelhout, Karen Plaus |
4 |
| 588 |
 |
Critical Care and Emergency Nursing |
Lori Schumacher, Cynthia C. Chernecky |
|
| 589 |
 |
AACN Certification and Core Review for High Acuity and Critical Care |
Elsevier Health Sciences |
|
| 590 |
 |
Saunders 2014-2015 Strategies for Test Success - Pageburst E-Book on VitalSource,Passing Nursing School and the NCLEX Exam,3: Saunders 2014-2015 Strategies for Test Success - Pageburst E-Book on VitalSource |
Linda Anne Silvestri, PhD RN Faan, Angela Silvestri, Msn RN |
|
| 591 |
 |
Dictionary of Nursing: Over 11,000 Terms Clearly Defined |
A&,C Black |
2 |
| 592 |
 |
Faces of Civil War Nurses |
Ronald S. Coddington |
|
| 593 |
 |
The backwash of war: an extraordinary American nurse in World War I |
La Motte, Ellen Newbold,Wachtell, Cynthia |
8 |
| 594 |
 |
Infiltrating Healthcare: How Marketing Works Underground to Influence Nurses |
Quinn Grundy |
|
| 595 |
 |
No Place Like Home: A History of Nursing and Home Care in the United States |
Dr. Karen Buhler-Wilkerson RN PhD FAAN |
|
| 596 |
 |
What Nurses Know ... Menopause [1 ed.] |
Karen Roush |
1 |
| 597 |
 |
Nursing Practice in Multiple Sclerosis: A Core Curriculum |
Kathleen Costello, June Halper, Colleen Harris |
|
| 598 |
 |
Fundamentals of Anatomy and Physiology: For Nursing and Healthcare Students: An Essential Guide for Nursing and Healthcare Students [2 ed.] |
Ian Peate (editor), Muralitharan Nair (editor) |
2 |
| 599 |
 |
Neuroscience nursing: evidence-based practice |
Mestecky, Ann-Marie,Woodward, Woodward Susan Janet |
|
| 600 |
 |
Mixed methods research for nursing and the health sciences |
Sharon Andrew, Elizabeth Halcomb |
|
| 601 |
 |
Evidence-based clinical practice in nursing and health care : assimilating research, experience and expertise |
Alan Pearson, SRN., John Field, RPN., Zoe Jordan |
|
| 602 |
 |
Ophthalmic Nursing [3rd ed] |
Rosalind Stollery, Mary E. Shaw, Agnes Lee |
3 |
| 603 |
 |
Practice Nurse Handbook 4th Edition [4 ed.] |
Gillian D. Hampson |
4 |
| 604 |
 |
Health Assessment and Physical Examination [4 ed.] |
Pauline Calleja, Karen Theobald, Theresa Harvey |
4 |
| 605 |
 |
Fundamentals of Nursing [3rd Australia and New Zealand ed.] |
Joanne Tollefson, Sue C. DeLaune, Patricia K. Ladner, Lauren McTier, |
3 |
| 606 |
 |
Essential Clinical Skills: Enrolled Nurses [5 ed.] |
Joanne Tollefson, Gayle Watson, Eugenie Jelly, Karen Tambree |
5 |
| 607 |
 |
Mental Health Nursing Enhanced Edition [1 ed.] |
Gylo (Julie) Hercelinskyj, Louise Alexander PhD |
1 |
| 608 |
 |
Dosage Calculations (Jan 1, 2021)_(0176912266)_(Nelson Cengage Adapted) |
Gloria D. Pickar, Amy Pickar Abernethy, Beth Swart, Myrna Davis, Janet O'Connell |
5 |
| 609 |
 |
Clinical Psychomotor Skills: Assessment Tools for Nurses, 5-point Bondy Assessment Scale |
Joanne Tollefson |
7 |
| 610 |
 |
Ethics and Issues in Contemporary Nursing [4 ed.] |
Margaret A. Burkhardt, Alvita Nathaniel |
4 |
| 611 |
 |
Dosage Calculations [9th ed.] |
Gloria D. Pickar, Amy Pickar-Abernethy |
9 |
| 612 |
 |
Medical Surgical Nursing: An Integrated Approach [3 ed.] |
Lois White, Gena Duncan, Wendy Baumle |
3 |
| 613 |
 |
Clinical psychomotor skills : assessment skills for nurses [5th ed.] |
Joanne Tollefson |
5 |
| 614 |
 |
Fundamentals of Nursing: Standards & Practice, 4th Edition [4th ed.] |
Sue C. DeLaune, Patricia Kelly Ladner |
4 |
| 615 |
 |
Medical-surgical Nursing |
Gina M. Ankner, Patricia M. Ahlschlager, Tammy J. Hale |
2 |
| 616 |
 |
Foundations of basic nursing [3rd ed] |
Lois White, Gena Duncan, Wendy Baumle |
3 |
| 617 |
 |
NCLEX-PN Review (Delmar's Nclex-Pn Review) [2 ed.] |
Judith C. Miller |
2 |
| 618 |
 |
Nursing Delegation, Setting Priorities, and Making Patient Care Assignments , Second Edition [2 ed.] |
Patricia Kelly, Maureen T Marthaler |
2 |
| 619 |
 |
Practice Questions for NCLEX-PN (Delmar's Practice Questions for Nclex-Pn) [2 ed.] |
Judith C. Miller |
2 |
| 620 |
 |
Handbook of Fluid, Electrolyte and Acid-Base Imbalances [3 ed.] |
Joyce LeFever Kee, Betty J. Paulanka, Carolee Polek |
3 |
| 621 |
 |
Fundamentals of Anatomy and Physiology for Student Nurses |
Donald C Rizzo |
3 |
| 622 |
 |
Nursing Assistant: A Nursing Process Approach - Basics [1 ed.] |
Barbara Hegner, Barbara Acello, Esther Caldwell |
1 |
| 623 |
 |
Fluids and Electrolytes with Clinical Applications [8 ed.] |
Joyce LeFever Kee, Betty J. Paulanka, Carolee Polek |
8 |
| 624 |
 |
Public Health Nursing: Policy, Politics and Practice [1 ed.] |
L. Louise Ivanov, Carolyn L. Blue |
1 |
| 625 |
 |
Complete Review for NCLEX-RN (Test Preparation) [1 ed.] |
Donna F. Gauwitz |
1 |
| 626 |
 |
Nursing Process Concepts and Application [2 ed.] |
Wanda Walker Seaback |
2 |
| 627 |
 |
Health Assessment & Physical Examination [1 ed.] |
Mary Ellen Zator Estes |
1 |
| 628 |
 |
Dosage Calculations: A Ratio-Proportion Approach [4 ed.] |
Gloria D. Pickar, Amy Pickar Abernethy |
4 |
| 629 |
 |
Nursing Informatics: Where Technology and Caring Meet [4 ed.] |
Marion J. Ball, Judith V. Douglas, Patricia Hinton Walker, Donna DuLong (auth.), Marion J. Ball, Kathryn J. Hannah, Donna DuLong, Susan K. Newbold, Joyce E. Sensmeier, Diane J. Skiba, Michelle R. Troseth, Brian Gugerty, Patricia Hinton Walker, Judith V. Douglas (eds.) |
4 |
| 630 |
 |
Philosophy of Nursing: A New Vision for Health Care [1 ed.] |
Janice M. Brencick, Glenn A. Webster |
1 |
| 631 |
 |
Science and Practice of Pressure Ulcer Management [1 ed.] |
Theo Dassen RN, PhD, Antje Tannen RN, MA (auth.), Marco Romanelli MD, PhD, Michael Clark PhD, George Cherry D.Phil (Oxon), Denis Colin MD, PhD, Tom Defloor RN, PhD (eds.) |
1 |
| 632 |
 |
Telenursing [1 ed.] |
Sajeesh Kumar (auth.), Sajeesh Kumar, Helen Snooks (eds.) |
1 |
| 633 |
 |
Chest Pain: Advanced Assessment and Management Skills [1 ed.] |
John Albarran, Jenny Tagney |
1 |
| 634 |
 |
Rapid adult nursing |
Le May, Andrée |
|
| 635 |
 |
Advanced cardiac life support: a guide for nurses [2 ed.] |
Philip Jevon |
2 |
| 636 |
 |
Basic guide to dental sedation nursing [Second edition] |
Rogers, Nicola |
2 |
| 637 |
 |
Basic Guide to Orthodontic Dental Nursing [2 ed.] |
Fiona Grist |
2 |
| 638 |
 |
Calculation Skills for Nurses [1st ed.] |
Boyd, Claire |
1 |
| 639 |
 |
Calculation skills for nurses: Student Survival Skills |
Boyd, Claire |
|
| 640 |
 |
Cancer Nursing : Care in Context [2 ed.] |
Jessica Corner, Christopher D. Bailey |
2 |
| 641 |
 |
Care of the dying and deceased patient: a practical guide for nurses [1 ed.] |
Philip Jevon |
1 |
| 642 |
 |
Care Planning in Children and Young People's Nursing [1 ed.] |
Doris Corkin, Lorna Liggett, Sonia Clarke |
1 |
| 643 |
 |
Caring for Older People in Australia: Principles for Nursing Practice, 2nd Edition |
Amanda Johnson, Esther Chang |
2 |
| 644 |
 |
CliffsTestPrep Nursing School Entrance Exam |
Fred N Grayson,Tracy Halward, PhD,Sharon Shirley, MA,Mark Weinfeld, MA |
|
| 645 |
 |
Educating Nurses |
Sutphen, Molly, Benner, Patricia, Leonard, Victoria,Shulman, Lee S.,Leonard, Victoria,Sutphen, Molly,Benner, Patricia |
|
| 646 |
 |
Enabling learning in nursing and midwifery practice : a guide for mentors |
Sue West, Tim Clark, Melanie Jasper |
|
| 647 |
 |
Get into UK Nursing School for Dummies [1 ed.] |
Andrew Evered, Andrew Evered |
1 |
| 648 |
 |
Infectious causes of cancer : a guide for nurses and healthcare professionals |
Campbell, Ken |
|
| 649 |
 |
International Practice Development in Nursing and Healthcare [1 ed.] |
Kim Manley, Kim Manley (MN.), Valerie Wilson |
1 |
| 650 |
 |
Law and Ethics in Children's Nursing [1 ed.] |
Judith Hendrick |
1 |
| 651 |
 |
Lymphoedema Care [1 ed.] |
Mary Elizabeth Woods |
1 |
| 652 |
 |
Mental Health Care 3rd Edition [3 ed.] |
Catherine Hungerford et al. |
3 |
| 653 |
 |
Mental Health Care: An Introduction for Health Professionals in Australia [2nd ed.] |
Catherine Hungerford et al. |
2 |
| 654 |
 |
Mentoring in nursing and healthcare : supporting career and personal development |
Fielden, Sandra L., Woolnough, Helen M |
|
| 655 |
 |
Narrative Research in Nursing |
Immy Holloway, Dawn Freshwater |
|
| 656 |
 |
Nursing law and ethics [4th ed.] |
Tingle, John, Cribb, Alan |
4 |
| 657 |
 |
Older People and Mental Health Nursing: A Handbook of Care [1 ed.] |
Rebecca Neno, Barry Aveyard, Hazel Heath |
1 |
| 658 |
 |
Pathophysiology for nurses at a glance |
Nair, Muralitharan,Peate, Ian |
|
| 659 |
 |
Respiratory nursing at a glance [Enhanced Credo edition] |
Kelly, Carol Ann,Preston, Wendy |
|
| 660 |
 |
Revealing Nursing Expertise Through Practitioner Inquiry |
Sally Hardy, Angie Titchen, Kim Manley, Brendan McCormack |
|
| 661 |
 |
The Royal Marsden Hospital Manual of Clinical Nursing Procedures, Professional Edition [Student Edition, 8th Edition] |
Lisa Dougherty, Sara Lister |
8 |
| 662 |
 |
Whelan, A: Clinical Skills for Healthcare Assistants and Ass [2 ed.] |
Angela Whelan (editor), Elaine Hughes (editor) |
2 |
| 663 |
 |
Breast Cancer Nursing [1 ed.] |
Sylvia Denton (auth.), Sylvia Denton (eds.) |
1 |
| 664 |
 |
Care of the Ophthalmic Patient: A guide for nurses and health professionals |
Mary Rowell (auth.), John P. Perry, Andrew B. Tullo (eds.) |
1 |
| 665 |
 |
Challenges in Caring: Explorations in nursing and ethics [1 ed.] |
James M. Brown, Alison L. Kitson, Terence J. McKnight (auth.) |
1 |
| 666 |
 |
Clinical Supervision and Mentorship in Nursing [1 ed.] |
Tony Butterworth (auth.), Tony Butterworth, Jean Faugier (eds.) |
1 |
| 667 |
 |
Clinical Teaching in Nursing [1 ed.] |
Ruth White, Christine Ewan (auth.) |
1 |
| 668 |
 |
Community Psychiatric Nursing: A research perspective [1 ed.] |
Edward White (auth.), Charles Brooker BA(Hons), MSc, RMN, DipNEd, RNT, Edward White MSc(SocPol), MSc(SocRes), RMN, DipCPN, PGCEA, RNT (eds.) |
1 |
| 669 |
 |
Conceptual Nursing in Practice: A research-based approach [1 ed.] |
Mary Fraser PhD, MSc, BSc (Hons), DipN.Ed, RGN, ONC, RNT (auth.) |
1 |
| 670 |
 |
Current Issues In Nursing |
Moya Jolley (auth.), Moya Jolley MA(Ed), BSc(Econ), DipEd, SRN, RNT, Dip in Nursing Education (Lond), Peta Allan MA, DipFEd, SRN, ONC, RNT, FBIM (eds.) |
1 |
| 671 |
 |
Developing Your Career in Nursing [1 ed.] |
Desmond Cormack (auth.), Desmond F. S. Cormack RGN, RMN, DIP ED, DIP NURS, MPHIL, PHD (eds.) |
1 |
| 672 |
 |
Issues in Accident and Emergency Nursing [1 ed.] |
A. McKenna, C. Woolwich, K. Burgess (auth.), Lynn Sbaih BSc(Hons), RGN, RMN, ENB, 199 (eds.) |
1 |
| 673 |
 |
Management and Practice in Emergency Nursing [1 ed.] |
Jill Milnthorpe (auth.), Bob Wright (eds.) |
1 |
| 674 |
 |
Nursing as Therapy [1 ed.] |
Richard McMahon (auth.), Richard McMahon, Alan Pearson (eds.) |
1 |
| 675 |
 |
Nursing in General Practice: A foundation text [1 ed.] |
Jacqueline Mansfield (auth.), Sarah Luft BSc(Hons), RGN, NDN, Milly Smith MSc, RGN, QN (eds.) |
1 |
| 676 |
 |
Nursing Research: The Application of Qualitative Approaches [1 ed.] |
Janice M. Morse, Peggy Anne Field (auth.) |
1 |
| 677 |
 |
Nursing Research: Theory and practice [1 ed.] |
Michael Hardey, Anne Mulhall (auth.), Michael Hardey, Anne Mulhall (eds.) |
1 |
| 678 |
 |
Nursing the Child with Respiratory Problems |
Joan Ramsay RGN, DipN(London), Cert Ed, RNT (auth.) |
1 |
| 679 |
 |
Professional Care for the Elderly Mentally Ill [1 ed.] |
Laraine Chaisty (auth.), Liz Matthew (eds.) |
1 |
| 680 |
 |
Professional Interpersonal Skills for Nurses [1 ed.] |
Carolyn Kagan, Josie Evans (auth.) |
1 |
| 681 |
 |
Psychiatric and Mental Health Nursing: Theory and practice [1 ed.] |
William Reynolds RMN, RNT, RGN, MPhil, Desmond F. S. Cormack RMN, RGN, MPhil, Dip Ed, Dip Nurs, PhD (auth.) |
1 |
| 682 |
 |
Psychiatric Nursing Skills: A patient-centred approach [1 ed.] |
Graham Dexter, Michael Wash (auth.) |
1 |
| 683 |
 |
Rediscovering Nursing: A guide for the returning nurse [1 ed.] |
Martin Johnson, Olive Bertie, Len Gellard, Judith Morris, Denise Button (auth.) |
1 |
| 684 |
 |
Stress and Coping in Nursing [1 ed.] |
Roy Bailey, Margaret Clarke (auth.) |
1 |
| 685 |
 |
Teaching Transcultural Care: A guide for teachers of nursing and health care [1 ed.] |
Paula McGee (auth.) |
1 |
| 686 |
 |
The Internet for Nurses and Allied Health Professionals |
Margaret J. A. Edwards Ph.D., R.N. (auth.) |
|
| 687 |
 |
The Practice Nurse: Theory and Practice |
Pauline Jeffree (auth.) |
|
| 688 |
 |
The Practice Nurse: Theory and Practice [2 ed.] |
Pauline Jeffree (auth.) |
2 |
| 689 |
 |
The Professional Nurse: Coping with Change, Now and the Future [1 ed.] |
Michael Bowman BEd, MEd, PhD, SRN, NTD(Lond.), RNT, MBIM (auth.) |
1 |
| 690 |
 |
The Promotion of Continence in Adult Nursing [1 ed.] |
David Colborn (auth.) |
1 |
| 691 |
 |
Themes and Perspectives in Nursing [1 ed.] |
Lesley Mackay (auth.), Professor Keith Soothill, Professor Christine Henry, Mr Kevin Kendrick (eds.) |
1 |
| 692 |
 |
Secondary Traumatic Stress in Nursing: A Walker and Avant Concept Analysis |
Kellogg, Marni B. PhD, RN, CPN, CNE |
|
| 693 |
 |
Health Assessment in Nursing [7 ed.] |
Janet R. Weber, Jane H. Kelley |
7 |
| 694 |
 |
Fundamentals of Nursing: Concepts and Competencies for Practice [9 ed.] |
Ruth F. Craven, Constance Hirnle, Christine Henshaw |
9 |
| 695 |
 |
Abrams’ Clinical Drug Therapy: Rationales for Nursing Practice [12 ed.] |
Geralyn Frandsen, Sandra Smith Pennington |
12 |
| 696 |
 |
Nursing 2021 Drug Handbook [Forty-First ed.] |
Lippincott Williams &, Wilkins |
41 |
| 697 |
 |
Telephone Triage Protocols for Nurses [6 ed.] |
Julie K. Briggs |
6 |
| 698 |
 |
Maternity and Pediatric Nursing [4 ed.] |
Susan Scott Ricci, Terri Kyle, Susan Carman |
4 |
| 699 |
 |
Nursing Health Assessment: a best practice approach [Third edition.] |
Jensen, Sharon |
3 |
| 700 |
 |
Evidence-based practice in nursing & healthcare: a guide to best practice [Fourth edition.] |
Fineout-Overholt, Ellen, Melnyk, Bernadette Mazurek |
4 |
| 701 |
 |
Theoretical basis for nursing [Fifth edition.] |
McEwen, Melanie, Wills, Evelyn M. |
5 |
| 702 |
 |
The Clinical Practice of Neurological and Neurosurgical Nursing [8 ed.] |
Joanne V. Hickey |
8 |
| 703 |
 |
Document Smart: The a-To-Z Guide to Better Nursing Documentation [4 ed.] |
Theresa Capriotti |
4 |
| 704 |
 |
Gerontological nursing [Ninth edition.] |
Eliopoulos, Charlotte |
9 |
| 705 |
 |
Essentials of nursing research: appraising evidence for nursing practice [Ninth edition.] |
Beck, Cheryl Tatano, Polit, Denise F. |
9 |
| 706 |
 |
Community and public health nursing: promoting the public’s health [Ninth edition.] |
Rector, Cherie L. |
9 |
| 707 |
 |
Lippincott Nursing Procedures [8 ed.] |
Lippincott |
8 |
| 708 |
 |
Nursing Documentation Made Incredibly Easy! [5 ed.] |
Kate Stout |
5 |
| 709 |
 |
Nursing research: generating and assessing evidence for nursing practice [Tenth edition.] |
Beck, Cheryl Tatano, Polit, Denise F. |
10 |
| 710 |
 |
Brunner & Suddarth's Textbook of Medical-Surgical Nursing (Brunner and Suddarth's Textbook of Medical-Surgical) [15, North American ed.] |
Janice L Hinkle, Kerry H. Cheever, Kristen Overbaugh |
15 |
| 711 |
 |
Medical-Surgical Nursing Made Incredibly Easy! [4 ed.] |
LWW, Springhouse Publishing Company Staff |
4 |
| 712 |
 |
Health assessment in nursing. [5th edition.] |
Janet R. Weber |
5 |
| 713 |
 |
Evidence-based practice in nursing and healthcare: a guide to best practice [3. ed] |
Fineout-Overholt, Ellen,Melnyk, Bernadette Mazurek |
3 |
| 714 |
 |
The Continuum of Stroke Care : An Interprofessional Approach to Evidence-Based Care |
Joanne V. Joanne V. Hickey, Sarah Livesay |
|
| 715 |
 |
Nursing Procedures Made Incredibly Easy! [2 ed.] |
Lippincott Williams &, Wilkins |
2 |
| 716 |
 |
Core Curriculum for Forensic Nursing |
Bonnie Price, Kathleen Maguire, Bonnie Price |
|
| 717 |
 |
Nurse's Legal Handbook [6 ed.] |
Kathy Ferrell |
6 |
| 718 |
 |
Wound Care Made Incredibly Easy [3 ed.] |
Lippincott Williams &, Wilkins |
3 |
| 719 |
 |
Fundamentals of Nursing Made Incredibly Easy! [2 ed.] |
Lippincott Williams &, Wilkins |
2 |
| 720 |
 |
Plumer's Principles and Practice of Infusion Therapy [Ninth ed.] |
Sharon M. Weinstein, Mary E Hagle |
9 |
| 721 |
 |
Study guide for Essentials of nursing research, appraising evidence for nursing practice [8. ed.] |
Denise F. Polit, Cheryl T. Beck |
8 |
| 722 |
 |
Abrams' clinical drug therapy : rationales for nursing practice [10ed.] |
Geralyn Frandsen, Sandra Smith Pennington, Anne Collins Abrams |
10 |
| 723 |
 |
Community and public health nursing: promoting the public's health [8th ed] |
Allender, Judith Ann,Rector, Cherie L.,Warner, Kristine D |
8 |
| 724 |
 |
Professional Issues in Nursing; Challenges and Opportunities [3 ed.] |
Carol J. Huston |
3 |
| 725 |
 |
Core Curriculum for Vascular Nursing: An Official Publication of the Society for Vascular Nursing (SVN) |
Cynthia Rebik Christensen, Patricia A. Lewis |
2 |
| 726 |
 |
Defining Excellence in Simulation Programs |
Janice C. Palaganas, Juli C. Maxworthy, Chad A. Epps, Mary E. Mancini, Mary Elizabeth Mancini |
|
| 727 |
 |
Lippincott Nursing Drug Guide [2015 ed.] |
Amy Karch |
2015 |
| 728 |
 |
Perinatal Nursing |
Kathleen Rice Simpson, Pat A Creehan |
|
| 729 |
 |
Math for nurses : a pocket guide to dosage calculation and drug preparation [8ed.] |
Mary Jo Boyer |
8 |
| 730 |
 |
Maternity and pediatric nursing. [2ed] |
Susan Scott Ricci, Susan Carman, Terri Kyle |
2 |
| 731 |
 |
Essentials of critical care nursing : a holistic approach |
Patricia Gonce Morton, Dorrie Fontaine |
|
| 732 |
 |
Critical care nursing: a holistic approach [10th ed] |
Fontaine, Dorrie,Morton, Patricia Gonce |
10 |
| 733 |
 |
Lippincott's review for medical-surgical nursing certification [5th ed] |
M. Pottage |
5 |
| 734 |
 |
Medical-surgical Nursing |
Lippincott., Springhouse |
1 |
| 735 |
 |
Quick reference to critical care [4th ed] |
Nancy H. Diepenbrock RN CCRN |
4 |
| 736 |
 |
Nursing research : generating and assessing evidence for nursing practice [9 ed.] |
Beck, Cheryl Tatano, Polit, Denise F. |
9 |
| 737 |
 |
Drug Therapy in Nursing [4th Edition] |
Diane S. Aschenbrenner, Samantha J. Venable |
4 |
| 738 |
 |
Handbook for Focus on Adult Health: Medical-Surgical Nursing [1st ed.] |
Linda Honan Pellico, Andrea Rothman Mann |
1 |
| 739 |
 |
Taylor's clinical nursing skills : a nursing process approach [3rd ed] |
Pamela Barbara Lynn, Carol Taylor, CSFN |
3 |
| 740 |
 |
NCLEX-RN review made incredibly easy! [5th ed] |
Lippincott Williams &, Wilkins |
5 |
| 741 |
 |
Qualitative Research in Nursing: Advancing the Humanistic Imperative [5 ed.] |
Helen Streubert Speziale, Helen J. Streubert, Dona Rinaldi Carpenter |
5 |
| 742 |
 |
Professional Issues in Nursing; Challenges and Opportunities [2 ed.] |
Carol J. Huston |
2 |
| 743 |
 |
Nurse's 3-minute clinical reference [2nd ed] |
Springhouse |
2 |
| 744 |
 |
Springhouse Review for Medical-Surgical Nursing Certification [4th ed] |
Springhouse |
4 |
| 745 |
 |
Clinical calculations made easy : solving problems using dimensional analysis [3rd ed] |
Gloria P Craig |
3 |
| 746 |
 |
Nurse's Quick Check : Signs and Symptoms [1 ed.] |
Springhouse |
1 |
| 747 |
 |
Nurse's Quick Check : Skills [1 ed.] |
Springhouse |
1 |
| 748 |
 |
Nursing Herbal Medicine Handbook [3rd ed] |
Springhouse |
3 |
| 749 |
 |
Nurse's Legal Handbook [5th ed] |
Springhouse |
5 |
| 750 |
 |
Medical-Surgical Care Planning [4 ed.] |
Nancy M. Holloway |
4 |
| 751 |
 |
Springhouse Review for Psychiatric and Mental Health Nursing Certification [Third ed.] |
Springhouse, Nancy Randolph |
3 |
| 752 |
 |
Nosotras, enfermeras |
saturada, Enfermera |
|
| 753 |
 |
Nursing fundamentals demystified |
Vaughans, Bennita W |
|
| 754 |
 |
Nursing the Heart |
Creeden, P. |
|
| 755 |
 |
Temas de Enfermería Médico-Quirúrgica |
María C. Fenton Tait / Carlos A. León Román |
|
| 756 |
 |
TEMAS DE GUARDIA |
Eloisa |
|
| 757 |
 |
Diary of a Nursing Sister on the Western Front, 1914-1915 |
|
|
| 758 |
 |
The White Linen Nurse |
Eleanor Hallowell Abbott |
|
| 759 |
 |
Notes on Nursing |
Florence Nightingale |
|
| 760 |
 |
Ética y enfermería |
Grande, Lydia Feito |
|
| 761 |
 |
Making Good On Private Duty |
Harriet Camp Lounsbery |
|
| 762 |
 |
Fluid and electrolyte balance : nursing considerations [4th ed] |
Norma Milligan Metheny PhD RN FAAN |
4 |
| 763 |
 |
Fluids & electrolytes : a 2-in-1 reference for nurses [1 ed.] |
Springhouse |
1 |
| 764 |
 |
The Army Nurse Corps in World War II |
Judith A. Bellafaire |
|
| 765 |
 |
The White Road to Verdun |
Kathleen Burke |
|
| 766 |
 |
Pharmacology for Student and Pupil Nurses and Students in Associated Professions |
Bernard R. Jones |
|
| 767 |
 |
Nursing delegation and management of patient care [Second edition] |
Burke, Kathleen, Motacki, Kathleen |
2 |
| 768 |
 |
Applied Psychology for Nurses |
Mary F. Porter |
|
| 769 |
 |
Taschenwissen Pflege Psychiatrie |
Marvin Kaiser |
|
| 770 |
 |
Wonderful Adventures of Mrs. Seacole in Many Lands |
Seacole, Mary |
|
| 771 |
 |
Enfermería psiquiátrica 5A |
Videbeck, Sheila L. |
|
| 772 |
 |
Field Hospital and Flying Column |
Violetta Thurstan |
|
| 773 |
 |
Introduccion a la enfermeria de la salud mental |
Womble, Donna |
|
| 774 |
 |
Nursing Informatics and the Foundation of Knowledge |
Mcgonigle |
|
| 775 |
 |
I'm a Nurse: Warum ich meinen Beruf als Krankenschwester liebe – trotz allem |
Kubsova, Jarka & Böhler, Franziska |
|
| 776 |
 |
Guía de cuidados de personas mayores (Sintesís gerontología) |
Melero (editor), Andrés Pérez |
|
| 777 |
 |
Manual de practica basica del adulto mayor |
|
|
| 778 |
 |
La presencia intencional en la asistencia sanitaria (Ciencias Salud) |
Monge Moreno, Jesús Tomás |
|
| 779 |
 |
2012 Lippincott's Nursing Drug Guide [1 ed.] |
Amy M. Karch |
1 |
| 780 |
 |
Anatomía y fisiología para enfermeras |
Peate,Ian |
|
| 781 |
 |
Colección Lippincott Enfermería. Un enfoque práctico y conciso: Anatomía y fisiología, 5.ª |
LWW |
|
| 782 |
 |
Colección Lippincott Enfermería. Un enfoque práctico y conciso: Cálculo y administración de medicamentos (Enfermeria Facil / Easy Nursing) |
Wilkins, Lippincott Williams |
|
| 783 |
 |
Colección Lippincott Enfermería. Un enfoque práctico y conciso: Enfermería cardiovascular, 3.ª |
LWW |
|
| 784 |
 |
Colección Lippincott Enfermería. Un enfoque práctico y conciso: Enfermería materno-neonatal (Enfermeria Facil / Easy Nursing) |
Wilkins, Lippincott Williams |
|
| 785 |
 |
Colección Lippincott Enfermería. Un enfoque práctico y conciso: Farmacología, 4.ª |
LWW |
|
| 786 |
 |
Colección Lippincott Enfermería. Un enfoque práctico y conciso: Enfermería medicoquirúrgica, 4.ª |
LWW |
|
| 787 |
 |
Diagnósticos enfermeros. Definiciones y clasificación 2018-2020 |
International, Nanda |
|
| 788 |
 |
Enfermería en neurorrehabilitación: Empoderando el autocuidado |
Lendínez Mesa, Alejandro |
|
| 789 |
 |
Enfermería fácil. Cuidado y atención de heridas, 3.ª (Enfermeria Facil / Easy Nursing) |
Wilkins, Lippincott Williams |
|
| 790 |
 |
Enfermería fácil. Enfermería del paciente en estado crítico (Enfermeria Facil / Easy Nursing) |
Wilkins, Lippincott Williams |
|
| 791 |
 |
Enfermería fácil. Enfermería pediátrica, 2.ª (Enfermeria Facil / Easy Nursing) |
Wilkins, Lippincott Williams |
|
| 792 |
 |
Enfermería fácil. Fundamentos de enfermería, 2.ª (Enfermeria Facil / Easy Nursing) |
Williams, Lippincott & Wilkins |
|
| 793 |
 |
Enfermería fácil. Procedimientos en enfermería, 2.ª (Enfermeria Facil / Easy Nursing) |
Williams, Lippincott & Wilkins |
|
| 794 |
 |
Enfermería gerontológica |
Eliopoulos, Charlotte |
|
| 795 |
 |
Enfermería médico-quirúrgica |
Marlene Hurst |
|
| 796 |
 |
Enfermería psiquiátrica |
Galiana Roch, José Luis |
|
| 797 |
 |
Farmacología para Enfermería. Un enfoque fisiopatológico |
Michael Patrick Adams |
|
| 798 |
 |
Fundamentos de Enfermeria en Psiquiatria |
Mary C. Townsend |
|
| 799 |
 |
Havard |
Adriana Tiziani |
|
| 800 |
 |
Manual de valoración de la salud en enfermería |
Weber, Janet R |
|
| 801 |
 |
Salud mental: Enfermería psiquiátrica (Enfermería, fisioterapia y podología. Serie enfermería) |
García (editor), Julio Bobes |
|
| 802 |
 |
LIR: Sistemas integrados, 1e |
Leeper-Woodford, Sandra K. |
|
| 803 |
 |
2014 Lippincott’s Nursing Drug Guide [1st ed.] |
Amy M. Karch |
1 |
| 804 |
 |
Anatomy & Physiology Made Incredibly Easy! Workout (Incredibly Easy! Series) [1 ed.] |
Springhouse |
1 |
| 805 |
 |
Chart Smart: The A-to-Z Guide to Better Nursing Documentation [Third ed.] |
Lippincott Williams &, Wilkins |
3 |
| 806 |
 |
Fundamentos enfermeros en el proceso de administración de medicamentos |
|
|
| 807 |
 |
Clinical Drug Therapy: Rationales for Nursing Practice, Ninth Edition [9th ed.] |
Anne Collins Abrams, Carol Barnett Lammon, Sandra Smith Pennington |
9 |
| 808 |
 |
Clinical Drug Therapy Nursing |
Anne Collins Abrams, Sandra Smith Pennington, Carol Barnett Lammon |
7 |
| 809 |
 |
Fluids and Electrolytes Made Incredibly Easy! [6th ed.] |
Laura Willis (ed.) |
6 |
| 810 |
 |
Medical-Surgical Nursing Made Incredibly Easy! [3rd Edition] |
Lippincott Williams &, Wilkins |
3 |
| 811 |
 |
Adult Health Nursing [9 ed.] |
Kim Cooper, Kelly Gosnell |
9 |
| 812 |
 |
Advanced Health Assessment and Clinical Diagnosis in Primary Care [5 ed.] |
Joyce E Dains, Linda Ciofu Baumann, Pamela Scheibel |
5 |
| 813 |
 |
AACN Core Curriculum for Progressive and Critical Care Nursing (by Team-IRA) [8 ed.] |
AACN (editor), Tonja Hartjes DNP CNS APRN CNE®cl CCRN FAANP (editor) |
8 |
| 814 |
 |
Admission Assessment Exam Review [Paperback ed.] |
HESI |
|
| 815 |
 |
Anatomie et physiologie pour les AS et AP: Avec cahier d'apprentissage et lexique [3e édition ed.] |
Ramé Alain, Thérond Sylvie, Sylvie Thérond |
3 |
| 816 |
 |
Anatomie lernen durch Beschriften: in Pflege- und Gesundheitsberufen |
Elsevier GmbH (editor) |
|
| 817 |
 |
Basic Geriatric Nursing [8 ed.] |
Patricia A. Williams |
8 |
| 818 |
 |
Burns & Grove's The Practice of Nursing Research [9 ed.] |
Jennifer R. Gray, Susan K. Grove |
9 |
| 819 |
 |
Calculate with Confidence, 8e |
DEBORAH C. GRAY MORRIS, Deborah C Morris, RN Bsn Ma Lnc |
8 |
| 820 |
 |
Calculate with Confidence [8 ed.] |
Deborah C. Morris |
8 |
| 821 |
 |
Burns and Grove's The Practice of Nursing Research: Appraisal, Synthesis, and Generation of Evidence [9 ed.] |
Jennifer R. Gray PhD RN FAAN, Susan K. Grove PhD RN ANP-BC GNP-BC |
9 |
| 822 |
 |
Canadian Fundamentals of Nursing [6th ed.] |
Patricia A. Potter, Anne Griffin Perry, Patricia Stockert, Amy Hall, Barbara J. Astle, Wendy Duggleby |
6 |
| 823 |
 |
Clinical Companion for Medical-Surgical Nursing [7th Edition] |
Ignatavicius, Donna D.,Workman, M. Linda |
7 |
| 824 |
 |
Concepts for Nursing Practice 3rd Edition |
Jean Foret Giddens |
3 |
| 825 |
 |
Concept-Based Clinical Nursing Skills: Fundamental to Advanced 1st Edition [1 ed.] |
Stein, Hollen |
1 |
| 826 |
 |
Contemporary Nursing Issues, Trends, & Management [8 ed.] |
Barbara Cherry, Susan R. Jacob |
8 |
| 827 |
 |
Core Curriculum for Neonatal Intensive Care Nursing [6 ed.] |
M. Terese Verklan, Marlene Walden, Sharron Forest |
6 |
| 828 |
 |
Critical Care Nursing Diagnosis and Management [9 ed.] |
Linda D. Urden, Kathleen M. Stacy, Mary E. Lough |
9 |
| 829 |
 |
Contexts of Nursing: An Introduction |
John Daly RN BA MEd(Hons) BHSc(N) PhD MACE AFACHSE FCN FRCNA, Sandra Speedy RN BA(Hons) DipEd MURP EdD MAPS FANZCMHN, Debra Jackson RN PhD SFHEA FACN |
|
| 830 |
 |
Developing Clinical Judgment for Professional Nursing and the Next-Generation NCLEX-RN® Examination [1 ed.] |
Donna D. Ignatavicius MS RN CNE CNEcl ANEF FAADN |
1 |
| 831 |
 |
deWit's Fundamental Concepts and Skills for Nursing: E-Book [5 edition /] |
Williams, Patricia A |
5 |
| 832 |
 |
Postcards of nursing : a world-wide tribute [First edition] |
Casey, Patricia, Gibbons, Tom, Kors, Erika, Zwerdling, Michael |
|
| 833 |
 |
Drain's PeriAnesthesia Nursing: A Critical Care Approach [8 ed.] |
Jan Odom-Forren |
8 |
| 834 |
 |
Fachpflege Gerontopsychiatrie |
Siegfried Charlier |
|
| 835 |
 |
Farmacología en enfermería [2a ed] |
[directoras:] Silvia Castells Molina, Margarita Hernández Pérez |
2 |
| 836 |
 |
Elsevier's 2024 Intravenous Medications: A Handbook for Nurses and Health Professionals |
Shelly Rainforth Collins |
|
| 837 |
 |
Emergency and Trauma Care for Nurses and Paramedics [3 ed.] |
Kate Curtis, Clair Ramsden, Ramon Shaban, Margaret Fry, Julie Considine |
3 |
| 838 |
 |
Foundations for Population Health in Community/Public Health Nursing [6 ed.] |
Marcia Stanhope, Jeanette Lancaster |
6 |
| 839 |
 |
Foundations for Health Promotion |
Naidoo, Jennie, Wills, Jane |
4 |
| 840 |
 |
Essentials of Psychiatric Mental Health Nursing: A Communications Approach to Evidence-Based Care [3 ed.] |
Elizabeth M. Varcarolis |
3 |
| 841 |
 |
Facilitating Aging in Place: Safe, Sound, and Secure, an Issue of Nursing Clinics |
Lazelle E. Benefield |
|
| 842 |
 |
Gahart's 2021 Intravenous Medications: A Handbook for Nurses and Health Professionals [37 ed.] |
Betty L. Gahart RN, Adrienne R. Nazareno PharmD, Meghan Ortega RN |
37 |
| 843 |
 |
Gahart’s 2019 Intravenous Medications: A Handbook for Nurses and Health Professionals [Spiral-bound ed.] |
Betty L Gahart |
|
| 844 |
 |
Gesundheits- und Krankenpflege: Prüfungsvorbereitung für Pflegeberufe |
Christa Junginger |
|
| 845 |
 |
Resource Manual for Nursing Research: Generating and Assessing Evidence for Nursing Practice, 9th Edition [9th Edition] |
Denise F. Polit PhD FAAN, Cheryl Tatano Beck DNSc CNM FAAN |
9 |
| 846 |
 |
Elsevier's Medical Terminology for the Practicing Nurse: In English [1 ed.] |
S.F. Vanderwerf |
1 |
| 847 |
 |
Essentials for nursing practice [Ninth edition] |
Hall, Amy M.,Perry, Anne Griffin,Potter, Patricia Ann,Stockert, Patricia A |
9 |
| 848 |
 |
Gray Morris's Calculate with Confidence [2nd Canadian Edition] |
Tania Killian |
2 |
| 849 |
 |
guide infirmier des urgences: 200 fiches, conduites tenir, gestes techniques, médicaments de l'urgence |
B, Marc |
|
| 850 |
 |
Guide infirmier des urgences |
Bernard Marc, Patrick Miroux, Isabelle Piedade, Dominique Pateron, Collectif |
|
| 851 |
 |
Guide pratique de l'infirmière [2nd ed] |
Perlemuter, Gabriel, Perlemuter, Léon |
2 |
| 852 |
 |
Guide infirmier des examens de laboratoire (Hors collection) |
Caquet, René |
|
| 853 |
 |
Guide pratique de l'infirmière [2e éd. rev. et augm ed.] |
Léon Perlemuter, Gabriel Perlemuter |
2 |
| 854 |
 |
Health Promotion Throughout the Life Span [10 ed.] |
Carole Lium Edelman, Elizabeth Connelly Kudzma |
10 |
| 855 |
 |
HESI Comprehensive Review for the NCLEX-RN Examination 6th Edition [6 ed.] |
Elsevier |
6 |
| 856 |
 |
Hesi Comprehensive Review for the Nclex-Pn Examination [Paperback ed.] |
HESI |
|
| 857 |
 |
HESI Comprehensive Review for the NCLEX-RN Examination [4 ed.] |
HESI |
4 |
| 858 |
 |
Hesi Comprehensive Review for the Nclex-RN Examination [Paperback ed.] |
HESI |
|
| 859 |
 |
Illustrated Guide for Theatre Nurses |
A. Marjorie Matthias, Margaret J. Penfold and Susan Fry (Auth.) |
|
| 860 |
 |
Interpersonal Relationships_ Professional Communication Skills for Canadian Nurses |
ELIZABETH C. ARNOLD, KATHLEEN UNDERMAN BOGGS, CLAIRE MALLETTE, OLIVE YONGE |
|
| 861 |
 |
Interpersonal Relationships: Professional Communication Skills for Nurses [7 ed.] |
Elizabeth Arnold, Kathleen Underman Boggs |
7 |
| 862 |
 |
Klinikleitfaden Nachtdienst - Sicher fühlen und kompetent handeln: Mit Zugang zur Medizinwelt [6 ed.] |
Anja Kraemer (editor) |
6 |
| 863 |
 |
Lehne's pharmacology for nursing care [9th edition] |
Burchum, Jacqueline Rosenjack,Jones, Beth Outland,Lehne, Richard A.,Neumiller, Joshua J.,Rosenthal, Laura D |
9 |
| 864 |
 |
Lehne’s Pharmacology for Nursing Care [10th ed.] |
Jacqueline Rosenjack Burchum, Laura D. Rosenthal |
10 |
| 865 |
 |
Lewis's Medical-Surgical Nursing in Canada, 5th Edition [5 ed.] |
Jane Tyerman, Shelley Cobbett, Mariann M. Harding, Jeffrey Kwong, Dottie Roberts, Debra Hagler, Courtney Reinisch |
5 |
| 866 |
 |
Lewis's Medical Surgical Nursing: Assessment and Management of Clinical Problems [3 ed.] |
Diane Brown, Helen Edwards |
3 |
| 867 |
 |
LoBiondo-Wood and Haber's Nursing Research in Canada [5th Edition] |
Geri LoBiondo-Wood, Mina D. Singh, Lorraine Thirsk, Judith Haber, Sarah Stahlke, Ramesh Venkatesa Perumal |
5 |
| 868 |
 |
Fundamentals of Nursing [11 ed.] |
Patricia A. Potter RN PhD FAAN, Anne G. Perry RN MSN EdD FAAN, Patricia A. Stockert RN BSN MS PhD, Amy Hall RN BSN MS |
11 |
| 869 |
 |
Fundamentals of Nursing [10th edition.] |
Hall, Amy M., Perry, Anne Griffin, Potter, Patricia Ann, Stockert, Patricia A. |
10 |
| 870 |
 |
Knowledge Development in Nursing: Theory and Process [11 ed.] |
Peggy L. Chinn, Maeona K. Kramer, Kathleen Sitzman |
11 |
| 871 |
 |
Manual of Critical Care Nursing: Nursing Interventions and Collaborative Management [7 ed.] |
Marianne Saunorus Baird |
7 |
| 872 |
 |
Medical-Surgical Nursing E-Book |
Adrianne Dill Linton, Mary Ann Matteson |
7 |
| 873 |
 |
Medical-surgical nursing: concepts and practice [3 edition] |
Dallred, Carol,DeWit, Susan C.,Stromberg, Holly |
3 |
| 874 |
 |
Medical-Surgical Nursing: Concepts for Interprofessional Collaborative Care [10 ed.] |
Donna D. Ignatavicius MS RN CNE CNEcl ANEF FAADN |
10 |
| 875 |
 |
Medizinische Fachwörter von A-Z: Kleines Lexikon für Pflege- und Gesundheitsfachberufe [1 ed.] |
Anna-Marie Seitz |
1 |
| 876 |
 |
Merenstein & Gardner's Handbook of Neonatal Intensive Care: An Interprofessional Approach [9 ed.] |
Sandra Gardner RN MS CNS PNP, Brian Carter MD FAAP, Mary Enzman-Hines APRN PhD CNS CPNP APHN-BC, Susan Niermeyer MD MPH FAAP |
9 |
| 877 |
 |
NANDA International, Inc. : diagnósticos enfermeros, definiciones y clasificación : 2018-2020 [11ª ed.] |
Shigemi Kamitsuru, , T. Heather Herdman |
11 |
| 878 |
 |
Nursing Calculations [9th. ed.] |
Gatford, John D., Phillips, Nicole |
9 |
| 879 |
 |
Nursing Interventions & Clinical Skills E-Book [Seventh edition] |
Ostendorf, Wendy,Perry, Anne Griffin,Potter, Patricia Ann |
7 |
| 880 |
 |
PeriAnesthesia Nursing Core Curriculum: Preprocedure, Phase I and Phase II PACU Nursing [4 ed.] |
Lois Schick, Pamela E. Windle |
4 |
| 881 |
 |
Perioperative Nursing - EBook-epub: An Introduction |
Hamlin, L.,Davies, M.,Richardson-Tench, M.,Sutherland-Fraser, S. |
|
| 882 |
 |
Pharmacology and the Nursing Process [9 ed.] |
Linda Lane Lilley, Shelly Rainforth Collins, Julie S. Snyder |
9 |
| 883 |
 |
Physical Examination and Health Assessment [9 ed.] |
Carolyn Jarvis, Ann Eckhardt |
9 |
| 884 |
 |
Physical Examination & Health Assessment [2 ed.] |
Carolyn Jarvis |
2 |
| 885 |
 |
Physical Examination and Health Assessment E-Book [8 ed.] |
Carolyn Jarvis |
8 |
| 886 |
 |
Prüfung Pflegefachperson schriftlich - Tag 2 |
Nadine Regnet (editor), Verena Bikas (editor) |
|
| 887 |
 |
Potter and Perry's Canadian Fundamentals of Nursing 7th Edition [7 ed.] |
Barbara J. Astle, Wendy Duggleby, Patricia A. Potter, Patricia A. Stockert, Anne Griffin Perry, Amy M. Hall |
7 |
| 888 |
 |
Prüfung Pflegefachperson schriftlich - Tag 3 |
Verena Bikas (editor), Erik Herrmann (editor) |
|
| 889 |
 |
Prüfung Pflegefachperson schriftlich - Tag 1 |
Roland Böhmer-Breuer (editor), Verena Bikas (editor) |
|
| 890 |
 |
Nursing Research in Canada [FIFTH EDITION] |
MINA D. SINGH, GERI LOBIONDO-WOOD, SARAH STAHLKE , RAMESH VENKATESA PERUMAL |
5 |
| 891 |
 |
Nursing Today: Transition and Trends [11 ed.] |
Joann Zerwekh, Ashley Zerwekh Garneau |
11 |
| 892 |
 |
Nursing Delegation and Management of Patient Care [2nd ed.] |
Kathleen Motacki, Kathleen Burke |
2 |
| 893 |
 |
Prioritization, Delegation, and Assignment: Practice Exercises for the NCLEX-RN® Examination [5 ed.] |
Linda A. LaCharity, Candice K. Kumagai, Shirley M. Hosler |
5 |
| 894 |
 |
Professional Nursing: Concepts & Challenges [10 ed.] |
Beth Perry Black |
10 |
| 895 |
 |
Public Health Nursing: Population-Centered Health Care in the Community [8th ed.] |
Marcia Stanhope, Jeanette Lancaster |
8 |
| 896 |
 |
Professional Nursing Concepts & Challenges [9 ed.] |
Beth Perry Black |
9 |
| 897 |
 |
Strategies for Student Success on the Next Generation NCLEX® (NGN) Test Items |
Linda Anne Silvestri, Angela Elizabeth Silvestri, Donna D. Ignatavicius |
|
| 898 |
 |
Study guide Pharmacology for nursing care [9th edition] |
Burchum, Jacqueline Rosenjack,Lehne, Richard A.,Rosenthal, Laura D.,Yeager, Jennifer J |
9 |
| 899 |
 |
Success in Practical/Vocational Nursing: E-Book |
Knecht, Patricia |
|
| 900 |
 |
Success in Practical/Vocational Nursing [10 ed.] |
Lisa Carroll, Janyce L. Collier |
10 |
| 901 |
 |
Taschenwissen Praxisanleitung: Taschenwissen Praxisanleitung |
German Quernheim |
|
| 902 |
 |
Taschenwissen Pflegemanagement |
Christine Schwerdt |
|
| 903 |
 |
Taschenwissen Pflege: Schnell - sicher - praxisnah |
Elsevier GmbH |
|
| 904 |
 |
Tabbner’s Nursing Care : Theory and Practice [8 ed.] |
Gabrielle Koutoukidis, Kate Stainton |
8 |
| 905 |
 |
Taschenwissen Pflegeassistenz: Redaktion: Elsevier Gmbh |
Elsevier GmbH |
|
| 906 |
 |
Understanding Pathophysiology (Canadian Edition) [1st Edition] |
Sue E. Huether |
1 |
| 907 |
 |
Understanding Pathophysiology [ANZ 3rd Edition] |
Christopher Gordon, Judy Craft |
3 |
| 908 |
 |
Understanding Pathophysiology - ANZ adaptation |
Judy Craft, Christopher Gordon, Sue E. Huether, Kathryn L. McCance, Valentina L. Brashers |
|
| 909 |
 |
Varcarolis's Canadian Psychiatric Mental Health Nursing, 3e (Aug 25, 2022)_(0323778798)_(Elsevier).pdf |
MARGARET JORDAN. HALTER |
|
| 910 |
 |
Taschenwissen Kinderkrankenpflege |
Sarah Bayer, Cordula Kornberger-Mechler |
|
| 911 |
 |
Toward Healthy Aging: Human Needs and Nursing Response [11 ed.] |
Theris A. Touhy DNP CNS DPNAP, Kathleen F Jett PhD GNP-BC DPNAP |
11 |
| 912 |
 |
Varcarolis’s Canadian Psychiatric Mental Health Nursing: A Clinical Approach [3 ed.] |
Cheryll L. Pollard, Sonya l. Jakubec |
3 |
| 913 |
 |
Bush nurses: inspiring true stories of nursing bravery and ingenuity in rural and remote Australia |
Brayley, Annabelle |
|
| 914 |
 |
Bush Doctors |
Brayley, Annabelle |
|
| 915 |
 |
Nurses of the Outback |
Annabelle Brayley |
|
| 916 |
 |
Nurses: The Real-Life Experiences of Registered Nurses |
Michael Brown, R.N. |
|
| 917 |
 |
Not Your Average Nurse: From 1970s London to Outback Australia, the True Story of an Unlikely Girl and an Extraordinary Career |
Maggie Groff |
|
| 918 |
 |
Tending Lives: Nurses on the Medical Front |
Echo Heron |
|
| 919 |
 |
The language of kindness: a nurse's story |
Watson, Christie |
|
| 920 |
 |
Complementary medicine for veterinary technicians and nurses [1 ed.] |
Scanlan, Nancy |
1 |
| 921 |
 |
Yes Sister, No Sister: My Life as a Trainee Nurse in 1950s Yorkshire |
Jennifer Craig |
|
| 922 |
 |
A Manual of Laboratory and Diagnostic Tests [Ninth, North American Edition] |
Frances Fischbach RN BSN MSN, Marshall B. Dunning III BS MS PhD |
9 |
| 923 |
 |
A Manual of Laboratory and Diagnostic Tests [7 ed.] |
Frances T Fischbach |
7 |
| 924 |
 |
An Introduction to Theory and Reasoning in Nursing [Fourth ed.] |
Betty Johnson PhD RN, Pamela Webber PhD FNP |
4 |
| 925 |
 |
Assessment Made Incredibly Easy, 4th Edition [4 ed.] |
Springhouse |
4 |
| 926 |
 |
Ask a Colleague: Expert Nurses Answer More Than 1,000 Complex Clinical Questions [1 ed.] |
Springhouse |
1 |
| 927 |
 |
Bates' Nursing Guide to Physical Examination and History Taking, 11th Edition (Guide to Physical Exam & History Taking (Bates)) [11th Edition] |
Beth Hogan-Quigley MSN RN CRNP, Mary Louise Palm MS RN, Lynn S. Bickley MD |
11 |
| 928 |
 |
Best of Incredibly Easy! [1 ed.] |
Springhouse |
1 |
| 929 |
 |
Brunner and Suddarth's Textbook of Medical-Surgical Nursing, 11th Edition (2 Volumes in 1) [11th Updated] |
Suzanne C. Smeltzer, Brenda G. Bare, Janice L. Hinkle, Kerry H. Cheever |
11 |
| 930 |
 |
Brunner and Suddarth's Textbook of Medical-Surgical Nursing (Two Volume Set), Twelfth Edition [12th Edition] |
Suzanne C. Smeltzer, Brenda Bare, Janice L. Hinkle, Kerry H. Cheever |
12 |
| 931 |
 |
Brunner and Suddarth's Textbook of Medical Surgical Nursing: In One Volume [Twelfth, North American Edition, Combined Volume] |
Suzanne C. Smeltzer RNC EdD FAAN, Brenda G. Bare, Janice L. Hinkle PhD RN CNRN, Kerry H. Cheever PhD RN |
12 north american edition |
| 932 |
 |
Brunner and Suddarth's Textbook of Medical-Surgical Nursing 10th ed [Tenth ed.] |
Suzanne C. O'Connell Smeltzer, Brenda G. Bare |
10 |
| 933 |
 |
Canadian Bates' Guide to Health Assessment for Nurses [1 Har/Psc/ ed.] |
Tracey Stephen, Lynn Skillen, Rene A Day, Lynn S Bickley |
1 |
| 934 |
 |
Canadian Maternity, Newborn, & Women's Health Nursing [First Canadian Edition] |
Robin J. Evans RN PhD PNC(C), Marilyn K. Evans RN MN PhD, Yvonne M.R. Brown, Susan A. Orshan PhD RN BC |
|
| 935 |
 |
Career as a Registered Nurse |
Institute For Career Research |
|
| 936 |
 |
Career As a Nurse (RN): Geriatric Nursing |
Institute for Career Research |
|
| 937 |
 |
Cardiac Nursing [Fourth ed.] |
Susan L. Woods, Erika Sivarajan Froelicher, Sandra Adams (Underhill) Motzer |
4 |
| 938 |
 |
Careers in Nursing Specialties |
Institute for Career Research |
|
| 939 |
 |
Clinical Calculations Made Easy, 5th Edition [5 ed.] |
Gloria P. Craig |
5 |
| 940 |
 |
Community & Public Health Nursing: Promoting the Public's Health [Eighth, North American Edition] |
Judith Allender, Cherie Rector, Kristine Warner |
8 north american edition |
| 941 |
 |
Community and Public Health Nursing: Evidence for Practice [3 ed.] |
Rosanna DeMarco, Judith Healey-Walsh |
3 |
| 942 |
 |
Community As Partner: Theory and Practice in Nursing [6° ed.] |
Elizabeth T. Anderson, Judith McFarlane |
6 |
| 943 |
 |
Community and Public Health Nursing: Promoting the Public’s Health [10 ed.] |
Cherie Rector, Mary Jo Stanley |
10 |
| 944 |
 |
Community Health Nursing: Promoting and Protecting the Public's Health, 7th Edition [7th Edition] |
Judith Ann Allender, Cherie Rector, Kristine Warner |
7 |
| 945 |
 |
Conceptual Bases of Professional Nursing [Eighth Edition] |
Lucy J Hood, Susan Leddy, J Mae Pepper |
8 |
| 946 |
 |
Equine Veterinary Nursing [2 ed.] |
Karen Coumbe |
2 |
| 947 |
 |
Critical Care Nursing Made Incredibly Easy! [Third ed.] |
Lippincott |
3 |
| 948 |
 |
Critical Care Challenges: Disorders, Treatments, and Procedures [1 ed.] |
Springhouse |
1 |
| 949 |
 |
Diseases : a nursing process approach to excellent care [4th ed] |
Springhouse |
4 |
| 950 |
 |
Documentation in action |
Springhouse |
|
| 951 |
 |
ElderCare Strategies: Expert Care Plans for Older Adults [1 ed.] |
Springhouse |
1 |
| 952 |
 |
Emergency Nursing Made Incredibly Easy! [Second ed.] |
Lippincott Williams &, Wilkins |
2 |
| 953 |
 |
Empire of Care: Nursing and Migration in Filipino American History |
Catherine Ceniza Choy |
|
| 954 |
 |
Essentials of Critical Care Nursing [1 ed.] |
Patricia Gonce Morton |
1 |
| 955 |
 |
Essentials of Maternity, Newborn, and Women's Health Nursing , Second Edition [Second, North American Edition] |
Susan Scott Ricci |
2 |
| 956 |
 |
Essentials of Nursing Research: Appraising Evidence for Nursing Practice (Essentials of Nursing Research (Polit)) [7th ed.] |
Denise F. Polit PhD FAAN, Cheryl Tatano Beck DNSc CNM FAAN |
7 |
| 957 |
 |
Essentials Of Maternity, Newborn, And Women's Health Nursing [1 ed.] |
Susan Scott Ricci |
1 |
| 958 |
 |
Evidence-Based Practice in Nursing & Healthcare: A Guide to Best Practice [Second ed.] |
Bernadette Mazurek Melnyk, Ellen Fineout-Overholt |
2 |
| 959 |
 |
Florence Nightingale |
Mark Bostridge |
|
| 960 |
 |
Fluids & Electrolytes Made Incredibly Easy! (Incredibly Easy! Series) |
Lippincott |
5 |
| 961 |
 |
Fundamentals of Nursing, North American Edition [8 ed.] |
Carol R. Taylor |
8 |
| 962 |
 |
Fundamentals of Nursing: The Art and Science of Person-Centered Care [9 ed.] |
Carol Taylor, Pamela Lynn, Jennifer L. Bartlett |
9 |
| 963 |
 |
Fundamentals of Nursing: The Art and Science of Nursing Care [Seventh, North American Edition] |
Carol R. Taylor PhD MSN RN, Carol Lillis, Priscilla LeMone, Pamela Lynn |
7 north american edition |
| 964 |
 |
Handbook for Brunner and Suddarth's Textbook of Medical-Surgical Nursing [Twelfth, North American Edition] |
Hilarie Surrena |
12 north american edition |
| 965 |
 |
Handbook of medical-surgical nursing [4th ed] |
Mills, Elizabeth Jacqueline |
4 |
| 966 |
 |
Handbook of Nursing Diagnosis [14 ed.] |
Lynda Juall Carpenito |
14 |
| 967 |
 |
Health Assessment in Nursing [Fourth, North American Edition] |
Janet R. Weber, Jane Kelley |
4 north american edition |
| 968 |
 |
Health Assessment Made Incredibly Visual! (Incredibly Easy! Series), 2nd Edition [2nd Edition] |
Lippincott |
2 |
| 969 |
 |
Henke’s Med-Math: Dosage Calculation, Preparation & Administration [7th ed.] |
Susan Buchholz |
7 |
| 970 |
 |
Informatics and Nursing [Sixth, North American ed.] |
Jeanne Sewell |
6 north american edition |
| 971 |
 |
Introduction to Community-Based Nursing, 4th Edition [4th Edition] |
Roberta Hunt |
4 |
| 972 |
 |
Introductory Mental Health Nursing [2nd Revised edition] |
Donna M. Womble |
2 |
| 973 |
 |
Leadership Roles and Management Functions in Nursing: Theory and Application , Seventh Edition [Seventh, North American Edition] |
Bessie L. Marquis, Carol J. Huston |
7 north american edition |
| 974 |
 |
Lippincott Manual of Nursing Practice [9th ed.] |
Sandra M. Nettina |
9 |
| 975 |
 |
Lippincott’s Fast Facts for NCLEX-PN [Paperback ed.] |
Lippincott Williams &, Wilkins |
|
| 976 |
 |
Lippincott's Review for NCLEX-PN, 9th Edition (Lippincott's State Board Review for Nclex-Pn) [9th Edition] |
Barbara Kuhn Timby, Ann Carmack RN MSN, Diana L. Rupert RN MSN PhD |
9 |
| 977 |
 |
Lippincott's Textbook for Personal Support Workers: A Humanistic Approach to Caregiving [1 ed.] |
Pamela J. Carter, Marilyn McGreer |
1 |
| 978 |
 |
Lippincott's Textbook For Nursing Assistants: A Humanistic Approach to Caregiving, Third Edition [3rd Edition] |
Pamela J. Carter |
3 |
| 979 |
 |
Lippincott's Q & A certification review : emergency nursing [50836th ed.] |
Springhouse |
50836 |
| 980 |
 |
LPN to RN Transitions: Achieving Success in your New Role, 4th Edition [4th ed.] |
Nicki Harrington, Cynthia Lee Terry |
4 |
| 981 |
 |
Maternal and Child Health Nursing: Care of the Childbearing and Childrearing Family , Sixth Edition [6th Edition] |
Adele Pillitteri |
6 |
| 982 |
 |
Maternal & Child Health Nursing: Care of the Childbearing & Childrearing Family [7 ed.] |
R. N. Pillitteri, Adele, Ph. D. |
7 |
| 983 |
 |
NCLEX-PN® 250 New-Format Questions: Preparing for the Revised NCLEX-PN® (Nursing Review Practice) [Second ed.] |
Springhouse |
2 |
| 984 |
 |
NCLEX-PN® Review Made Incredibly Easy! (Incredibly Easy! Series) [Third ed.] |
Springhouse |
3 |
| 985 |
 |
Neurology for Nurses |
J Bickerton and J. Victor Small (Auth.) |
|
| 986 |
 |
Nurses' Quick Reference to Common Lab & Diagnostic Tests [5° ed.] |
III Dunning, Marshall Barnett, Frances Talaska Fischbach |
5 |
| 987 |
 |
Nursing Assistants: A Humanistic Approach to Caregiving [Workbook ed.] |
Pamela J. Carter |
|
| 988 |
 |
Nursing Care Planning Made Incredibly Easy! [Second ed.] |
Lippincott Williams &, Wilkins |
2 |
| 989 |
 |
Nursing Drug Handbook 2012 [32 ed.] |
Lippincott &, Co. |
32 |
| 990 |
 |
Nursing I.V. drug handbook [9th ed] |
Springhouse |
9 |
| 991 |
 |
Nursing in Todays World - Trends, Issues & Management 8th Edition [Eighth ed.] |
Janice Rider Ellis Celia Love Hartley |
8 |
| 992 |
 |
Nursing in Today's World : Trends, Issues & Management , Tenth Edition [Tenth, North American Edition] |
Dr. Janice Rider Ellis RN PhD ANEF, Ms. Celia Love Hartley RN MN ANEF |
10 north american edition |
| 993 |
 |
Nursing Pharmacology Made Incredibly Easy [Third ed.] |
Lippincott Williams &, Wilkins |
3 |
| 994 |
 |
Nursing preceptorship : the practice-education connection [1 ed.] |
Florence Myrick RN BN MScN PhD, Olive Yonge RN MEd PhD CPsych |
1 |
| 995 |
 |
Nursing procedures [4th ed] |
Mills, Elizabeth Jacqueline |
4 |
| 996 |
 |
Nursing procedures and protocols [First edition] |
Doyle, Rita, Houska, Ann E., Magyarits, Kris, Priff, Nancy, Walker, Jenifer F |
|
| 997 |
 |
Nursing Research [Seventh Edition] |
Denise F. Polit, Cheryl Tatano Beck |
7 |
| 998 |
 |
Nursing Today [Eighth Edition] |
Janice Rider Ellis, Celia Love Hartley |
8 |
| 999 |
 |
Nursing2012 Drug Handbook, 32nd Edition (Nursing Drug Handbook) [32nd Edition] |
Lippincott |
32 |
| 1000 |
 |
Nutrition Essentials for Nursing Practice [Seventh, North American Edition] |
Susan G. Dudek RD BS |
7 north american edition |
| 1001 |
 |
Pathophysiology : a 2-in-1 reference for nurses [1 ed.] |
Munson, Carol, Traister, Rob |
1 |
| 1002 |
 |
Pediatric Facts Made Incredibly Quick! (Incredibly Easy! Series) [2 ed.] |
Lippincott |
2 |
| 1003 |
 |
Pharmacology for Student and Pupil Nurses and Student Pharmacy Technicians |
Bernard R. Jones (Auth.) |
|
| 1004 |
 |
Pharmacology for Student and Pupil Nurses and Students in Associated Professions [2nd ed.] |
Bernard R. Jones (Auth.) |
2 |
| 1005 |
 |
Phlebotomy Essentials, 5th Edition [5th Edition] |
Ruth E. McCall BS MT(ASCP), Cathee M. Tankersley |
5 |
| 1006 |
 |
Pocket Guide for Nursing Health Assessment: A Best Practice Approach [1 ed.] |
Sharon Jensen MN RN |
1 |
| 1007 |
 |
Portable LPN : the all-in-one reference for practical nurses [1 ed.] |
Springhouse |
1 |
| 1008 |
 |
Psychiatric-mental health nursing [4 ed.] |
Sheila L. Videbeck |
4 |
| 1009 |
 |
Psychiatric-Mental Health Nursing 8th Edition [8th ed.] |
Sheila L. Videbeck |
8 |
| 1010 |
 |
Realities of Canadian Nursing [4 ed.] |
Marjorie McIntyre, Carol McDonald |
4 |
| 1011 |
 |
Signs & symptoms : a 2-in-1 reference for nurses [1 ed.] |
Munden, Julie, Schaeffer, Liz |
1 |
| 1012 |
 |
Skill Checklists for Fundamentals of Nursing: The Art and Science of Nursing Care, 7th Edition [7th Edition] |
Carol R. Taylor PhD MSN RN, Carol Lillis, Priscilla LeMone, Pamela Lynn, Marilee LeBon BA |
7 |
| 1013 |
 |
Skill Checklists for Taylor's Clinical Nursing Skills: A Nursing Process Approach, Third Edition [Third ed.] |
Pamela Lynn, Marilee LeBon BA |
3 |
| 1014 |
 |
SkillMasters: Better Documentation [1st ed.] |
Springhouse |
1 |
| 1015 |
 |
Skillmasters: Expert ECG interpretation, 2nd Edition [2 ed.] |
Springhouse |
2 |
| 1016 |
 |
Smelter and Bare’s Textbook of Medical-Surgical Nursing [1, 4th ed.] |
Maureen Farrell |
4 |
| 1017 |
 |
Smelter and Bare’s Textbook of Medical-Surgical Nursing [2, 4th ed.] |
Maureen Farrell |
4 |
| 1018 |
 |
Sparks and Taylor's Nursing Diagnosis Pocket Guide [1 ed.] |
Sheila Sparks Ralph, Cynthia M. Taylor |
1 |
| 1019 |
 |
Sparks and Taylor's Nursing Diagnosis Reference Manual [9 ed.] |
Ph.D. Ralph, Sheila Sparks, R.N., R. N. Taylor, Cynthia M. |
9 |
| 1020 |
 |
Sparks and Taylor's Nursing Diagnosis Reference Manual, 8th Edition [8th Edition] |
Sheila Sparks Ralph, Cynthia M. Taylor |
8 |
| 1021 |
 |
Springhouse review for critical care nursing certification [4th ed] |
Springhouse |
4 |
| 1022 |
 |
Statistics for Nursing and Allied Health [1 ed.] |
Stacey Beth Plichta, Laurel S. Garzon |
1 |
| 1023 |
 |
Study Guide for Essentials of Pathophysiology: Concepts of Altered Health States, 3rd Edition [3 ed.] |
Carol M. Porth, Kathleen S. Prezbindowski |
3 |
| 1024 |
 |
Study Guide for Fundamentals of Nursing: The Art and Science of Nursing Care , Seventh Edition [Seventh ed.] |
Carol R. Taylor PhD MSN RN, Carol Lillis, Priscilla LeMone, Pamela Lynn, Marilee LeBon BA |
7 |
| 1025 |
 |
Study Guide to Accompany Brunner and Suddarth's Textbook of Medical-Surgical Nursing , Twelfth Edition |
Suzanne C. Smeltzer |
12 |
| 1026 |
 |
Study Guide to Accompany Pathophysiology: Concepts of Altered Health States [Eighth ed.] |
Carol Mattson Porth |
8 |
| 1027 |
 |
Surgical Care Made Incredibly Visual! |
Lippincott Williams and Wilkins |
|
| 1028 |
 |
Taylor's Handbook of Clinical Nursing Skills [1 Spi Pap/ ed.] |
Pamela Lynn |
1 |
| 1029 |
 |
Textbook of Basic Nursing, 10th Edition [10th Edition] |
Caroline Bunker Rosdahl, Mary T. Kowalski |
10 |
| 1030 |
 |
The Ethical Component of Nursing Education: Integrating Ethics into Clinical Experiences [1 ed.] |
Marcia Sue DeWolf Bosek, Teresa A. Savage |
1 |
| 1031 |
 |
The Lippincott manual of nursing practice [8th ed] |
Sandra M. Nettina MSN ANP-BC |
8 |
| 1032 |
 |
Theoretical Basis for Nursing, Third Edition [3rd Edition] |
Melanie McEwen, Evelyn M. Wills |
3 |
| 1033 |
 |
Theoretical Nursing: Development and Progress [5th ed.] |
Afaf Ibrahim Meleis |
5 |
| 1034 |
 |
Workbook for Lippincott's Textbook for Nursing Assistants: A Humanistic Approach to Caregiving, Third Edition [3rd Edition] |
Pamela J. Carter |
3 |
| 1035 |
 |
Wound Care Essentials: Practice Principles [Second ed.] |
Sharon Baranoski, Elizabeth A. Ayello |
2 |
| 1036 |
 |
Wound Care Essentials: Practice Principles [Third ed.] |
Sharon Baranoski, Elizabeth A. Ayello |
3 |
| 1037 |
 |
Nutrition and Disease Management for Veterinary Technicians and Nurses [2 ed.] |
Ann Wortinger, Kara Burns |
2 |
| 1038 |
 |
Pain Management for Veterinary Technicians and Nurses [1 ed.] |
Mary Ellen Goldberg, Nancy Shaffran |
1 |
| 1039 |
 |
Who Was Clara Barton? |
Stephanie Spinner |
|
| 1040 |
 |
Éthique et soins infirmiers |
|
|
| 1041 |
 |
Diplôme délivré(e): Parole affranchie d'une étudiante infirmière (RECIT) |
Jean-Louis, Raphaëlle |
|
| 1042 |
 |
Brunner y Suddarth enfermería medicoquirúrgica [14a edición.] |
Kerry H. Cheever, Janice L. Hinkle |
14 |
| 1043 |
 |
Brunner and Suddarth's Canadian Textbook of Medical-Surgical Nursing [3 ed.] |
Pauline Paul PhD RN, Rene Day PhD RN, Beverly Williams PhD RN |
3 |
| 1044 |
 |
Handbook for Brunner and Suddarth's Textbook of Medical-Surgical Nursing, 12th Edition [12th Edition] |
Suzanne C. Smeltzer |
12 |
| 1045 |
 |
Enfermeria Medicoquirúrgica Brunner 7a Edicion Volumen 2 |
Smeltzer Suzanne C Y Bare Brenda G |
|
| 1046 |
 |
Enfermeria Medicoquirúrgica Brunner 7a Edicion Volumen 1 |
Smeltzer Suzanne C Y Bare Brenda G |
|
| 1047 |
 |
Infirmières de nuit |
Grimm, Alan |
|
| 1048 |
 |
J'étais une infirmière très délurée |
G., Patricia |
|
| 1049 |
 |
What Nurses Know... Gluten-Free Lifestyle [1 ed.] |
RN Sylvia Llewelyn Bower |
1 |
| 1050 |
 |
What Nurses Know ... PCOS (What Nurses Know...) [1 ed.] |
Karen Roush |
1 |
| 1051 |
 |
Canadian Essentials of Nursing Research, Third Edition [3rd Edition] |
Carmen G Loiselle, Joanne Profetto-McGrath, Denise F Polit, Cheryl Tatano Beck |
3rd Edition |
| 1052 |
 |
Brunner&Suddart's Textbook of Medical-Surgical nursing |
|
|
| 1053 |
 |
Brunner and Suddarth's Textbook of Medical-Surgical Nursing [Twelfth ed.] |
Suzanne C. Smeltzer, Brenda G. Bare, Janice L. Hinkle, Kerry H. Cheever |
12 |
| 1054 |
 |
Brunner & Suddarth’s textbook of medical-surgical nursing [Edition 13.] |
Brunner, Lillian Sholtis, Cheever, Kerry H., Hinkle, Janice L., Suddarth, Doris Smith |
13 |
| 1055 |
 |
Interpreting EKG: EKG Interpretation For Nurses | EKG Interpretation Practice | EKG Interpretation Book |
Mann, Katherine |
|
| 1056 |
 |
EKG's for nursing demystified |
Clutter, Pat |
|
| 1057 |
 |
Beginning Reflective Practice: Foundations in Nursing and Health Care Series [New edition] |
Melanie Jasper |
|
| 1058 |
 |
Quinn's principles and practice of nurse education |
Francis M Quinn, Suzanne J Hughes |
|
| 1059 |
 |
Nursing numeracy : a new approach |
by Carol Chapelhow and Sandra Crouch. |
|
| 1060 |
 |
Nursing, Physician Control, and the Medical Monopoly: Historical Perspectives on Gendered Inequality in Roles, Rights, and Range of Practice |
Group, Thetis M., Roberts, Joan I. |
|
| 1061 |
 |
Compassionate Person-Centered Care for the Dying : An Evidence-Based Palliative Care Guide for Nurses [1 ed.] |
Bonnie Freeman, Tracey DasGupta, Margaret Fitch |
1 |
| 1062 |
 |
AN ANALYSIS OF SOME PRINCIPLES AND TECHNIQUES OF TEACHING AS APPLIED IN PUBLIC HEALTH NURSING SERVICE. |
FREEMAN, RUTH BENSON |
|
| 1063 |
 |
Akademisch ausgebildetes Pflegefachpersonal: Entwicklung und Chancen [1 ed.] |
Anke Simon (eds.) |
1 |
| 1064 |
 |
Demonstrating Your Clinical Competence in Cardiovascular and Neurological Conditions |
Chambers, Ruth, Ellis, Simon, Higgs, Jane, Wakley, Gill |
|
| 1065 |
 |
Medical Terminology Made Easy: The Easy-to-Follow Guide to Mastering Terminology for Nursing and Healthcare Professionals. Quickly Learn How to Memorize and Understand Medical Terms |
Simon Grace |
|
| 1066 |
 |
Medicines Management for Nurses at a Glance (At a Glance [1 ed.] |
Simon Young, Ben Pitcher |
1 |
| 1067 |
 |
A Nurse at the Front: The Great War Diaries of Sister Edith Appleton. Edited by Ruth Cowen |
Appleton, Edith, Cowen, Ruth |
|
| 1068 |
 |
Becoming a Nurse |
Sonny Kleinfield |
|
| 1069 |
 |
Nightingale’s Nuns and the Crimean War |
Terry Tastard |
|
| 1070 |
 |
The Roy Adaptation Model in Action |
Justus Akinsanya, Greg Cox, Carol Crouch, Lucy Fletcher |
|
| 1071 |
 |
Social Theory and Nursing Practice |
Sam Porter |
|
| 1072 |
 |
Becoming a Midwife: A Student Guide |
Ellie Durant |
|
| 1073 |
 |
Nursing Models and Nursing Practice |
Peter Aggleton, Helen Chalmers |
|
| 1074 |
 |
Writing for Nursing and Midwifery Students [4 ed.] |
Julio Gimenez |
4 |
| 1075 |
 |
Instructor's Guide for Fundamentals of Nursing: Concepts, Process, and Practice, 5th Edition [5 ed.] |
Audrey Berman |
5 |
| 1076 |
 |
Medically speaking: a dictionary of quotations on dentistry, medicine, and nursing [1st ed.] |
Carl C. Gaither, Alma E. Cavazos-Gaither, Andrew Slocombe |
1 |
| 1077 |
 |
Dr. Nurse: Science, Politics, and the Transformation of American Nursing |
Dominique A. Tobbell |
|
| 1078 |
 |
Beyond Caring: Hospitals, Nurses, and the Social Organization of Ethics |
Daniel F. Chambliss |
|
| 1079 |
 |
Key Nursing Skills [1 ed.] |
Barbara Workman, Clare Bennet |
1 |
| 1080 |
 |
Nursing Professionals: A Practical Career Guide |
Kezia Endsley |
|
| 1081 |
 |
Research methods for nursing and healthcare [1 ed.] |
John Maltby, et al |
1 |
| 1082 |
 |
NCLEX-RN Exam Prep [2nd Edition] |
Wilda Rinehart, Diann Sloan, Clara Hurd |
2 |
| 1083 |
 |
NCLEX-PN Practice Questions Exam Cram, 3rd Edition [3 ed.] |
Wilda Rinehart, Diann Sloan, Clara Hurd |
3 |
| 1084 |
 |
Therapeutic Relationships with Offenders: An Introduction to the Psychodynamics of Forensic Mental Health Nursing (Forensic Focus) [1 ed.] |
Anne Aiyegbusi, Jenifer Clarke-Moore |
1 |
| 1085 |
 |
The Pearson Guide to B.Sc. Nursing Entrance Examination [3 ed.] |
Dr Saroj Parwez |
3 |
| 1086 |
 |
A companion to the Overseas Nurses Programme |
Jackie Hulse |
|
| 1087 |
 |
Who cared for the carers?: A history of the occupational health of nurses, 1880–1948 |
Deborah Palmer |
|
| 1088 |
 |
Genetics for Nurses |
V. Deepa Parvathi |
|
| 1089 |
 |
The Path to Building a Successful Nursing Career [1st ed.] |
Jennifer M. Manning |
1 |
| 1090 |
 |
Maternal & child nursing care [5 ed.] |
Marcia L London, Patricia W Ladewig, Michele Davidson, Jane W Ball, Ruth C Bindler, Kay Cowen |
5 |
| 1091 |
 |
English For Nurses |
Nitin Bhatnagar |
|
| 1092 |
 |
One hundred years of wartime nursing practices, 1854–1953 |
Jane Brooks, Christine Hallett (editors) |
|
| 1093 |
 |
Evidence-Based Practice in Dementia for Nurses and Nursing Students |
Karen Harrison Dening, |
|
| 1094 |
 |
NCLEX®-PN Exam Prep [2 ed.] |
Wilda Rinehart, Diann Sloan, Clara Hurd |
2 |
| 1095 |
 |
Legal Aspects of Nursing [Reprint ed.] |
Bridgit Dimond |
|
| 1096 |
 |
The Moulster and Griffiths Learning Disability Nursing Model |
Gweneth Moulster,Jane Iorizzo,Sarah Ames,Joshua Kernohan, |
|
| 1097 |
 |
Microbiology for Nurses |
V. Deepa Parvathi, R. Sumitha, S. Smitha |
|
| 1098 |
 |
Strategies for theory construction in nursing [5. ed] |
Walker, Lorraine Olszewski,Avant, Kay Coalson |
5 |
| 1099 |
 |
Histories of nursing practice |
Gerard Fealy, Christine E. Hallet, Susanne Dietz (editors) |
|
| 1100 |
 |
Skills for nursing and healthcare students : study skills, maths, and science, 2nd ed. [Second ed.] |
Lori K. Garrett, Ailsa Clarke, Pearl Shihab |
2 |
| 1101 |
 |
Making Sense of Spirituality in Nursing And Health Care Practice: An Interactive Approach 2nd Edition [2 ed.] |
Wilfred McSherry |
2 |
| 1102 |
 |
Kozier and Erb's Fundamentals of Nursing: Concepts, Process, and Practice (Australian Edition) [3 vols., 5 ed.] |
Nicole Harvey, Barbara Kozier, Geralyn Frandsen, Flora Rolf, Audrey Berman, Tanya Langtree, Tracy Levett-Jones, Trudy Dwyer, Majella Hales, Adam Burston, Kerry Reid-Searl, Glenora Lea Erb, David Stanley, Shirlee Snyder, Lorna Moxham |
5 |
| 1103 |
 |
Nurse Writers of the Great War |
Christine Hallett |
|
| 1104 |
 |
NCLEX-PN Exam Prep (2nd Edition) [2 ed.] |
Wilda Rinehart, Diann Sloan, Clara Hurd |
2 |
| 1105 |
 |
Community Health Nursing - A Canadian Perspective [5 ed.] |
Lynnette Leeseberg Stamler, Lucia Yiu, Aliyah Dosani, Josephine Etowa, Cheryl van Daalen-Smith |
5 |
| 1106 |
 |
Biochemistry for Nurses |
Uma Bhardwaj, Ravindra Bhardwaj |
|
| 1107 |
 |
African nurses and everyday work in twentieth-century Zimbabwe |
Clement Masakure |
|
| 1108 |
 |
Introducing Research and Evidence-Based Practice for Nurses [1 ed.] |
Jeremy Jolley |
1 |
| 1109 |
 |
Colonial Caring: A History of Colonial and Post-colonial Nursing |
Helen M. Sweet, Sue Hawkins (eds.) |
|
| 1110 |
 |
Beyond Nightingale: Nursing on the Crimean War battlefields |
Carol Helmstadter |
|
| 1111 |
 |
Nursing Student's Clinical Survival Guide [5 ed.] |
Kerry Reid-Searl, Trudy Dwyer, Lorna Moxham |
5 |
| 1112 |
 |
Get Ready for A& P for Nursing and Healthcare |
Lori Garrett, Ailsa Clarke, Pearl Shihab |
|
| 1113 |
 |
NCLEX-PN [5th ed.] |
Hurd, Clara, Rinehart Gardner, Wilda, Sloan, Diane |
5 |
| 1114 |
 |
Nclex-RN practice questions [5th ed.] |
Hurd, Clara, Rinehart, Wilda, Sloan, Diann |
5 |
| 1115 |
 |
Therapeutic Interventions for Forensic Mental Health Nurses (Forensic Focus, 19) [1 ed.] |
Mick Collins, Phil Woods, Alyson Kettles |
1 |
| 1116 |
 |
Negotiating nursing: British Army sisters and soldiers in the Second World War |
Jane Brooks |
|
| 1117 |
 |
Pharmacology for Nurses: A Pathophysiologic Approach [3rd Edition] |
Michael Patrick Adams, Leland Norman Holland, Carol Q. Urban |
3 |
| 1118 |
 |
War Girls: The First Aid Nursing Yeomanry in the Great War |
Janet Lee |
|
| 1119 |
 |
Ellen N. La Motte: Nurse, writer, activist |
Lea Williams |
|
| 1120 |
 |
Nursing & health cardiopulmonary resuscitation survival guide |
Godson, Nina |
|
| 1121 |
 |
Sociology for Nurses [2 ed.] |
I. Clement |
2 |
| 1122 |
 |
What Makes a Good Nurse: Why the Virtues Are Important for Nurses [1 ed.] |
Derek Sellman |
1 |
| 1123 |
 |
Leadership for person-centred dementia care |
Buz Loveday |
|
| 1124 |
 |
Nurse Writers of the Great War [1 ed.] |
Christine E. Hallett |
1 |
| 1125 |
 |
Florence Nightingale: A Reference Guide to Her Life and Works |
Lynn McDonald |
|
| 1126 |
 |
CNA Certified Nursing Assistant Exam Cram [1 ed.] |
Linda Whitenton, Marty Walker |
1 |
| 1127 |
 |
Communication and Nursing Education |
Anurag Bhai Patidar |
|
| 1128 |
 |
Introducing Psychology for Nurses & Healthcare Professionals |
Dominic Upton |
|
| 1129 |
 |
Complete Companion for B.Sc Nursing and GNM (General Nursing and Midwifey) Entrance Examination, 3rd Edition [3 ed.] |
Saroj Parwez |
3 |
| 1130 |
 |
Numeracy in nursing and healthcare : calculations and practice |
Pearl Shihab |
|
| 1131 |
 |
Bodies and souls: politics and the professionalization of nursing in France, 1880-1922 |
Katrin Schultheiss |
|
| 1132 |
 |
Nurses and Nursing [Reprint 2014 ed.] |
Alfred Worcester |
2014 |
| 1133 |
 |
El Libro Esencial para Madres Lactantes |
Kathleen Huggins |
|
| 1134 |
 |
Nursing Mother, Working Mother |
Gale Pryor, Kathleen Huggins |
|
| 1135 |
 |
Critical Pedagogy in Nursing: Transformational Approaches to Nurse Education in a Globalized World [1 ed.] |
Sue Dyson (auth.) |
1 |
| 1136 |
 |
Complementary Medicine: for Nurses, Midwives and Health Visitors |
Joanna Trevelyan, Brian Booth (auth.) |
|
| 1137 |
 |
Achieving Quality in Community Health Care Nursing |
Carolyn Mason RGN, RHV, RNT, BA, PhD (eds.) |
|
| 1138 |
 |
Formulation in Mental Health Nursing [2024 ed.] |
Vickie Howard (editor), Lolita Alfred (editor) |
2024 |
| 1139 |
 |
Redesigning the Nursing and Human Resource Partnership: A Model for the New Normal Era |
Yupin Aungsuroch, Joko Gunawan, Mary L. Fisher |
|
| 1140 |
 |
Calculations for Nursing and Healthcare |
Diana Coben, Elizabeth Atere-Roberts (auth.) |
|
| 1141 |
 |
Porth’s Pathophysiology: Concepts of Altered Health States [10 ed.] |
Tommie L Norris, Rupa Lalchandani |
10 |
| 1142 |
 |
Cancer Nursing: A Revolution in Care |
A. Phylip Pritchard (eds.) |
|
| 1143 |
 |
Theory for Midwifery Practice |
Rosamund M. Bryar (auth.) |
|
| 1144 |
 |
Towards a Sociology of Nursing [1st ed. 2020] |
Ricardo A. Ayala |
1 |
| 1145 |
 |
Towards a Sociology of Nursing |
Ricardo A. Ayala |
|
| 1146 |
 |
On Radji Beach: The Story of the Australian Nurses after the Fall of Singapore |
Ian W. Shaw |
|
| 1147 |
 |
Nurse Practitioners and the Performance of Professional Competency : Accomplishing Patient-centered Care [1 ed.] |
Staci Defibaugh (auth.) |
1 |
| 1148 |
 |
The psychology of nursing care |
Neil Niven, Jill Robinson (auth.) |
|
| 1149 |
 |
Nursing, Policy and Politics in Twentieth-century Chile: Reforming Health, 1920s-1990s [1 ed.] |
Markus Thulin, Ricardo A. Ayala |
1 |
| 1150 |
 |
Writing for Nursing and Midwifery Students [3 ed.] |
Julio Gimenez |
3 |
| 1151 |
 |
A Caring Life: What fifty years in nursing has taught me about humanity, compassion and community |
Keith Cox |
|
| 1152 |
 |
The Midwife's Sister: The Story of Call The Midwife's Jennifer Worth by her sister Christine |
Christine Lee |
|
| 1153 |
 |
The Nursing Profession and the Marriage Bar: Crisp White Uniform |
Breda McTaggart |
|
| 1154 |
 |
A Nurse's Story: My Life in A&E During the Covid Crisis |
Louise Curtis |
|
| 1155 |
 |
Advancing Nursing Practice in Cancer and Palliative Care |
David Clarke, Jean Flanagan, Kevin Kendrick (eds.) |
|
| 1156 |
 |
Both Sides of Selection: Finding and filling jobs in nursing and the health services |
Martin Edis (auth.) |
|
| 1157 |
 |
What Next?: Post-basic Opportunities for Nurses |
Jill Baker (auth.) |
|
| 1158 |
 |
The Social Construction of Community Nursing |
Anne Kelly, Anthea Symonds (auth.) |
|
| 1159 |
 |
Challenges in clinical practice : professional developments in nursing |
edited by Veronica Bishop and Irene Scott. |
|
| 1160 |
 |
Florence Nightingale at Home [1st ed.] |
Paul Crawford, Anna Greenwood, Richard Bates, Jonathan Memel |
1 |
| 1161 |
 |
Nurse Memoirs from the Great War in Britain, France, and Germany (Palgrave Studies in Literature, Science and Medicine) [1st ed. 2021] |
Jerry Palmer |
1 |
| 1162 |
 |
The Roy Adaptation Model in Action |
Justus Akinsanya BSc, PhD, RN, ONC, BTA(Cert), RNT, FRCN, FWACN, FRSH, Greg Cox RN, RNT, DipN(Lond), RCNT(CertEd), Carol Crouch BA, RN, RCNT, RNT(CertEd), Lucy Fletcher RN, DipN(Lond), RNT(CertEd(FE)) (auth.) |
|
| 1163 |
 |
The Roper-Logan-Tierney Model in Action |
Charleen Newton RGN, Dip.Nursing (Lond.) (auth.) |
|
| 1164 |
 |
Aspects of Midwifery Practice: A research-based approach |
Jo Alexander, Valerie Levy, Sarah Roch (eds.) |
|
| 1165 |
 |
Caring and Communicating: Facilitators’ Manual: The Interpersonal Relationship in Nursing |
Paul Morrison, Philip Barnard (auth.) |
|
| 1166 |
 |
A Thumbnail Sketch of Theatre Nursing |
Jennifer Ann Morris SRN, SCM (auth.) |
|
| 1167 |
 |
Caring for Older People: A Nurse’s Guide |
Mary Carroll RN, C, MA, L. Jane Brue RN, M.Ed., MSN (auth.), Brian Booth RGN (eds.) |
|
| 1168 |
 |
Nursing in Today's World - Trends, Issues, and Management (10th Ed) |
Janice Rider Ellis ,Celia Love Hartley |
|
| 1169 |
 |
Pediatric palliative care |
Hospice and Palliative Nurses Association,Ferrell, Betty |
|
| 1170 |
 |
Physical Aspects of Care: Nutritional, Dermatologic, Neurologic and Other Symptoms (HPNA Palliative Nursing Manuals) |
Paice, Judith A(Editor) |
|
| 1171 |
 |
Critical Thinking and the Process of Evidence-Based Practice |
Eileen Gambrill |
|
| 1172 |
 |
Oxford textbook of palliative nursing [Fifth edition] |
Ferrell, Betty, Paice, Judith A |
5 |
| 1173 |
 |
Oxford handbook of critical care nursing [2 ed.] |
Heather Baid, Fiona Creed, Jessica Hargreaves, Sheila K. Adam |
2 |
| 1174 |
 |
Oxford handbook of learning and intellectual disability nursing [Second ed.] |
Bob Gates (editor), Owen Barr (editor) |
2 |
| 1175 |
 |
A Dictionary of Nursing [8th Edition] |
Jonathan Law, Tanya A. McFerran |
8 |
| 1176 |
 |
Oxford English for Careers: Nursing 1: Oxford English for Careers: Nursing: ELT Level 1: Pre-Intermediate: Student's Book [Student ed.] |
Tony Grice |
|
| 1177 |
 |
Managing death in the ICU : the transition from cure to comfort |
J Randall Curtis, Gordon D Rubenfeld |
|
| 1178 |
 |
The Nature of Suffering and the Goals of Nursing [1 ed.] |
Betty R. Ferrell, Nessa Coyle |
1 |
| 1179 |
 |
Oxford Textbook of Palliative Nursing, Third Edition [3 ed.] |
Betty R. Ferrell, Nessa Coyle |
3 |
| 1180 |
 |
This Birth Place of Souls: The Civil War Nursing Diary of Harriet Eaton |
Jane E. Schultz |
|
| 1181 |
 |
Overcoming Secondary Stress in Medical and Nursing Practice [2 ed.] |
Robert J. Wicks |
2 |
| 1182 |
 |
Advanced Practice Palliative Nursing [2 ed.] |
Constance Dahlin, Patrick Coyne |
2 |
| 1183 |
 |
The Nature of Suffering and the Goals of Nursing [2 ed.] |
William E. Rosa (editor), Betty R. Ferrell (editor) |
2 |
| 1184 |
 |
Oxford Handbook of Children's and Young People's Nursing [1 ed.] |
Edward Alan Glasper, Gillian McEwing, Jim Richardson |
1 |
| 1185 |
 |
Oxford handbook of mental health nursing [Second edition] |
Callaghan, Patrick, Gamble, Catherine |
2 |
| 1186 |
 |
Oxford handbook of critical care nursing [Second edition] |
Adam, Sheila K.,Baid, Heather,Creed, Fiona,Hargreaves, Jessica |
2 |
| 1187 |
 |
Oxford Handbook of Adult Nursing [2 ed.] |
Maria Flynn, Dave Mercer |
2 |
| 1188 |
 |
Oxford Handbook of Primary Care and Community Nursing (Oxford Handbooks in Nursing) [3 ed.] |
Judy Brook (editor), Caroline McGraw (editor), Val Thurtle (editor) |
3 |
| 1189 |
 |
Oxford Handbook of Neuroscience Nursing [2 ed.] |
Catheryne Waterhouse, Sue Woodward |
2 |
| 1190 |
 |
Oxford Handbook of Gastrointestinal Nursing [2 ed.] |
Jennie Burch, Brigitte Collins |
2 |
| 1191 |
 |
Oxford Handbook of Respiratory Nursing [2 ed.] |
Terry Robinson, Jane Scullion |
2 |
| 1192 |
 |
A Dictionary of Nursing (Oxford Quick Reference) [8 ed.] |
Jonathan Law (editor) |
8 |
| 1193 |
 |
Oxford Handbook of Respiratory Nursing [1 ed.] |
Terry Robinson, Jane Scullion |
1 |
| 1194 |
 |
Oxford Handbook of Gastrointestinal Nursing [1 ed.] |
Christine Norton, Annmarie Nunwa, Claire Taylor, Kathy Whayman, Julia Williams |
1 |
| 1195 |
 |
Oxford Textbook of Palliative Nursing [Hardcover ed.] |
Betty R. Ferrell, Nessa Coyle, Judith A. Paice |
|
| 1196 |
 |
Saving Lives: Why the Media's Portrayal of Nursing Puts Us All at Risk [Updated Edition] |
Sandy Summers, Harry Jacobs Summers |
|
| 1197 |
 |
Saving lives : why the media's portrayal of nursing puts us all at risk [Updated second edition] |
Summers, Sandy, Summers, Harry Jacobs |
2 |
| 1198 |
 |
Caring matters most : the ethical significance of nursing [1 ed.] |
Lazenby, Mark |
1 |
| 1199 |
 |
Fundamentals of Mental Health Nursing |
Victoria Clarke, Andrew Walsh |
|
| 1200 |
 |
Care of the Acutely Ill Adult: An essential guide for nurses [1 ed.] |
Fiona Creed, Christine Spiers |
1 |
| 1201 |
 |
Oxford Handbook of Midwifery [2 ed.] |
Janet Medforth, Sue Battersby, Maggie Evans, Beverley Marsh, Angela Walker |
2 |
| 1202 |
 |
Oxford handbook of surgical nursing |
Kisiel, Maria,Radford, Mark,Smith, Alison |
|
| 1203 |
 |
Oxford handbook of surgical nursing [First edition] |
Kisiel, Maria, Radford, Mark, Smith, Alison |
|
| 1204 |
 |
Oxford handbook of primary care and community nursing [2nd edition] |
Drennan, Vari, Goodman, Claire |
2 |
| 1205 |
 |
Oxford Handbook of Emergency Nursing [2 ed.] |
Robert Crouch OBE, Alan Charters, Mary Dawood, Paula Bennett |
2 |
| 1206 |
 |
Nursing OSCEs : A Complete Guide to Exam Success |
Catherine Caballero, Fiona Creed, Clare Gochmanski, Jane Lovegrove |
|
| 1207 |
 |
Adult Nursing Practice: Using Evidence in Care |
Ian Bullock, Jill Macleod Clark, Joanne Rycroft-Malone |
|
| 1208 |
 |
Communication in Palliative Nursing [1 ed.] |
Elaine Wittenberg-Lyles, Joy Goldsmith, Betty Ferrell, Sandra L. Ragan |
1 |
| 1209 |
 |
Integrative Nursing [1 ed.] |
Mary Jo Kreitzer, Mary Koithan |
1 |
| 1210 |
 |
Physical Examination Procedures for Advanced Nurses and Independent Prescribers: Evidence and Rationale [1 ed.] |
Zoe Rawles, Beth Griffiths, Trudy Alexander |
1 |
| 1211 |
 |
Nursing and healthcare research at a glance |
Glasper, Edward Alan,Rees, Colin |
|
| 1212 |
 |
Ethics in Nursing 3rd Edition [3 ed.] |
Martin Benjamin, Joy Curtis |
3 |
| 1213 |
 |
Overcoming Secondary Stress in Medical and Nursing Practice: A Guide to Professional Resilience and Personal Well-Being [1 ed.] |
Robert J. Wicks |
1 |
| 1214 |
 |
Cultural Awareness in Nursing and Health Care, 2nd edition: An Introductory Text [2 ed.] |
Karen Holland, Christine Hogg |
2 |
| 1215 |
 |
Oxford Dictionary of Nursing |
Rosalind Fergusson, Elizabeth Martin, Anne Stibb, editors |
|
| 1216 |
 |
2018 Nurse’s Drug Handbook [17th ed.] |
Jones And Bartlett |
17 |
| 1217 |
 |
2021 Nurse's Drug Handbook [12 ed.] |
Jones &, Bartlett Learning |
12 |
| 1218 |
 |
2022 Nurse's Drug Handbook [21 ed.] |
Jones &, Bartlett Learning |
21 |
| 1219 |
 |
2015 Nurse’s Drug Handbook [14 ed.] |
Ismail Aw-Abdi |
14 |
| 1220 |
 |
A Guide for International Nursing Students in Australia and New Zealand |
Bernadette Hally |
|
| 1221 |
 |
A Matter of Life and Death: Courage, compassion and the fight against coronavirus - a palliative care nurse's story |
Kelly Critcher |
|
| 1222 |
 |
AACN Procedure Manual for High Acuity, Progressive, and Critical Care [7 ed.] |
Debra L. Wiegand |
7 |
| 1223 |
 |
A Textbook of Children's and Young People's Nursing [3 ed.] |
Edward Alan Glasper, James Richardson, Dr Duncan Randall |
3 |
| 1224 |
 |
Ackley y Ladwig. Manual de Diagnósticos de Enfermería: Guía para la planificación de cuidados [13 ed.] |
Mary Beth Flynn Makic, Marina Reyna Martinez-Kratz |
13 |
| 1225 |
 |
AACN Protocols for Practice: Noninvasive Monitoring, [2 ed.] |
Suzanne M. Burns |
2 |
| 1226 |
 |
ACCCN's Critical Care Nursing [3 ed.] |
Leanne Aitken, Andrea Marshall, Wendy Chaboyer |
3 |
| 1227 |
 |
Administración de citostáticos e inmunoterapia en pediatría: Cuidados de enfermería |
Cristina Pérez Conesa, Elena Nogales Torres |
|
| 1228 |
 |
Advanced health assessment and diagnostic reasoning [Third edition.] |
Petersen, Sandra Wiggins, Rhoads, Jacqueline |
3 |
| 1229 |
 |
Advanced Nursing Research: From Theory to Practice [3 ed.] |
Ruth M. Tappen |
3 |
| 1230 |
 |
Advanced Practice Nursing: Essential Knowledge for the Profession [5 ed.] |
Susan M. Denisco |
5 |
| 1231 |
 |
Applied Clinical Informatics for Nurses [Paperback ed.] |
Susan Alexander |
|
| 1232 |
 |
Aplicación de las Ciencias psicosociales al ámbito del cuidar [1ª ed., 1ª imp] |
Genoveva Granados Gámez |
1 |
| 1233 |
 |
Applied Clinical Informatics for Nurses(2019, 2nd Ed) [2 ed.] |
Susan Alexander, Karen H. Frith, Haley Hoy |
2 |
| 1234 |
 |
Applied Pathophysiology for the Advanced Practice Nurse [1st ed.] |
Lucie Dlugasch, Lachel Story |
1 |
| 1235 |
 |
Applied Pathophysiology for the Advanced Practice Nurse [2 ed.] |
Lucie Dlugasch, Lachel Story |
2 |
| 1236 |
 |
Australian Nurses' Dictionary [6 ed.] |
Jennie King, Rhonda Hawley |
6 |
| 1237 |
 |
Autoevaluación en enfermería médico-quirúrgica: Test razonados para la preparación del acceso por vía excepcional al título de especialista |
Juan Luis Soto de Lanuza |
|
| 1238 |
 |
Autoevaluación en enfermería: Test razonados para la preparación de oposiciones en el Estado español |
Juan Luis Soto de Lanuza, Pilar San José Lobo, Beatriz Salazar Guerra, Enrique Galiano Sierra, Elena Collado Sánchez |
|
| 1239 |
 |
Baillière's Dictionary for Nurses and Health Care Workers [27 ed.] |
Jayne Taylor |
27 |
| 1240 |
 |
Bailliere's Nurses Dictionary for Nurses and Health Care Workers, 1st South Asia Edition |
Annu Kaushik |
|
| 1241 |
 |
Bailliere's Nurses Dictionary for Nurses and Health Care Workers, 1st South Asia Edition [1 ed.] |
Annu Kaushik |
1 |
| 1242 |
 |
Basic Steps in Planning Nursing Research: From Question to Proposal, Seventh Edition [7th ed.] |
Marilynn J. Wood, Janet Ross-Kerr |
7 |
| 1243 |
 |
Becoming a Nurse Educator: Dialogue for an Engaging Career [1 ed.] |
CeCelia R. Zorn |
1 |
| 1244 |
 |
Breastfeeding Management for the Clinician: Using the Evidence [1 ed.] |
Marsha Walker |
1 |
| 1245 |
 |
Breastfeeding and Human Lactation [6 ed.] |
Karen Wambach, Becky Spencer |
6 |
| 1246 |
 |
Breastfeeding and human lactation [3rd ed] |
Jan Riordan |
3 |
| 1247 |
 |
Brown's Evidence-Based Nursing: The Research-Practice Connection [5 ed.] |
Emily W. Nowak, Renee Colsch |
5 |
| 1248 |
 |
Building a Legacy: Voices of Oncology Nurses (Jones and Bartlett Series in Oncology) [1st ed.] |
Nevidjon |
1 |
| 1249 |
 |
Cadre De Santé De Proximité. Un metier au coeur du soin. Penser une ethique du quotidien des soins [ELSEVIER-MASSON ed.] |
Walter Hesbeen (Auth.) |
|
| 1250 |
 |
Calculs de doses en 550 exercices corrigés - Pour les 3 années du Diplôme d'Etat infirmier.: + Les tutos ! Pour visualiser la pratique [4 ed.] |
Jérôme Chevillotte, Catherine Muller |
4 |
| 1251 |
 |
Cancer Chemotherapy: A Nursing Process Approach (Jones and Bartlett Series in Nursing) [2nd ed.] |
Margaret Barton-Burke, Gail M. Wilkes, Karen C. Ingwersen, Catherine K. Bean, Deborah Berg |
2 |
| 1252 |
 |
Cancer Nursing: Principles and Practice, Seventh Edition [7 ed.] |
Connie Henke Yarbro, Debra Wujcik, Barbara Holmes Gobel |
7 |
| 1253 |
 |
Cancer Nursing: Principles And Practice [7 ed.] |
Connie Henke Yarbro, Debra Wujcik, Barbara Holmes Gobel |
7 |
| 1254 |
 |
Calculating Drug Doses Safely [2 ed.] |
George Downie, Jean Mackenzie, Arthur Williams |
2 |
| 1255 |
 |
Cancer Nursing: Principles and Practice [4th ed.] |
Margaret Hansen Frogge, Michelle Goodman, Connie Henke Yarbro, Susan L. Groenwald, Margaret Hansen Frogge, Michelle Goodman, Connie Henke Yarbro, Susan L. Groenwald |
4 |
| 1256 |
 |
Care of Communities: Community Health Nursing |
Florida International University |
|
| 1257 |
 |
Caring and Nursing: Explorations in Feminist Perspectives |
Ruth Neil, Robin Watts |
|
| 1258 |
 |
Case Studies in Nurse Anesthesia [1 ed.] |
Sass Elisha |
1 |
| 1259 |
 |
Caring for the Vulnerable: Perspectives in Nursing Theory, Practice, and Research [5 ed.] |
Mary De Chesnay, Barbara A. Anderson |
5 |
| 1260 |
 |
Cardiac Arrhythmias, An Issue of Critical Care Nursing Clinics of North America |
Mary G. Carey |
|
| 1261 |
 |
Certification and Core Review for Neonatal Intensive Care Nursing [5 ed.] |
Robin L. Watson, Beth Diehl |
5 |
| 1262 |
 |
Chemotherapy Care Plans Handbook |
Margaret Barton Burke, Gail M. Wilkes, Karen C. Ingwersen |
|
| 1263 |
 |
Chronic illness & disability: principles for nursing practice [2 ed.] |
Esther Chang, Amanda Johnson |
2 |
| 1264 |
 |
Clinical Nursing Calculations, 3e [3 ed.] |
Susan Sienkiewicz, Sandra Megerdichian |
3 |
| 1265 |
 |
Clinical Companion for Fundamentals of Nursing: Active Learning for Collaborative Practice [2 ed.] |
Barbara L Yoost, Lynne R Crawford, Patricia Castaldi |
2 |
| 1266 |
 |
Clinical Nurse Leaders Beyond the Microsystem: A Practical Guide |
James L. Harris, Linda A. Roussel, Patricia L. Thomas |
|
| 1267 |
 |
Collins-Bride & Saxe's Clinical Guidelines for Advanced Practice Nursing [4 ed.] |
Yoonmee Joo, J. V. Gatewood, Mary Anne M. Israel, Kelly Wong McGrath |
4 |
| 1268 |
 |
Communication in Nursing [8 ed.] |
Julia Balzer Riley |
8 |
| 1269 |
 |
Comprehensive Lactation Consultant Exam Review [4 ed.] |
Linda J. Smith |
4 |
| 1270 |
 |
Compendio de neuromonitoría para enfermería |
Graciela Aguilar Fajardo, Margarita María Pomar Hoyos, Martha Liliana Maldonado Gutiérrez |
|
| 1271 |
 |
Concours IBODE - Annales corrigées et accès VAE: Devenir infirmier de bloc opératoire |
|
|
| 1272 |
 |
Contemporary Health Promotion In Nursing Practice [1 Pap/Psc ed.] |
Bonnie Raingruber |
1 |
| 1273 |
 |
Core Curriculum for Interdisciplinary Lactation Care [1 ed.] |
Lactation Education Accreditation and Approval Review Committee (LEAARC), Suzanne Hetzel Campbell, Judith Lauwers, Rebecca Mannel |
1 |
| 1274 |
 |
Counseling the Nursing Mother: A Lactation Consultant's Guide, Fifth Edition [5th ed.] |
Judith Lauwers, Anna Swisher |
5 |
| 1275 |
 |
Critical Thinking, Clinical Reasoning, and Clinical Judgement [7 ed.] |
Rosalinda Alfaro-Lefevre |
7 |
| 1276 |
 |
Cultural Competencies For Nurses: Impact On Health And Illness [1 ed.] |
Linda Dayer-Berenson |
1 |
| 1277 |
 |
Deutsch A2/B1 in der Pflege |
Sarah Micucci, Helga Würtz |
|
| 1278 |
 |
Deutsch B 1 in der Pflege [4 ed.] |
Ingrid Peikert |
4 |
| 1279 |
 |
Deutsch B1/B2 in der Pflege: Für Fachkräfte im Anerkennungsverfahren [3 ed.] |
Melanie Böck, Hans-Heinrich Rohrer |
3 |
| 1280 |
 |
Deutsch für die Altenpflege: Arbeitsbuch für Migrantlnnen |
Ingrid Peikert |
|
| 1281 |
 |
Diagnostics Infirmiers, Interventions et Résultats. Classifications infirmiéres et plans de soins [ELSEVIER-MASSON ed.] |
Annie Pascal and Éliane Frécon Valentin (Auth.) |
|
| 1282 |
 |
Dimensional Analysis For Meds: Refocusing On Essential Metric Calculations |
Anna M. Curren |
|
| 1283 |
 |
Educating Nurses: A Call for Radical Transformation |
Patricia Benner, Molly Sutphen, Victoria Leonard, Lisa Day, Lee S. Shulman |
|
| 1284 |
 |
El diagnóstico psicosocial desde una perspectiva enfermera [1 ed.] |
Pedro RuymÁn Brito Brito, Armando Aguirre Jaime |
1 |
| 1285 |
 |
Emergencies Only: A Nurse's Journey Through Natural Disasters, Extreme Poverty, Civil Wars and General Chaos |
Amanda McClelland |
|
| 1286 |
 |
Emergency and Trauma Care for Nurses and Paramedics (Australian and New Zealand Edition) [2 ed.] |
Kate Curtis, Clair Ramsden |
2 |
| 1287 |
 |
Emotionally Intelligent Nurse Leader [1 ed.] |
Mae Taylor Moss |
1 |
| 1288 |
 |
Emergencies only: an Australian nurse's journey through natural disasters, extreme poverty, civil wars and general chaos |
McClelland, Amanda |
|
| 1289 |
 |
English for Nurses [2 ed.] |
Shama Lohumi |
2 |
| 1290 |
 |
Epidemiology for Advanced Nursing Practice [1 ed.] |
Dr. Kiran Macha, Dr. John P. McDonough |
1 |
| 1291 |
 |
Essentials of perioperative nursing [Sixth edition.] |
Terri Goodman, Cynthia Spry |
6 |
| 1292 |
 |
Essentials of Psychiatric Mental Health Nursing: A Communication Approach to Evidence-Based Care [4 ed.] |
Elizabeth M. Varcarolis, Chyllia D Fosbre |
4 |
| 1293 |
 |
Essentials of medical genetics for nursing and health professionals : an interprofessional approach |
Gunder McClary, Laura M. |
|
| 1294 |
 |
Ethel Gordon Fenwick: Nursing Reformer and the First Registered Nurse |
Jenny Main |
|
| 1295 |
 |
Evidence-based nursing: The research practice connection [4 ed.] |
Brown, Sarah Jo |
4 |
| 1296 |
 |
Evidence-Based Practice for Nurses: Appraisal and Application of Research [4 ed.] |
Nola A. Schmidt, Janet M. Brown |
4 |
| 1297 |
 |
Evidence-Based Nursing: The Research Practice Connection [4th ed.] |
Sarah Jo Brown |
4 |
| 1298 |
 |
Fiches de soins infirmiers. Avec site Internet [5e édition ed.] |
Eggers, Jérôme, Hallouët, Pascal, Malaquin-Pavan, Evelyne |
5 |
| 1299 |
 |
Fiches de soins infirmiers [3e éd ed.] |
Pascal Hallouët, Jérôme Eggers, Évelyne Malaquin-Pavan |
3 |
| 1300 |
 |
Fluids and Electrolytes, An Issue of Nursing Clinics |
Joshua Squiers |
|
| 1301 |
 |
Florence Nightingale at First Hand: Vision, Power, Legacy |
Lynn McDonald |
|
| 1302 |
 |
Fundamentals of nursing research [2nd ed.] |
Dorothy Young Brockopp, Marie T. Hastings-Tolsma |
2 |
| 1303 |
 |
Fundamentos de enfermería práctica [4 ed.] |
Sheila A. Sorrentino, Leighann Remmert, Bernie Gorek |
4 |
| 1304 |
 |
Gerontological Nursing : Competencies for Care [1 ed.] |
Kristen L. Mauk (Editor) |
1 |
| 1305 |
 |
Gerontological Nursing: Competencies For Care [2 ed.] |
Kristen L. Mauk |
2 |
| 1306 |
 |
Gerontological Nursing: Competencies for Care [3 ed.] |
Kristen L. Mauk |
3 |
| 1307 |
 |
Geropsychiatric and Mental Health Nursing [2nd ed] |
K. Melillo, S. Houde |
2 |
| 1308 |
 |
Gerontological Nursing: Competencies for Care [5 ed.] |
Kristen L. Mauk |
5 |
| 1309 |
 |
Guide Pratique De L'infirmière [ELSEVIER-MASSON ed.] |
Gabriel Perlemuter and Léon Perlemuter (Auth.) |
|
| 1310 |
 |
Guía de supervivencia para enfermería hospitalaria [2 ed.] |
Ann Richards |
2 |
| 1311 |
 |
Hamric & Hanson's Advanced Practice Nursing - E-Book: Hamric & Hanson's Advanced Practice Nursing - E-Book [7 ed.] |
Mary Fran Tracy, Eileen T. O'Grady, Susanne J. Phillips |
7 |
| 1312 |
 |
Handbook of oncology nursing [3nd ed.] |
Bonny L. Johnson, Jody Gross |
3 |
| 1313 |
 |
Handbook of Nursing Diagnosis [16 ed.] |
Lynda Juall Carpenito |
16 |
| 1314 |
 |
Health Policy: Application for Nurses and Other Health Care Professionals [Second edition.] |
Demetrius J. Porche |
2 |
| 1315 |
 |
Health Informatics: An Interprofessional Approach [2 ed.] |
Ramona Nelson, Nancy Staggers |
2 |
| 1316 |
 |
Health Policy: Applications for Nurses and Other Healthcare Professionals [3 ed.] |
Demetrius J. Porche |
3 |
| 1317 |
 |
Health Policy and Politics: A Nurse's Guide [Sixth edition.] |
Jeri A. Milstead |
6 |
| 1318 |
 |
Hematologic Issues in Critical Care, An Issue of Critical Nursing Clinics |
Patricia O’Malley |
|
| 1319 |
 |
Hemodynamic Monitoring |
Mary E. Lough |
|
| 1320 |
 |
Holistic Nursing: A Handbook for Practice [5 ed.] |
Barbara Montgomery Dossey, Lynn, Ph.D. Keegan |
5 |
| 1321 |
 |
Holistic Nursing: A Handbook for Practice [4 ed.] |
Barbara Montgomery Dossey, Lynn Keegan, Cathie E. Guzzetta |
4 |
| 1322 |
 |
Holistic Nursing: A Handbook for Practice, 4th Edition [4 ed.] |
Barbara Montgomery Dossey, Lynn Keegan, Cathie E. Guzzetta |
4 |
| 1323 |
 |
Holistic Nursing: Handbook for Practice [6 ed.] |
Barbara Montgomery Dossey, Lynn Keegan |
6 |
| 1324 |
 |
Indirect care handbook for advanced nursing roles : beyond the bedside |
Zuzelo, Patti Rager |
|
| 1325 |
 |
Infection in the Intensive Care Unit, An Issue of Critical Care Nursing Clinics of North America |
Todd Tartavoulle, Jennifer Manning |
|
| 1326 |
 |
Infirmière en Milieu Scolaire [ELSEVIER-MASSON ed.] |
Valérie Cottin (Auth.) |
|
| 1327 |
 |
Initiation à la démarche de recherche : UE 3.4 |
Boudier, Christiane |
|
| 1328 |
 |
Infirmier en milieu carcéral |
Roch-Étienne Migliorino |
|
| 1329 |
 |
Infection Prevention and Control: Theory and Practice for Healthcare Professionals [1 ed.] |
Debbie Weston |
1 |
| 1330 |
 |
Innovative Teaching Strategies in Nursing and Related Health Professions [8 ed.] |
Martha J. Bradshaw, Beth L. Hultquist, Debra Hagler |
8 |
| 1331 |
 |
Innovative Teaching Strategies in Nursing and Related Health Professions [5 ed.] |
Martha Bradshaw, Arlene Lowenstein |
5 |
| 1332 |
 |
Introduction to Nursing Research: Incorporating Evidence-Based Practice [4th ed.] |
Carol Boswell, Sharon Cannon |
4 |
| 1333 |
 |
Introduction to Nursing Research: Incorporating Evidence-Based Practice [5 ed.] |
Carol Boswell, Sharon Cannon |
5 |
| 1334 |
 |
Introduction to Nursing Research: Incorporating Evidence-Based Practice [6 ed.] |
Carol Boswell, Sharon Cannon |
6 |
| 1335 |
 |
Jarvis Physical Examinattion and Health Assessment [4 Canadian ed.] |
Carolyn Jarvis, Ann Eckhardt |
4 |
| 1336 |
 |
Jarvis's Physical Examination and Health Assessment - INKling |
Helen Forbes, Elizabeth Watt |
|
| 1337 |
 |
L'aide-soignant en Service De Psychiatrie [ELSEVIER-MASSON ed.] |
Marie-Odile Rioufol and Florent Vénuat (Auth.) |
|
| 1338 |
 |
L'aide-soignant en Service De Gériatrie. Soins et besoins affectifs [ELSEVIER-MASSON ed.] |
Marie-Odile Rioufol, Marie-Bernadette Beaulieu and Lucette Holstensson (Auth.) |
|
| 1339 |
 |
Leadership and Nursing Care Management [7 ed.] |
Diane Huber, M. Lindell Joseph |
7 |
| 1340 |
 |
Law for Nurses and Midwives [10 ed.] |
Patricia J Staunton, Mary Chiarella |
10 |
| 1341 |
 |
Le tout en un révisions IFSI |
Laurent Sabbah, et al |
|
| 1342 |
 |
Leading and Managing in Nursing [6 ed.] |
Patricia S. Yoder-Wise |
6 |
| 1343 |
 |
Leifer's Introduction to Maternity & Pediatric Nursing in Canada [2 ed.] |
Lisa Keenan-Lindsay, Gloria Leifer |
2 |
| 1344 |
 |
Leadership for Evidence-Based Innovation in Nursing and Health Professions |
Daniel Weberg, Sandra Davidson, Tim Porter-O'Grady, Kathy Malloch |
|
| 1345 |
 |
Learning Styles and the Nursing Profession [1st ed.] |
Rita Stafford Dunn, Shirley A. Griggs |
1 |
| 1346 |
 |
Les tableaux de pathologies en Ifsi |
Laurence Pitard, Léon Perlemuter, Gabriel Perlemuter |
|
| 1347 |
 |
Les infirmières: identité, spécificité et soins infirmiers |
René Magnon |
|
| 1348 |
 |
L'infirmier(e) et les soins palliatifs [4e éd ed.] |
Société française d'accompagnement et de soins palliatifs. Collège soins infirmiers |
4 |
| 1349 |
 |
Lewis's Medical-Surgical Nursing Australia and New Zealand Edition [4 ed.] |
Di Brown, Helen Edwards, Lesley Seaton, Thomas Buckley |
4 |
| 1350 |
 |
Lilley's Pharmacology for Canadian Health Care Practice [5 ed.] |
Kara Sealock, Cydnee Seneviratne |
5 |
| 1351 |
 |
L'infirmier en Psychiatrie [ELSEVIER-MASSON ed.] |
Morasz (Auth.) |
|
| 1352 |
 |
L'infirmier(e) en néphrologie [3e édition ed.] |
Jean-Paul Fillastre, Association française des infirmier(e)s de dialyse, transplantation et néphrologie |
3 |
| 1353 |
 |
L'infirmier et les soins aux personnes âgées |
Joël Belmin, Francine Amalberti, A -M Béguin, Geneviève Laroque |
|
| 1354 |
 |
L'infirmier(e) en néphrologie. Clinique Pratique et évaluation de la Qualité des Soins [4th Edition] |
AFIDTN (Auth.) |
4 |
| 1355 |
 |
L'observation Aide-soignante. Une collaboration–la demarche de soins et au diagnostic infirmier [ELSEVIER-MASSON ed.] |
Marie-Odile Rioufol (Auth.) |
|
| 1356 |
 |
Los diagnósticos enfermeros : Revisión crítica y guía práctica [9.a edition] |
Luis Rodrigo, María Teresa |
9 |
| 1357 |
 |
Mémo-Fiches AS - Blocs de compétence 1 à 5 + AFGSU: Aide-soignant. Conforme à la réforme. Je réussis mon DEAS [6 ed.] |
Catherine Muller, Jérôme Chevillotte, Guillaume SAKI |
6 |
| 1358 |
 |
Mémo-guide infirmier - UE 2.1 à 2.11: Sciences biologiques et médicales [3 ed.] |
Pascal Hallouët, Carine BARTH |
3 |
| 1359 |
 |
Méga Mémo IFSI. Tout le Programme Semestre par Semestre de L'étudiant Infirmier [2e édition ed.] |
Hallouët, Pascal |
2 |
| 1360 |
 |
Mémo-guide infirmier [2e édition ed.] |
Pascal Hallouët, Hélène Fournié, Florence Douguet, et al |
2 |
| 1361 |
 |
Management of Nursing Services and Education [2 ed.] |
I. Clement |
2 |
| 1362 |
 |
Management and Leadership for Nurse Administrators |
Linda A. Roussel, Patricia L Thomas, James L. Harris |
|
| 1363 |
 |
Management and Leadership for Nurse Administrators [9 ed.] |
Linda A. Roussel, Patricia L. Thomas, James L. Harris |
9 |
| 1364 |
 |
Manual practico de instrumentacion quirurgica en enfermeria |
Antonio José Gómez Brau, Isabel Serra Guillén |
|
| 1365 |
 |
Manual para la preparación del examen EIR |
Eladio Jiménez Mejías |
|
| 1366 |
 |
Maternal–Child Nursing |
Emily Slone McKinney, Susan Rowen James, Sharon Smith Murray, Kristine Ann Nelson, Jean Weiler Ashwill |
|
| 1367 |
 |
Maternity and Women's Health Care [11 ed.] |
Kathryn Rhodes Alden, Deitra Leonard Lowdermilk, Mary Catherine Cashion, Shannon E. Perry |
11 |
| 1368 |
 |
Mary Eliza Mahoney and the legacy of African American nurses [1 ed.] |
Susan Muaddi Darraj |
1 |
| 1369 |
 |
Maternity Nursing: An Introductory Text [11 ed.] |
Gloria Leifer |
11 |
| 1370 |
 |
Maternal-Child Nursing [5 ed.] |
Emily Slone McKinney, Susan R. James, Sharon Smith Murray, Kristine Nelson, Jean Ashwill |
5 |
| 1371 |
 |
Mechanical Ventilation in the Critically Ill Patient: International Nursing Perspectives, An Issue of Critical Care Nursing Clinics of North America |
Sandra Goldsworthy |
|
| 1372 |
 |
Meet the Nurse [♫ Read-Along ebook. ♫ ed.] |
Joyce Jeffries |
|
| 1373 |
 |
Men's Health: The Practice Nurse's Handbook (Wiley Series in Nursing) [1 ed.] |
Ian Peate |
1 |
| 1374 |
 |
Mon stage infirmier en Cardiologie. Mes notes de stage IFSI: Je réussis mon stage ! |
Laurent Sabbah |
|
| 1375 |
 |
Mon stage infirmier en Dermatologie. Mes notes de stage IFSI: Je réussis mon stage ! |
Angèle Soria |
|
| 1376 |
 |
Mon stage infirmier en Hépato-Gastro-Entérologie. Mes notes de stage IFSI: Je réussis mon stage ! |
Axel Balian |
|
| 1377 |
 |
Mon stage infirmier en Psychiatrie. Mes notes de stage IFSI: Je réussis mon stage ! |
Isabelle Lim-Sabbah, Claire Delage, Laurent Sabbah |
|
| 1378 |
 |
Mon stage infirmier en Urologie-Néphrologie. Mes notes de stage IFSI: Je réussis mon stage ! |
Morgan Rouprêt |
|
| 1379 |
 |
Mon stage infirmier en Endocrinologie-Diabétologie. Mes notes de stage IFSI: Je réussis mon stage ! |
Clotilde Saïe |
|
| 1380 |
 |
Mon stage infirmier en Pédiatrie-Pédopsychiatrie. Mes notes de stage IFSI: Je réussis mon stage ! |
Manuel Schiff, Isabelle Lim-Sabbah |
|
| 1381 |
 |
Mon stage infirmier en Cancérologie-Hématologie. Mes notes de stage IFSI: Je réussis mon stage ! |
Jérôme Alexandre |
|
| 1382 |
 |
Mon stage infirmier en Pneumologie. Mes notes de stage IFSI: Je réussis mon stage ! |
Quentin Philippot, Benjamin Planquette |
|
| 1383 |
 |
Mosby's Assessment Memory NoteCards: Visual, Mnemonic, and Memory Aids for Nurses [2 ed.] |
JoAnn Zerwekh, Jo Carol Claborn |
2 |
| 1384 |
 |
Mosby's Fluids & Electrolytes Memory NoteCards: Visual, Mnemonic, and Memory Aids for Nurses [2 ed.] |
JoAnn Zerwekh, Jo Carol Claborn, Tom Gaglione |
2 |
| 1385 |
 |
Mosby's 2021 Nursing Drug Reference [34 ed.] |
Linda Skidmore-Roth |
34 |
| 1386 |
 |
Mosby's Pathophysiology Memory NoteCards: Visual, Mnemonic, and Memory Aids for Nurses [2 ed.] |
JoAnn Zerwekh, Jo Carol Claborn, Tom Gaglione |
2 |
| 1387 |
 |
Mosby's Pharmacology Memory NoteCards [4 ed.] |
JoAnn Zerwekh, Jo Carol Claborn |
4 |
| 1388 |
 |
Neuromonitoring and Assessment, An Issue of Critical Care Nursing Clinics of North America |
Catherine Harris |
|
| 1389 |
 |
Neurologie. Mes notes de stage IFSI: Je réussis mon stage ! |
Kiyoka KINUGAWA-BOURRON, Emmanuel Roze, Laurent Sabbah |
|
| 1390 |
 |
Nursing Care Plans: Diagnoses, Interventions, and Outcomes [10 ed.] |
Meg Gulanick, Judith L. Myers |
10 |
| 1391 |
 |
Nursing Delegation and Management of Patient Care [2 ed.] |
Kathleen Motacki, Kathleen Burke |
2 |
| 1392 |
 |
Nursing Theory: Utilization and Application [5 ed.] |
Martha Raile Alligood |
5 |
| 1393 |
 |
Nutrition and Biochemistry for Nurses [2 ed.] |
Venkatraman Shreemathy, Suchita P Dandekar |
2 |
| 1394 |
 |
Nurses [♫ Read-Along ebook. ♫ ed.] |
JoAnn Early Macken |
|
| 1395 |
 |
Nursing Ethics and Professional Responsibility in Advanced Practice [4 ed.] |
Pamela J. Grace, Melissa K. Uveges |
4 |
| 1396 |
 |
Nurse as Educator: Principles of Teaching and Learning for Nursing Practice 2nd Edition (Jones and Bartlett Series in Nursing) [2nd ed.] |
Susan Bacorn Bastable |
2 |
| 1397 |
 |
Nursing Leadership, Management, and Professional Practice for the LPN/LVN [7 ed.] |
Tamara R. Dahlkemper |
7 |
| 1398 |
 |
Nursing Informatics and the Foundation of Knowledge [4 ed.] |
Dee McGonigle, Kathleen Mastrian |
4 |
| 1399 |
 |
Nursing Research: Reading, Using and Creating Evidence |
Janet Houser |
|
| 1400 |
 |
Nurses of Passchendaele: Caring for the Wounded of the Ypres Campaigns 1914 - 1918 |
Christine E Hallett |
|
| 1401 |
 |
Nursing Informatics and the Foundation of Knowledge, 6e (Apr 4, 2024)_(1284293432)_(Jones & Bartlett Learning, LLC) |
McGonigle, Dee,Mastrian, Kathleen,, Kathleen G. Mastrian |
|
| 1402 |
 |
Nursing Through the Years: Care and Compassion at the Royal London Hospital |
Loretta Bellman, Sue Boase, Sarah Rogers, Barbara Stuchfield |
|
| 1403 |
 |
Nursing and the Disabled: Across the Life Span (Jones and Bartlett Series in Nursing) [1st ed.] |
Ardella M. Fraley |
1 |
| 1404 |
 |
Nursing Key Topics Review: Maternity |
|
|
| 1405 |
 |
Nursing Ethics: Across the Curriculum and Into Practice |
Janie B. Butts, Karen L. Rich |
|
| 1406 |
 |
Nursing the Spirit: Care, Public Life, and the Dignity of Vulnerable Strangers |
Don Grant |
|
| 1407 |
 |
Nursing Research and Statistics [2 ed.] |
Sharma Suresh |
2 |
| 1408 |
 |
Onkologie. Verstehen - Wissen - Pflegen |
Christa Pleyer (Eds.) |
|
| 1409 |
 |
Pain Management, An Issue of Critical Nursing Clinics |
Stephen D. Krau, Maria Overstreet |
|
| 1410 |
 |
Palliative Care in Critical Care, An Issue of Critical Care Nursing Clinics of North America |
Tonja Hartjes |
|
| 1411 |
 |
Patient and Person, Interpersonal skills in nursing [6 ed.] |
Jane Stein-Parbury |
6 |
| 1412 |
 |
Pathophysiology and Care Protocols for Nursing Management, An Issue of Nursing Clinics |
Lynn C. Parsons |
|
| 1413 |
 |
Pediatric Primary Care: Practice Guidelines for Nurses [4th Edition] |
Beth Richardson |
4 |
| 1414 |
 |
Pediatric Critical Care, An Issue of Critical Nursing Clinics |
Jerithea Tidwell, Brennan Lewis |
|
| 1415 |
 |
Pediatric Anesthesia and Emergency Drug Guide [Spiral-bound ed.] |
Lynn Fitzgerald Macksey |
|
| 1416 |
 |
Pediatric Primary Care: Practice Guidelines for Nurses [2 ed.] |
Beth Richardson |
2 |
| 1417 |
 |
Perioperative Nursing [2 ed.] |
Lois Hamlin, Menna Davies, Marilyn Richardson-Tench, Sally Sutherland-Fraser |
2 |
| 1418 |
 |
Pharmacology for Nurses [2 ed.] |
Tara Shanbhag, Veena Nayak, Smita Shenoy |
2 |
| 1419 |
 |
Pharmacology for Health Professionals - eBook [5 ed.] |
Bronwen Bryant, Kathleen Knights, Andrew Rowland, Shaunagh Darroch |
5 |
| 1420 |
 |
PflegeHeute [7 ed.] |
Nicole Menche |
7 |
| 1421 |
 |
Philosophies and Theories for Advanced Nursing Practice [4 ed.] |
Janie B. Butts, Karen L. Rich |
4 |
| 1422 |
 |
Plans de soins types, chemins cliniques et guides de séjour |
Monique Blondel, Thérèse Psiuk |
|
| 1423 |
 |
Plans De Soins Types et Chemins Cliniques. 19 situations cliniques prevalentes [ELSEVIER-MASSON ed.] |
Thérèse Psiuk and Christine Verhelst (Auth.) |
|
| 1424 |
 |
Placement Learning in Cancer & Palliative Care Nursing: A guide for students in practice |
Penny Howard, Becky Whittaker (nee Chady), Karen Holland |
|
| 1425 |
 |
Policy and Politics for Nurses and Other Health Professionals: Advocacy and Action [4 ed.] |
Donna M. Nickitas, Donna J. Middaugh, Veronica Feeg |
4 |
| 1426 |
 |
Potter & Perry's Fundamentals of Nursing - Australian Version [5 ed.] |
Jackie Crisp, Clint Douglas, Geraldine Rebeiro, Donna Waters |
5 |
| 1427 |
 |
Potter and Perry's Canadian Fundamentals of Nursing [7 ed.] |
Barbara J. Astle, Wendy Duggleby, Patricia A. Potter, Anne G. Perry, Patricia A. Stockert, Amy Hall |
7 |
| 1428 |
 |
Praxisanleitung in der Altenpflege [4 ed.] |
Susanne Lunk |
4 |
| 1429 |
 |
Principles and practice of managing pain : a guide for nurses and allied health professionals |
Gareth Parsons, Wayne Preece |
|
| 1430 |
 |
Principles and Practice of Managing Pain: A Guide for Nurses and Allied Health Professionals [1 ed.] |
Gareth Parsons, Wayne Preece |
1 |
| 1431 |
 |
Professional nursing concepts: competencies for quality leadership [4th Edition] |
Finkelman, Anita Ward |
4 |
| 1432 |
 |
Professional Nursing Concepts: Competencies for Quality Leadership [5 ed.] |
Anita Finkelman |
5 |
| 1433 |
 |
Project planning and management : a guide for nurses and interprofessional teams [Third edition.] |
Dearman, Catherine, Harris, James Leonard, Roussel, Linda, Thomas, Patricia L. |
3 |
| 1434 |
 |
Project Planning, Implementation, and Evaluation: A Guide for Nurses and Interprofessional Teams [4 ed.] |
James L. Harris, Linda A. Roussel, Catherine Dearman, Patricia L. Thomas |
4 |
| 1435 |
 |
Professional Nursing Concepts: Competencies for Quality Leadership [4 ed.] |
Anita Ward Finkelman |
4 |
| 1436 |
 |
Professional Nursing Concepts: Competencies for Quality Leadership [Paperback ed.] |
Anita Finkelman |
|
| 1437 |
 |
Psychiatric Mental Health Nursing, An Issue of Nursing Clinics of North America |
Deborah Antai-Otong |
|
| 1438 |
 |
Public Health Nursing: Practicing Population-Based Care [1 ed.] |
Marie Truglio-Londrigan, Sandra B. Lewenson |
1 |
| 1439 |
 |
Public Health Nursing: Practicing Population-Based Care [3 ed.] |
Marie Truglio-Londrigan, Sandra B. Lewenson |
3 |
| 1440 |
 |
Quality Improvement: A Guide for Integration in Nursing [2 ed.] |
Anita Finkelman |
2 |
| 1441 |
 |
Révision optimale 3 en 1 _ Semestre 2 IFSI: Fiches-Cartes-Audio |
Julie Violet |
|
| 1442 |
 |
Réussir la démarche de soins |
Katy Le Neurès |
|
| 1443 |
 |
Révision optimale 3 en 1 _ Semestres 3 et 4 IFSI: Fiches-Cartes-Audio |
Julie Violet |
|
| 1444 |
 |
Ready Reference for Critical Care Drugs With Nursing Care Plans |
Bonnie P. Stewart, Rhonda M. Strawn |
|
| 1445 |
 |
Relation d'aide en soins infirmiers |
Christiane Vollaire, Société française d'accompagnement et de soins palliatifs., et al |
|
| 1446 |
 |
Role Development in Professional Nursing Practice [3 ed.] |
Kathleen Masters |
3 |
| 1447 |
 |
Role Development in Professional Nursing Practice [5 ed.] |
Kathleen Masters |
5 |
| 1448 |
 |
Role Development for the Nurse Practitioner [2 ed.] |
Julie G. Stewart, Susan M. DeNisco |
2 |
| 1449 |
 |
Role Development in Professional Nursing Practice [6 ed.] |
Kathleen Masters |
6 |
| 1450 |
 |
Sandra Smith’s Review for NCLEX-RN® [13th ed.] |
Marianne P. Barba, Sandra F. Smith |
13 |
| 1451 |
 |
Sandra Smith's review for NCLEX-RN [13 ed.] |
Sandra Fucci Smith, Marianne P. Barba |
13 |
| 1452 |
 |
Sheehy. Manual de urgencia de enfermería [6 ed.] |
Lorene Newberry, MS, RN, CEN, and Laura M. Criddle, MS, RN, CCNS, CEN, CFRN, CNRN (Eds.) |
6 |
| 1453 |
 |
Sheehy’s Manual of Emergency Care, 7E [TRUE PDF] [7th Edition] |
Belinda B Hammond, Polly Gerber Zimmermann |
7 |
| 1454 |
 |
Skills for Midwifery Practice [4 ed.] |
Ruth Johnson, Wendy Taylor |
4 |
| 1455 |
 |
Skills Performance Checklists for Clinical Nursing Skills & Techniques [8 ed.] |
Perry, Potter, Ostendorf |
8 |
| 1456 |
 |
Sociology for Nurses |
Shama Lohumi |
|
| 1457 |
 |
Soins et cultures |
Brigitte Tison, Ellen Hervé-Désirat |
|
| 1458 |
 |
Soins infirmiers et douleur |
Christiane Metzger, Martine Schwetta, Christiane Walter, André Muller |
|
| 1459 |
 |
Spirituality in Nursing - Standing on Holy Ground, 4th Edition [4th edition] |
Mary Elizabeth O'Brien |
4 |
| 1460 |
 |
Spirituality in Nursing: Standing on Holy Ground [1st ed.] |
Mary Elizabeth O'Brien |
1 |
| 1461 |
 |
Spirituality and Hospice Social Work |
Ann M. Callahan |
|
| 1462 |
 |
Statistics for Nursing: A Practical Approach |
Elizabeth Heavey |
|
| 1463 |
 |
Statistics for nursing: a practical approach [Third edition.] |
Heavey, Elizabeth |
3 |
| 1464 |
 |
Statistics for Evidence-Based Practice in Nursing [3 ed.] |
MyoungJin Kim, Caroline Mallory, Teresa Valerio |
3 |
| 1465 |
 |
Strategic Planning for Nurses: Change Management in Health Care [1 ed.] |
Michele Sare, LeAnn Ogilvie |
1 |
| 1466 |
 |
Study Guide for Maternity & Women's Health Care [11 ed.] |
Deitra Leonard Lowdermilk, Shannon E. Perry, Mary Catherine Cashion, Kathryn Rhodes Alden |
11 |
| 1467 |
 |
Study Guide for Wong's Nursing Care of Infants and Children [10 ed.] |
Marilyn J. Hockenberry, David Wilson, Anne Rath Rentfro, Linda McCampbell |
10 |
| 1468 |
 |
Study Guide: Maternity & Women's Health Care [10 ed.] |
Deitra Leonard Lowdermilk, Shannon E. Perry, Kitty Cashion, Kathryn Rhodes Alden |
10 |
| 1469 |
 |
Study Guide for Anatomy & Physiology [9 ed.] |
Linda Swisher, Kevin T. Patton, Gary A. Thibodeau |
9 |
| 1470 |
 |
Study Guide for Foundations and Adult Health Nursing [7 ed.] |
Kim Cooper, Kelly Gosnell |
7 |
| 1471 |
 |
Study Guide for Fundamental Concepts and Skills for Nursing [4 ed.] |
Susan deWit |
4 |
| 1472 |
 |
Suffering [1st ed.] |
Betty Ferrell |
1 |
| 1473 |
 |
Tabbner's Nursing Care [7 ed.] |
Gabby Koutoukidis, Kate Stainton, Jodie Hughson |
7 |
| 1474 |
 |
Technology in the ICU, An Issue of Critical Care Nursing Clinics of North America |
Shu-Fen Wung |
|
| 1475 |
 |
Textbook of Mental Health Nursing [2] |
Dorothy Deena Theodore |
2 |
| 1476 |
 |
Textbook of Pathology and Genetics for Nurses |
Sonal Sharma, Geetika Khanna |
|
| 1477 |
 |
The Doctor of Nursing Practice Project: A Framework for Success [4 ed.] |
Katherine Moran, Rosanne Burson, Dianne Conrad |
4 |
| 1478 |
 |
The Doctor of Nursing Practice: A Guidebook for Role Development and Professional Issues: A Guidebook for Role Development and Professional Nursing Practice |
Lisa Astalos Chism |
|
| 1479 |
 |
The emotionally intelligent nurse leader |
Mae Taylor Moss |
|
| 1480 |
 |
The Emotionally Intelligent Nurse Leader (J-B AHA Press) [1 ed.] |
Mae Taylor Moss |
1 |
| 1481 |
 |
The Nurse Who Became a Spy: Madge Addy’s War Against Fascism |
Chris Hall |
|
| 1482 |
 |
The Nursing Student's Guide to Clinical Success [1 ed.] |
Lorene Payne |
1 |
| 1483 |
 |
The Woman Who Revolutionised Nurses' Training |
Judith Vallely |
|
| 1484 |
 |
Top 60 Signs for Nurses |
Mark Dennis, William Talbot Bowen, Lucy Cho |
|
| 1485 |
 |
Toute l'année 2 du DEI Le cahier de l'étudiant infirmier: 15 UE : Synthèse des cours + Conseils pour s'organiser et se préparer aux stages + Cahier d'entraînements corrigés [2 ed.] |
Pascal Hallouët |
2 |
| 1486 |
 |
Transitions in Nursing 6th Chang.jpg [6 ed.] |
Esther Chang, Deborah Hatcher |
6 |
| 1487 |
 |
Tratado de enfermería neurológica. La persona, la enfermedad y los cuidados |
Rosa Suñer Soler (Eds.) |
|
| 1488 |
 |
Ulrich & Canale's Nursing Care Planning Guides [7 ed.] |
Nancy Haugen, Sandra J. Galura |
7 |
| 1489 |
 |
Understanding the Work of Nurse Theorists [3rd ed.] |
Kathleen Sitzman |
3 |
| 1490 |
 |
Watson's Clinical Nursing Pock [2 ed.] |
Mike Walsh |
2 |
| 1491 |
 |
Nursing the acutely ill adult [New ed] |
Page, Karen, McKinney, Aidín |
|
| 1492 |
 |
Transcultural nursing: concepts, theories, research and practice [3rd ed] |
Leininger, Madeleine M., McFarland, Marilyn R |
3 |
| 1493 |
 |
Safeguarding and child protection for nurses, midwives and health visitors: a practical guide |
Powell, Catherine |
|
| 1494 |
 |
Nursing Older Adults [1 ed.] |
Jan Reed, Charlotte L. Clarke and Ann Macfarlane (Editors) |
1 |
| 1495 |
 |
Nursing laboratory and diagnostic tests demystified |
Keogh, James Edward |
|
| 1496 |
 |
Nursing older adults |
Clarke, Charlotte Laura, Macfarlane, Ann, Reed, Jan (eds.) |
|
| 1497 |
 |
I.V. therapy demystified |
Cheever, Kerry H |
|
| 1498 |
 |
Nursing Fundamentals DeMYSTiFieD: A Self-Teaching Guide (Demystified Nursing) [1 ed.] |
Bennita Vaughans |
1 |
| 1499 |
 |
Pediatric Nursing Demystified [1 ed.] |
Joyce Johnson, James Keogh |
1 |
| 1500 |
 |
Nursing in Child and Adolescent Mental Health |
Nisha Dogra, Sarah Hogan, Sharon Leighton |
|
| 1501 |
 |
Administración de los servicios de enfermería [7ª ed.] |
María de la Luz Balderas Pedrero |
7 |
| 1502 |
 |
Assessment and care planning in mental health nursing |
Wrycraft, Nick |
|
| 1503 |
 |
Administración de los servicios de enfermería [6a ed.] |
María de la Luz Balderas Pedrero |
6 |
| 1504 |
 |
Nurse’s toolbook for promoting wellness |
Miller, Carol A |
|
| 1505 |
 |
Nurses!: test yourself in pharmacology |
Rogers, Katherine M. A |
|
| 1506 |
 |
McGraw-Hill's Nursing School Entrance Exams [1 ed.] |
Thomas Evangelist, Tamra Orr, Judy Unrein |
1 |
| 1507 |
 |
McGraw-Hill's Nursing School Entrance Exams [1 ed.] |
McGraw-Hill Education |
1 |
| 1508 |
 |
Nurses! Test yourself in pathophysiology |
Scott, William N., Rogers, Katherine M. A |
|
| 1509 |
 |
International Disaster Nursing [1 ed.] |
Robert Powers, Elaine Daily |
1 |
| 1510 |
 |
Yatdjuligin Aboriginal and Torres Strait Islander Nursing and Midwifery Care [3 ed.] |
Odette Best, Bronwyn Fredericks |
3 |
| 1511 |
 |
IV Therapy Demystified - A Self-Teaching Guide [1 ed.] |
Kerry Cheever |
1 |
| 1512 |
 |
Introduction to Mental Health Nursing |
Wrycraft, Nick |
|
| 1513 |
 |
Davis Advantage for Medical-Surgical Nursing2nd edition Hoffman Sullivan Test Bank |
|
2 |
| 1514 |
 |
Nursing Informatics ′91: Proceedings of the Post Conference on Health Care Information Technology: Implications for Change [1 ed.] |
Salah H. Mandil (auth.), Patsy B. Marr RN, MSN, Rita L. Axford RN, PhD, Susan K. Newbold RN, MS (eds.) |
1 |
| 1515 |
 |
Nursing Informatics ’91: Pre-Conference Proceedings [1 ed.] |
Sherri Dorken, Gordon Tait, Janet Brophy (auth.), James P. Turley, Susan K. Newbold (eds.) |
1 |
| 1516 |
 |
Nursing Physician Control and the Medical Monopoly - Historical Perspectives on Genered Inequality in Roles, Rights and Range of Practice [1 ed.] |
Thetis M. Group, Joan I. Roberts |
1 |
| 1517 |
 |
Critical thinking: an interactive tool for learning medical-surgical nursing |
Eleanor Varsen Vanetzian |
|
| 1518 |
 |
Advanced Nursing Skills: Principles and Practice [1 ed.] |
Molly Courtenay, Michele Butler |
1 |
| 1519 |
 |
Understanding Medical-surgical Nursing [1 ed.] |
M.D. Robert Langdon |
1 |
| 1520 |
 |
Understanding Medical Surgical Nursing Williams [3rd ed.] |
Paula Hopper, Linda Williams |
3 |
| 1521 |
 |
Emergency nursing : 5-tier triage protocols |
Julie K. Briggs, Valerie G.A. Grossman BSN CEN CCRN |
|
| 1522 |
 |
Intravenous Infusions and Related Tasks MD0553 [200 ed.] |
|
200 |
| 1523 |
 |
Administer Intramuscular, Subcutaneous, and Intradermal Injections MD0552 [100 ed.] |
US Army medical department |
100 |
| 1524 |
 |
Scrub, Gown, and Glove Procedures MD0933 [100 ed.] |
US Army medical department |
100 |
| 1525 |
 |
Management of Patients with Respiratory Dysfunctions MD0542 [200 ed.] |
|
200 |
| 1526 |
 |
Nursing Care of the Surgical Patient MD0915 [100 ed.] |
US Army medical department |
100 |
| 1527 |
 |
Introduction to Practical Nursing MD0910 [200 ed.] |
US Army medical department |
200 |
| 1528 |
 |
Nursing Care Related to the Gastrointestinal and Urinary Systems MD0918 [100 ed.] |
US Army medical department |
100 |
| 1529 |
 |
Nursing Fundamentals I MD0905 [100 ed.] |
|
100 |
| 1530 |
 |
Basic Patient Care Procedures MD0556 [100 ed.] |
US Army medical department |
100 |
| 1531 |
 |
Blood, Electrolytes, and Intravenous Infusions Subcourse MD 0564 [100 ed.] |
US Army medical department |
100 |
| 1532 |
 |
Advanced Concepts in Multiple Sclerosis Nursing Care, 2nd Edition [2 ed.] |
June Halper |
2 |
| 1533 |
 |
Nursing Care Related to the Sensory and Neurological Systems MD0919 [100 ed.] |
|
100 |
| 1534 |
 |
Critical Thinking in the Medical-surgical Unit: Skills to Assess, Analyze, and Act |
Shelley Cohen |
|
| 1535 |
 |
Nursing Fundamentals II MD0906 [100 ed.] |
US Army medical department |
100 |
| 1536 |
 |
Medical-Surgical Nursing DeMystiFied - A Self-Teaching Guide [1 ed.] |
Mary Digiulio, James Keogh |
1 |
| 1537 |
 |
Medical-surgical nursing : preparation for practice |
Watson, Annita B., Wraa, Cheryl E., Osborn, Kathleen S. |
|
| 1538 |
 |
Fast Facts for the Medical Office Nurse : What You Really Need to Know in a Nutshell [1 ed.] |
Sheila Richmeier |
1 |
| 1539 |
 |
Stedman's Medical Dictionary for the Health Professions and Nursing [7 ed.] |
Thomas Lathrop Stedman |
7 |
| 1540 |
 |
Nursing against the Odds : How Health Care Cost Cutting, Media Stereotypes, and Medical Hubris Undermine Nurses and Patient Care [1 ed.] |
Suzanne Gordon |
1 |
| 1541 |
 |
Medical Surgical Nursing Care: Pearson New International Edition [3 ed.] |
Karen M. Burke, Priscilla LeMone, Elaine Mohn-Brown, Linda Eby |
3 |
| 1542 |
 |
Effective leadership and management in nursing [8 ed.] |
Eleanor J. Sullivan |
8 |
| 1543 |
 |
Medical-Surgical Nursing Test Success : An Unfolding Case Study Review [1 ed.] |
Karen K. Gittings, Rhonda M. Brogdon, Frances H. Cornelius, Ruth A. Wittmann-Price |
1 |
| 1544 |
 |
Fast Facts for the Medical- Surgical Nurse: Clinical Orientation in a Nutshell [1 ed.] |
Maggie Ciocco, Margaret Curry Ciocco |
1 |
| 1545 |
 |
Clinical Cases: Medical-surgical nursing case studies [1 ed.] |
|
1 |
| 1546 |
 |
NANDA International Nursing Diagnoses: Definitions & Classification, 2024-2026 (English Edition) [13 ed.] |
T. Heather Herdman, Shigemi Kamitsuru, Camila Takao Lopes |
13 |
| 1547 |
 |
Understanding Medical-Surgical Nursing [5th ed.] |
Linda S. Williams, Paula D. Hopper |
5 |
| 1548 |
 |
Lewis's Medical-Surgical Nursing: Assessment and Management of Clinical Problems [12 ed.] |
Mariann Harding, Jeffrey Kwong, Debra Hagler, |
12 |
| 1549 |
 |
Inpatient psychiatric nursing : clinical strategies, medical considerations, and practical interventions [Second ed.] |
Joanne M. Matthew (editor), Charles Alexandre (editor), Mary Helen Hohenhaus (editor), Judy L. Sheehan (editor) |
2 |
| 1550 |
 |
The APRN and PA'S complete guide to prescribing drug therapy [2022 ed.] |
Teton Data Systems (Firm), STAT!Ref (Online service) |
2022 |
| 1551 |
 |
Study Guide for Understanding Medical Surgical Nursing [7 ed.] |
Linda S. Hopper, Paula D. Williams |
7 |
| 1552 |
 |
Digitale Patientenversorgung: Zur Computerisierung von Diagnostik, Therapie und Pflege |
Julia Inthorn, Rudolf Seising (editors) |
|
| 1553 |
 |
Medical Dosage Calculations - A Dimensional Analysis Approach, 2022 Update, 11e (Dec 11, 2021)_(013687696X)_(Pearson) |
|
|
| 1554 |
 |
Medical Dosage Calculations: A Dimensional Analysis Approach, Updated Edition [11 ed.] |
June Olsen, Anthony Giangrasso, Dolores Shrimpton |
11 |
| 1555 |
 |
Essentials of medical genetics for nursing and health professionals : an interprofessiona approach |
Laura M. Gunder McClary |
|
| 1556 |
 |
Davis's Drug Guide for Nurses [17 ed.] |
April Hazard Vallerand, Cynthia A. Sanoski |
17 |
| 1557 |
 |
Focus on Adult Health: Medical-Surgical Nursing [Hardcover ed.] |
Linda Honan |
|
| 1558 |
 |
RN Adult Medical Surgical Nursing REVIEW MODULE EDITION 11.0 [11.0 ed.] |
ATI Nursing Education |
110 |
| 1559 |
 |
Handbook of Clinical Nursing: Medical-Surgical Nursing |
Joyce Fitzpatrick |
|
| 1560 |
 |
Hospital Circles |
Andrews, Lucilla [Andrews, Lucilla] |
|
| 1561 |
 |
OET (Nursing) Refresh 2.0 Lite Guide |
IELTS Medical |
|
| 1562 |
 |
Juta's Complete Textbook of Medical Surgical Nursing [2 ed.] |
Mogotlane, Sophie |
2 |
| 1563 |
 |
Medical-Surgical Nursing: Critical Thinking for Person-Centred Care [1-3, 3 ed.] |
Levett-Jones, Tracey, Lemone, Priscilla, Burke, Karen |
3 |
| 1564 |
 |
Nurse’s pocket guide : diagnoses, prioritized interventions, and rationales [14th ed.] |
Marilynn E. Doenges, Mary Frances Moorhouse, Alice C. Murr |
14 |
| 1565 |
 |
Justice to the Maimed Soldier: Nursing, Medical Care and Welfare for Sick and Wounded Soldiers and Their Families During the English Civil Wars and Interregnum, 1642–1660 |
Eric Gruber von Arni |
|
| 1566 |
 |
Kozier & Erb's fundamentals of nursing : concepts, practice, and process [Tenth edition] |
Berman, Audrey, Frandsen, Geralyn, Snyder, Shirlee |
10 |
| 1567 |
 |
Medical Spanish for Nurses: a Self-Teaching Guide |
Traverso, Soledad, Dr., PhD,Urraro, Laurie, Dr., PhD,McMahon, Patty Pasky, Dr., PhD, CRNP |
|
| 1568 |
 |
Psychology and Psychological Medicine for Nurses |
Portia Holman (Auth.) |
|
| 1569 |
 |
Psychosomatic Medicine for Nurses |
Harold Maxwell MD, MRCPsych (auth.) |
|
| 1570 |
 |
Abbreviations and Acronyms in Medicine and Nursing [1 ed.] |
Solomon Garb M.D., F.A.C.P., Eleanor Krakauer, Carson Justice (auth.) |
1 |
| 1571 |
 |
Nursing and nursing education : public policies and private actions |
Institute of Medicine (U.S.). Division of Health Care Services |
|
| 1572 |
 |
Nursing and Computers: An Anthology [1 ed.] |
Virginia K. Saba (auth.), Virginia K. Saba RN, EdD, Karen A. Rieder Capt, NC, USN, Dorothy B. Pocklington RN, MSN (eds.) |
1 |
| 1573 |
 |
Nursing Staff in Hospitals and Nursing Homes: Is It Adequate? [1 ed.] |
Institute of Medicine, Committee on the Adequacy of Nursing Staff in Hospitals and Nursing Homes, Carolyne K. Davis, Frank Sloan, Gooloo S. Wunderlich |
1 |
| 1574 |
 |
Nursing, Health, and the Environment [1 ed.] |
Institute of Medicine, Committee on Enhancing Environmental Health Content in Nursing Practice, Lillian H. Mood, Meta A. Snyder, Andrew M. Pope |
1 |
| 1575 |
 |
The PACE System: An Expert Consulting System for Nursing [1 ed.] |
Steven Evans (auth.) |
1 |
| 1576 |
 |
Nursing and Computers: An Anthology, 1987–1996 [1 ed.] |
Shelia A. Ryan, L. M. Nagle (auth.), Virginia K. Saba EdD, RN, FAAN, FACMI, Dorothy B. Pocklington MSN, RN, Kenneth P. Miller PhD, RN, FAAN (eds.) |
1 |
| 1577 |
 |
Remodelling Hospitals and Health Professions in Europe: Medicine, Nursing and the State |
Mike Dent |
|
| 1578 |
 |
Keeping Patients Safe -- Transforming the Work Environment of Nurses |
Institute of Medicine of the National Academies |
|
| 1579 |
 |
New Directions in Nursing History: International Perspectives [1 ed.] |
Susan McGann, Barbara Mortimer |
1 |
| 1580 |
 |
Top 100 Health Care Careers: Your Complete Guidebook To Training And Jobs In Allied Health, Nursing, Medicine, And More 2nd Edition [2 ed.] |
Saul Wischnitzer, Edith Wischnitzer |
2 |
| 1581 |
 |
Community Nursing and Primary Healthcare in Twentieth-Century Britain (Routledge Studies in the Social History of Medicine) [1 ed.] |
Helen M. Sweet |
1 |
| 1582 |
 |
The Future of Nursing: Leading Change, Advancing Health [1 Har/Cdr ed.] |
at the Institute of Medicine Committee on the Robert Wood Johnson Foundation Initiative on the Future of Nursing, Institute of Medicine |
1 |
| 1583 |
 |
A Summary of the December 2009 Forum on the Future of Nursing : Care in the Community [1 ed.] |
Institute of Medicine, at the Institute of Medicine Committee on the Robert Wood Johnson Foundation Initiative on the Future of Nursing |
1 |
| 1584 |
 |
Quality Assurance in Healthcare Service Delivery, Nursing and Personalized Medicine: Technologies and Processes [1 ed.] |
Athina Lazakidou |
1 |
| 1585 |
 |
Lifestyle Nursing |
Gia Merlo, Kathy Berra |
|
| 1586 |
 |
Nursing the Nation : Building the Nurse Labor Force [1 ed.] |
Jean C. Whelan |
1 |
| 1587 |
 |
False Dawn : The Rise and Decline of Public Health Nursing [1 ed.] |
Karen Buhler-Wilkerson, Susan M. Reverby, Julie A. Fairman, Sandra B. Lewenson |
1 |
| 1588 |
 |
The Future of Nursing 2020-2030: Charting a Path to Achieve Health Equity [1 ed.] |
National Academy of Medicine, Committee on the Future of Nursing 2020-2030, Jennifer Lalitha Flaubert (editor), Suzanne Le Menestrel (editor), David R. Williams (editor), Mary K. Wakefield (editor) |
1 |
| 1589 |
 |
False Dawn: The Rise and Decline of Public Health Nursing [Reprint ed.] |
Karen Buhler-Wilkerson |
|
| 1590 |
 |
Talking Therapy: Knowledge and Power in American Psychiatric Nursing |
Kylie M. Smith |
|
| 1591 |
 |
Medically speaking : a dictionary of quotations on dentistry, medicine and nursing |
Cavazos-Gaither, Alma E., Gaither, Carl C., Slocombe, Andrew |
|
| 1592 |
 |
A Nurse's Medicine Basket: Tools for Compassionate Self-Care |
Tina Bradley Gain |
|
| 1593 |
 |
Learning to Heal : Reflections on Nursing School in Poetry and Prose [1 ed.] |
Jeanne Bryner, Cortney Davis, Judy Schaefer |
1 |
| 1594 |
 |
Nursing with a Message: Public Health Demonstration Projects in New York City |
Patricia D’Antonio |
|
| 1595 |
 |
Wild Onion Nurse: a Collection of 25 Years of the Poetry of Nursing in a College of Medicine Literary Journal |
Schaefer, Judy |
|
| 1596 |
 |
Assessing Progress on the Institute of Medicine Report the Future of Nursing [1 ed.] |
|
1 |
| 1597 |
 |
Future Directions of Credentialing Research in Nursing: Workshop Summary [1 ed.] |
Institute of Medicine, Board on Health Sciences Policy, Victoria Weisfeld, Margaret A. McCoy |
1 |
| 1598 |
 |
Tenderly Lift Me : Nurses Honored, Celebrated, and Remembered [1 ed.] |
Jeanne Bryner |
1 |
| 1599 |
 |
Empowering Women and Strengthening Health Systems and Services Through Investing in Nursing and Midwifery Enterprise: Lessons from Lower-Income Countries: Workshop Summary [1 ed.] |
Institute of Medicine, Board on Global Health, Forum on Public-Private Partnerships for Global Health and Safety, Global Forum on Innovation in Health Professional Education, Megan M. Perez, Deepali M. Patel, Patricia A. Cuff |
1 |
| 1600 |
 |
Mosby's Dictionary of Medicine, Nursing and Health Professions ANZ Edition [3 ed.] |
Harris, Nagy &, Vardaxis |
3 |
| 1601 |
 |
The Door of Last Resort: Memoirs of a Nurse Practitioner [1 ed.] |
Professor Frances Ward |
1 |
| 1602 |
 |
The good nurse: a true story of medicine, madness, and murder [First edition] |
Cullen, Charles,Graeber, Charles |
|
| 1603 |
 |
Learning IOM: Implications of the Institute of Medicine Reports for Nursing Education [1 ed.] |
Anita Finkelman, Carole Kenner |
1 |
| 1604 |
 |
Medicine Management Skills for Nurses [1 ed.] |
Claire Boyd |
1 |
| 1605 |
 |
Annual Review of Nursing Research, Volume 1, 1983: Focus on Human Development [1 ed.] |
Harriet H. Werley PhD, Joyce J. Fitzpatrick PhD RN FAAN |
1 |
| 1606 |
 |
World War Ii Allied Nursing Services |
|
|
| 1607 |
 |
Wong's Nursing Care of Infants and Children [9 ed.] |
Marilyn J. Hockenberry, David Wilson |
9 |
| 1608 |
 |
Demonstrating Your Clinical Competence in Respiratory Disease, Diabetes and Dermatology [1 ed.] |
Jane Higgs (Author), Ruth Chambers (Author), Gill Wakley (Author), Alistair Pullan (Author) |
1 |
| 1609 |
 |
Nurses! Test Yourself In Non-Medical Prescribing |
Noel Harris, Diane Shearer |
|
| 1610 |
 |
Mcgraw Hill's IV Drug Handbook [1 ed.] |
Patricia Schull |
1 |
| 1611 |
 |
Nurses! Test yourself in essential calculation skills |
Scott, William N., Rogers, Katherine M. A |
|
| 1612 |
 |
Nurses! Test Yourself in Clinical Skills |
Marian Traynor |
|
| 1613 |
 |
Nurses! Test yourself in anatomy and physiology |
Scott, William N., Rogers, Katherine M. A |
|
| 1614 |
 |
Nurses Pocket Drug Guide 2015 [10 ed.] |
Judith Barberio, Susan Underwood, Claudia Beck |
10 |
| 1615 |
 |
Telephone triage protocols for adult populations |
Wheeler, Sheila Q |
|
| 1616 |
 |
Nurses Pocket Drug Guide 2015 |
Barberio, Judith, Beck, Claudia, Underwood, Susan |
|
| 1617 |
 |
Social policy for nurses and the helping professions [2nd ed] |
Peckham, Stephen, Meerabeau, Liz |
2 |
| 1618 |
 |
Schaum's Outline of Emergency Nursing [1 ed.] |
Jim Keogh |
1 |
| 1619 |
 |
Nurse's Pocket Drug Guide 2009 [5 ed.] |
Judith A. Barberio |
5 |
| 1620 |
 |
Nurse's Toolbook for Promoting Wellness [1 ed.] |
Carol Miller |
1 |
| 1621 |
 |
McGraw-Hill Education Nursing School Entrance Exams with DVD |
Thomas A. Evangelist |
|
| 1622 |
 |
McGraw-Hill Education nursing school entrance exams [Third ed.] |
Thomas A. Evangelist |
3 |
| 1623 |
 |
Prescription drug guide for nurses |
Jordan, Sue |
|
| 1624 |
 |
Farmacología para enfermeras [2a ed.] |
Consuelo Rodríguez Palomares, Sandra Irma Montes de Oca Mayagoitia, Alfonso Garfias Arvizu |
2 |
| 1625 |
 |
Psychosocial Nursing: a Guide To Nursing The Whole Person |
Roberts, Dave |
|
| 1626 |
 |
Nurse to nurse. Nursing management [1 ed.] |
Knodel, Linda J |
1 |
| 1627 |
 |
Writing your nursing portfolio: a step-by-step guide |
Duffy, Anita, Timmins, Fiona |
|
| 1628 |
 |
Essential calculation skills for nurses, midwives and healthcare practitioners |
Hutton, Meriel |
|
| 1629 |
 |
Nurse to nurse. Evidence-based practice |
Larrabee, June H |
|
| 1630 |
 |
Nurse to Nurse Wound Care - Expert Interventions [1 ed.] |
Donna Scemons, Denise Elston |
1 |
| 1631 |
 |
Essentials of Nursing Informatics [6 ed.] |
McCormick, Kathleen, Saba, Virginia |
6 |
| 1632 |
 |
Essentials of nursing informatics study guide |
Brixey, Jack E., Brixey, Juliana J., McCormick, Kathleen Ann, Saba, Virginia K |
|
| 1633 |
 |
Nurse to Nurse Palliative Care - Expert Interventions [1 ed.] |
Margaret L. Campbell |
1 |
| 1634 |
 |
McGraw-Hill's I.V. Drug Handbook (McGraw-Hill Handbooks) [1 ed.] |
Patricia Schull |
1 |
| 1635 |
 |
Nurse to Nurse Dementia Care [1 ed.] |
Cynthia D. Steele |
1 |
| 1636 |
 |
Further essentials of pharmacology for nurses |
Barber, Paul, Parkes, Joy, Blundell, Diane |
|
| 1637 |
 |
Mcgraw-Hill's I.V. drug handbook |
Schull, Patricia Dwyer |
|
| 1638 |
 |
Essentials of Nursing Informatics, 7th Edition [7 ed.] |
Virginia Saba, Kathleen McCormick |
7 |
| 1639 |
 |
Succeed in OSCEs and practical exams: an essential guide for nurses |
Westcotte, Liz, Merriman, Clair |
|
| 1640 |
 |
McGraw-Hill Education HESI A2 Review |
Zahler, Kathy A |
|
| 1641 |
 |
Essentials of pharmacology for nurses [2nd ed] |
Barber, Paul, Robertson, Deborah |
2 |
| 1642 |
 |
Health Assessment Demystified |
Mary Digiulio, Daria Napierkowski |
|
| 1643 |
 |
Essentials of pharmacology for nurses [3 ed.] |
Barber, Paul, Robertson, Deborah |
3 |
| 1644 |
 |
McGraw-Hill's 5 NLN PAX-RN Practice Tests [1 ed.] |
Joseph Brennan |
1 |
| 1645 |
 |
Essentials of Pharmacology for Nurses [4 ed.] |
Paul Barber |
4 |
| 1646 |
 |
McGraw-Hill's 3 Evolve Reach (HESI) A2 practice tests [1 ed.] |
Kathy A. Zahler |
1 |
| 1647 |
 |
Técnicas básicas de enfermería. |
Ana María Fernández Espinosa |
|
| 1648 |
 |
Patient Management in the Telemetry/Cardiac Step Down Unit: A Case-Based Approach [1 ed.] |
Muhammad Saad, Manoj Bhandari, Timothy J Vittorio |
1 |
| 1649 |
 |
Introduction to Mental Health Nursing |
Nick Wrycraft |
|
| 1650 |
 |
Basic math for nursing and allied health |
Propes, Denise J., Brown, Alice J., Egler, Lynn M |
|
| 1651 |
 |
Physical health and well-being in mental health nursing: clinical skills for practice [Second edition] |
Nash, Michael Joseph |
2 |
| 1652 |
 |
Pathophysiology of nursing demystified |
Ballestas, Helen Christina, Caico, Carol |
|
| 1653 |
 |
Progressive care nursing certification: preparation, review, and practice exams |
Ahrens, Thomas |
|
| 1654 |
 |
Psychology for nurses and the caring professions [4th ed] |
Walker, Jan |
4 |
| 1655 |
 |
The Prescription Drug Guide for Nurses [1 ed.] |
Sue Jordan (Author) |
1 |
| 1656 |
 |
New Nurse's Survival Guide [1 ed.] |
Genevieve Chandler |
1 |
| 1657 |
 |
Achieving Competencies For Nursing Practice: a Handbook For Student Nurses |
Webster, Brian, Reading, Sheila |
|
| 1658 |
 |
Pathophysiology flash cards [1st edition] |
Amin, Sarina,Cannarozzi, Maria L.,Connolly, Keith,Kibble, Jonathan David |
1 |
| 1659 |
 |
Hurst Reviews Pathophysiology Review [1 ed.] |
Marlene Hurst |
1 |
| 1660 |
 |
Hurst Reviews NCLEX-RN Review [1st edition] |
Hurst, Marlene |
1 |
| 1661 |
 |
4 HESI A2 Practice Tests |
Kathy A. Zahler |
|
| 1662 |
 |
Hurst Reviews: NCLEX PN Review (Hurst Reviews) [Paperback ed.] |
Marlene Hurst |
|
| 1663 |
 |
Psychological interventions in mental health nursing |
Smith, Grahame |
|
| 1664 |
 |
AACN Essentials of Critical Care Nursing [First ed.] |
Marianne Chulay, Suzanne Burns, American Association of Critical-Care Nurses (AACN) |
|
| 1665 |
 |
AACN [2nd ed] |
Burns, Suzanne M., Chulay, Marianne |
2 |
| 1666 |
 |
Critical care nursing certification. |
Johnson, Alexander |
|
| 1667 |
 |
Critical Care Nursing DeMYSTiFieD |
Terry, Cynthia Lee, Weaver, Aurora L |
|
| 1668 |
 |
Clinical judgement and decision-making: in nursing and interprofessional healthcare |
Standing, Mooi |
|
| 1669 |
 |
AACN essentials of critical care nursing [Third edition] |
Burns, Suzanne M |
3 |
| 1670 |
 |
Diet therapy in advanced practice nursing: nutrition perscriptions for improved patient outcomes |
Ferraro, Katie, Winter, Cheryl |
|
| 1671 |
 |
AACN Essentials of Progressive Care Nursing [3 ed.] |
Suzanne Burns |
3 |
| 1672 |
 |
NCLEX-RN review [1st edition] |
Hurst, Marlene |
1 |
| 1673 |
 |
Critical care nursing review [2nd ed] |
Plantz, Scott H., Gossman, William G |
2 |
| 1674 |
 |
The art and science of mental health nursing: principles and practice [Third edition] |
Norman, Ian J., Ryrie, Iain |
3 |
| 1675 |
 |
AACN essentials of progressive care nursing [Third edition] |
Burns, Suzanne M |
3 |
| 1676 |
 |
AACN Essentials of Progressive Care Nursing [2 ed.] |
Marianne Chulay, Suzanne Burns |
2 |
| 1677 |
 |
Foundations for Operating Department Practice : Essential Theory for Practice [1 ed.] |
Hannah Abbott, Helen Booth |
1 |
| 1678 |
 |
Intravenous Therapy for Health Care Personnel |
Kathryn A. Booth |
|
| 1679 |
 |
AACN Essentials of Progressive Care Nursing [5 ed.] |
Sarah Delgado |
5 |
| 1680 |
 |
Psychiatric and mental health nursing demystified |
Keogh, James Edward |
|
| 1681 |
 |
Opportunities in Nursing Careers [Subsequent ed.] |
Keville Frederickson |
|
| 1682 |
 |
McGraw-Hill Education 6 NLN PAX-RN Practice Tests [2 ed.] |
Joseph Brennan |
2 |
| 1683 |
 |
Communication skills for adult nurses |
Kraszewski, Sarah, McEwen, Abayomi |
|
| 1684 |
 |
The student nurse handbook [New ed] |
Aston, Liz, Strouther, Lesley |
|
| 1685 |
 |
Communication Skills For Children'S Nurses |
Long, Tony, Lambert, Veronica, Kelleher, Deirdre |
|
| 1686 |
 |
The student nurse guide to decision making in practice |
McGown, Rachel, Aston, Liz, Wakefield, Jill |
|
| 1687 |
 |
Communication skills for mental health nurses |
Callaghan, Patrick, Morrissey, Jean |
|
| 1688 |
 |
Schaum's Outline of General, Organic, and Biochemistry for Nursing and Allied Health [2 ed.] |
George Odian, Ira Blei |
2 |
| 1689 |
 |
The ultimate guide to getting into nursing school |
Chandler, Genevieve Elizabeth |
|
| 1690 |
 |
Enfermería ginecoobstétrica |
Miriam Guana ... [et al.] , presentación de Umberto A. Bianchi , traducción Sabrina Ais, Alessandro Bisogno |
|
| 1691 |
 |
Medicine management for nurses: case book |
Barber, Paul |
|
| 1692 |
 |
Mcgraw-hill education 5 teas practice tests, [fourth ed.] |
KATHY ZAHLER |
4 |
| 1693 |
 |
How To Do A Systematic Literature Review In Nursing: a Step-By-Step Guide |
Bettany-Saltikov, Josette |
|
| 1694 |
 |
Leadership for nursing and allied health professions |
Bishop, Veronica |
|
| 1695 |
 |
Resumes for Nursing Careers (Professional Resumes Series) [3 ed.] |
Editors of McGraw-Hill |
3 |
| 1696 |
 |
Medical-surgical nursing demystified |
Jackson, Donna, DiGiulio, Mary, Keogh, James Edward |
|
| 1697 |
 |
Foundations of nursing: an integrated approach |
Evans, Cliff D., Tippins, Emma |
|
| 1698 |
 |
Medical-Surgical Nursing Demystified (Demystified Nursing) [1 ed.] |
Mary Digiulio, James Keogh |
1 |
| 1699 |
 |
Medical-surgical nursing demystified [Second edition] |
DiGiulio, Mary, Keogh, James Edward |
2 |
| 1700 |
 |
Medical-Surgical Nursing Certification Exam Review: Pearls of Wisdom [1 ed.] |
Scott Plantz, III, E. John Wipfler |
1 |
| 1701 |
 |
Dosage calculations and basic math for nurses demystified [Second edition] |
Keogh, James Edward |
2 |
| 1702 |
 |
Ethics for nurses: theory and practice |
Cranmer, Pam, Nhemachena, Jean |
|
| 1703 |
 |
Schaum's Outline of Nursing Laboratory and Diagnostic Tests (Schaum's Outline Series) [1 ed.] |
James Keogh |
1 |
| 1704 |
 |
Clinical Skills : the Essence of Caring |
Helen Iggulden, Caroline MacDonald, Karen Staniland |
|
| 1705 |
 |
500 HESI A2 QUESTIONS TO KNOW BY TEST DAY [2 ed.] |
KATHY A. ZAHLER |
2 |
| 1706 |
 |
Nursing Spectrum Drug Handbook 2010 [5 ed.] |
Patricia Schull |
5 |
| 1707 |
 |
Caring Science, Mindful Practice : Implementing Watson's Human Caring Theory [1 ed.] |
Kathleen Sitzman, Jean Watson |
1 |
| 1708 |
 |
Caring, the Human Mode of Being: A Blueprint for the Health Professions, Second Revised Edition [Second Revised] |
M. Simone Roach |
2 |
| 1709 |
 |
Global Advances in Human Caring Literacy |
Susan M. Lee, Patrick A. Palmieri, Jean Watson |
|
| 1710 |
 |
Human Trafficking: A Global Health Emergency: Perspectives from Nursing, Criminal Justice, and the Social Sciences [1st ed. 2023] |
Mary de Chesnay (editor), Donna Sabella (editor) |
1 |
| 1711 |
 |
Nursing, Caring, and Complexity Science: For Human-Environment Well Being [1 ed.] |
Alice Davidson, Marilyn Ray, Marian Turkel |
1 |
| 1712 |
 |
Procedure Checklists for Fundamentals of Nursing: Human Health and Function [7 ed.] |
Ruth F. Craven, Constance J. Hirnle, Sharon Jensen |
7 |
| 1713 |
 |
Teaching the Practitioners of Care : New Pedagogies for the Health Professions [1 ed.] |
Nancy L. Diekelmann |
1 |
| 1714 |
 |
The Backwash of War - The Human Wreckage of the Battlefield as Witnessed by an American Hospital Nurse (WWI Centenary Series) |
Ellen Newbold LaMotte |
|
| 1715 |
 |
Wound Healing: Process, Phases, and Promoting [1 ed.] |
Jane E. Middleton |
1 |
| 1716 |
 |
Mentoring in Nursing through Narrative Stories Across the World |
Nancy Rollins Gantz (editor), Thóra B. Hafsteinsdóttir (editor) |
|
| 1717 |
 |
Parish Nursing: Stories of Service and Care [1 ed.] |
Verna Benner Carson, Harold George Koenig |
1 |
| 1718 |
 |
Cherry Ames Nurse Stories, Vol. 18 [1st ed.] |
Helen Wells |
1 |
| 1719 |
 |
Reflections on Doctors: Nurses' Stories about Physicians and Surgeons (Kaplan Voices Nurses) |
Terry Ratner |
|
| 1720 |
 |
Best Practices in Nursing Education: Stories of Exemplary Teachers [1 ed.] |
Mary Jane Smith PhD RN |
1 |
| 1721 |
 |
Making A Difference: Stories From The Point Of Care (Volume I) [Rev&Expand ed.] |
Sharon Hudacek |
|
| 1722 |
 |
Cup of Comfort for Nurses: Stories of Caring and Compassion [1 ed.] |
Colleen Sell |
1 |
| 1723 |
 |
In Our Own Right: Black Australian Nurses’ Stories |
Sally S. Goold, Kerrynne Liddle |
|
| 1724 |
 |
Final Moments: Nurses' Stories about Death and Dying (Kaplan Voices) |
Deborah Sherman |
|
| 1725 |
 |
Cherry Ames, Companion Nurse: Book 17 (CHERRY AMES NURSING STORIES) [1 ed.] |
Helen Wells |
1 |
| 1726 |
 |
Chicken soup for the nurse's soul, second dose : more stories to honor and inspire nurses |
Canfield, Jack, Hansen, Mark Victor, McNamara, Heather, Simmons, Karen |
|
| 1727 |
 |
Chicken Soup for the Nurse's Soul: 101 Stories to Celebrate, Honor and Inspire the Nursing Profession |
Jack Canfield, Mark Victor Hansen, Nancy Mitchell Autio, LeAnn Thieman, L.P.N. |
|
| 1728 |
 |
When Chicken Soup Isn't Enough: Stories of Nurses Standing Up for Themselves, Their Patients, and Their Profession [1 ed.] |
Suzanne Gordon |
1 |
| 1729 |
 |
When Chicken Soup Isn't Enough: Stories of Nurses Standing Up for Themselves, Their Patients, and Their Profession |
Suzanne Gordon (editor) |
|
| 1730 |
 |
Implementing Evidence-Based Practice: Real Life Success Stories [1 ed.] |
Bernadette Mazurek, Ph.d., R.n., Melnyk, Ellen, F. Fineout-overholt |
1 |
| 1731 |
 |
The Call of Nursing: Stories from the Front Lines of Health Care [1st ed.] |
William B. Patrick |
1 |
| 1732 |
 |
I wasn't strong like this when I started out: true stories of becoming a nurse |
Gutkind, Lee |
|
| 1733 |
 |
Nurse, Come You Here!: More True Stories of a Country Nurse on a Scottish Isle |
Mary J. Macleod |
|
| 1734 |
 |
Peaceful Passages: A Hospice Nurse's Stories of Dying Well |
Janet Wehr |
|
| 1735 |
 |
The Bell Lap: Stories for Compassionate Nursing Care |
Murch, Muriel |
|
| 1736 |
 |
Nightingale Tales: Stories from My Life as a Nurse |
Lynn Dow, RN |
|
| 1737 |
 |
Great Australian Outback Nurses Stories |
Bill Marsh |
|
| 1738 |
 |
Blitz Hospital: True Stories of Nursing in Wartime London |
Penny Starns |
|
| 1739 |
 |
Stories from the Tenth-Floor Clinic: A Nurse Practitioner Remembers |
Marianna Crane |
|
| 1740 |
 |
The Country Nurse Remembers: True Stories of a Troubled Childhood, War, and Becoming a Nurse |
MacLeod, Mary J |
|
| 1741 |
 |
Spiritual Dimensions of Advanced Practice Nursing: Stories of Hope (Advanced Practice in Nursing) |
Melanie Rogers (editor) |
|
| 1742 |
 |
The Rebel Nurse Handbook: Inspirational Stories by Shift Disruptors |
Rebecca Love |
|
| 1743 |
 |
The Power and Pain of Nursing: Self-Care Practices to Protect and Replenish Compassion |
Beth Cavenaugh |
|
| 1744 |
 |
This is really war: the incredible true story of a Navy nurse POW in the occupied Philippines |
Los Baños Internment Camp,Danner, Dorothy Still,Lucchesi, Emilie Le Beau |
|
| 1745 |
 |
European Psychiatric/Mental Health Nursing in the 21st Century: A Person-Centred Evidence-Based Approach |
José Carlos Santos, John R. Cutcliffe |
|
| 1746 |
 |
Wide Neighborhoods: A Story of the Frontier Nursing Service |
Mary Breckinridge |
|
| 1747 |
 |
Taking Care: The Story of Nursing and Its Power to Change Our World |
Sarah DiGregorio |
|
| 1748 |
 |
NURSING AND INFORMATICS FOR THE 21ST CENTURY, BOOK 1 : realizing. [3 ed.] |
|
3 |
| 1749 |
 |
From Sun to Sun: A Hospice Nurse Reflects on the Art of Dying |
Nina Angela McKissock |
|
| 1750 |
 |
Becoming a nurse in the 21st century |
Ian Peate, Maxine Offredy |
|
| 1751 |
 |
The Care Factor: A story of nursing and connection in the time of social distancing |
Ailsa Wild |
|
| 1752 |
 |
Soviet Nightingales: Care under Communism |
Susan Grant, Liverpool John Moores University |
|
| 1753 |
 |
Nursing and Informatics for the 21st Century - Embracing a Digital World, Book 1: Realizing Digital Health - Bold Challenges and Opportunities for Nursing |
Connie White Delaney, Charlotte A. Weaver, Joyce Sensmeier, Lisiane Pruinelli, Patrick Weber |
|
| 1754 |
 |
Florence Nightingale: The Angel of the Crimea, a Story for Young People |
Laura E. Richards |
|
| 1755 |
 |
Nursing and Informatics for the 21st Century: An International Look at Practice, Education and EHR Trends, Second Edition [2 ed.] |
Charlotte Weaver (Author), Connie Delaney (Author), Patrick Weber (Author), Robyn Carr (Author) |
2 |
| 1756 |
 |
Nurse On Call: The True Story of a 1950s District Nurse |
Edith Cotterill |
|
| 1757 |
 |
Bread, Jam and a Borrowed Pram: A Nurse's Story from the Streets |
Dot May Dunn |
|
| 1758 |
 |
Catching Homelessness: A Nurse's Story of Falling Through the Safety Net |
Josephine Ensign |
|
| 1759 |
 |
Women at War: Story of Fifty Military Nurses Who Served in Vietnam |
Elizabeth M. Norman |
|
| 1760 |
 |
Evidence-Based Leadership Success Strategies for Nurse Administrators, Advance Practice Nurses (APN), and Doctors of Nursing Practice (DNP) [1 ed.] |
Darlene Sredl (Associate Teaching Professor of Nursing, Chesterfield, MO) |
1 |
| 1761 |
 |
Guide to the Code of Ethics for Nurses with Interpretative Statements: Development, Interpretation, and Application [Unknown Binding ed.] |
Marsha Diane Mary Fowler, American Nurses Association |
|
| 1762 |
 |
CONDITION CRITICAL: The Story of a Nurse Continues |
Echo Heron |
|
| 1763 |
 |
European Psychiatric/Mental Health Nursing in the 21st Century: A Person-Centred Evidence-Based Approach [1 ed.] |
José Carlos Santos,John R. Cutcliffe (eds.) |
1 |
| 1764 |
 |
Global Health Nursing in the 21st Century [1 ed.] |
Suellen Breakey, Inge B. Corless, Nancy L. Meedzan, Patrice K. Nicholas |
1 |
| 1765 |
 |
Nurse! Nurse!: A Student Nurse's Story |
Jimmy Frazier |
|
| 1766 |
 |
Nursing and Informatics for the 21st Century: an International Look at Practice, Education and EHR Trends, Second Edition [2nd ed] |
Carr, Robyn, Delaney, Connie, Weaver, Charlotte, Weber, Patrick |
2 |
| 1767 |
 |
Winds over Jerusalem : The Story of Rae Landy, Pioneer Nurse of Hadassah |
Debbi Perkul |
|
| 1768 |
 |
The New Arrival: The Heartwarming True Story of a 1970s Trainee Nurse |
Sarah Beeson |
|
| 1769 |
 |
The New Arrival: Part 2 of 3: The Heartwarming True Story of a 1970s Trainee Nurse |
Sarah Beeson |
|
| 1770 |
 |
The Maturing Sun: An Army Nurse in India, 1942-45 |
Bolton A. |
|
| 1771 |
 |
AACN essentials of critical care nursing : pocket handbook |
Marianne Chulay, Suzanne M Burns, American Association of Critical-Care Nurses |
|
| 1772 |
 |
Intensive Care Nursing [1 ed.] |
Philip Woodrow |
1 |
| 1773 |
 |
Fundamentals of Critical Care : A Textbook for Nursing and Healthcare Students, 1e [1 ed.] |
Ian Peate, Barry Hill |
1 |
| 1774 |
 |
Understanding the essentials of critical care nursing [Third edition] |
MacLeod, Carrie Edgerly, Perrin, Kathleen Ouimet |
3 |
| 1775 |
 |
Neonatal Intensive Care Nursing [1 ed.] |
Glenys Boxwell |
1 |
| 1776 |
 |
Penner’s Economics and Financial Management for Nurses and Nurse Leaders [4 ed.] |
Mary Lynne Knighten (editor), KT Waxman (editor) |
4 |
| 1777 |
 |
Concept mapping: a critical-thinking approach to care planning [3rd ed] |
Schuster, Pamela McHugh |
3 |
| 1778 |
 |
Compact Clinical Guide to Critical Care, Trauma, and Emergency Pain Management: An Evidence-Based Approach for Nurses [1st ed.] |
Liza Marmo, Yvonne D’Arcy |
1 |
| 1779 |
 |
Critical Care Nursing. Diagnosis and Management |
Urden Linda D., Stacy Kathleen M., Lough Mary E. |
|
| 1780 |
 |
AACN Core Curriculum for Pediatric High Acuity, Progressive, and Critical Care Nursing |
Margaret Slota DNP RN FAAN (editor) |
|
| 1781 |
 |
Leerboek intensive-care-verpleegkunde kinderen |
G.T.W.J. van den Brink, T.N.C. Tol, E.M. van Vught |
|
| 1782 |
 |
Critical care: a new nurse faces death, life, and everything in between [First Harperone edition] |
Brown, Theresa |
|
| 1783 |
 |
Critical Care Nursing of the Oncology Patient [1 ed.] |
Lisa Parks, Meghan Routt, Oncology Nursing Society Staff |
1 |
| 1784 |
 |
INTERVENTIONAL CRITICAL CARE : a manual for advanced practice providers. [2 ed.] |
|
2 |
| 1785 |
 |
AWHONN's High-Risk & Critical Care Obstetrics [4 ed.] |
Nan H. Troiano RN MSN, Patricia M. Witcher RN MSN, Suzanne Baird DNP RN |
4 |
| 1786 |
 |
Critical Thinking in Long-Term Care Nursing: Skills to Assess, Analyze, and Act |
Shelley Cohen |
|
| 1787 |
 |
Essential of Critical Care Nursing [Second Edition] |
Jaya Kurvelle |
2 |
| 1788 |
 |
Nursing in Critical Care Setting: An Overview from Basic to Sensitive Outcomes |
Irene Comisso, Alberto Lucchini, Stefano Bambi, Gian Domenico Giusti, Matteo Manici |
|
| 1789 |
 |
Caring in Crisis: An Oral History of Critical Care Nursing [Reprint 2016 ed.] |
Jacqueline Zalumas |
2016 |
| 1790 |
 |
Practical Issues Updates in Anesthesia and Intensive Care [1 ed.] |
Davide Chiumello (eds.) |
1 |
| 1791 |
 |
Critical care nursing demystified [Second ed.] |
Aurora L. Weaver, James Edward Keogh, Cynthia Lee Terry |
2 |
| 1792 |
 |
Fast Facts for the Critical Care Nurse: Critical Care Nursing in a Nutshell [1 ed.] |
Michele Angell Landrum ADN RN CCRN |
1 |
| 1793 |
 |
Eunice Dyke, health care pioneer : from pioneer public health nurse to advocate for the aged |
Marion V Royce |
|
| 1794 |
 |
CCRN review book and study guide - Exam Book with 450 Questions and 3 Practice Tests for Critical Care Nursing Certification |
Pawla Sara Lukas |
|
| 1795 |
 |
Critical Care Outreach [1 ed.] |
Lee Cutler, Wayne Robson |
1 |
| 1796 |
 |
New to ICU: A Visual Guide to Critical Care Nursing |
Lauren Douglass |
|
| 1797 |
 |
Critical Care Notes: Clinical Pocket Guide [2 ed.] |
Janice Jones, Brenda Fix |
2 |
| 1798 |
 |
Developing Expertise in Critical Care Nursing [1 ed.] |
Julie Scholes |
1 |
| 1799 |
 |
Critical Care Nursing of Older Adults: Best Practices, Third Edition [3 ed.] |
Marquis D. Foreman PhD RN FAAN, Dr. Koen Milisen PhD RN, Terry T. Fulmer PhD RN FAAN |
3 |
| 1800 |
 |
Economics and Financial Management for Nurses and Nurse Leaders [3rd ed.] |
Susan J Penner |
3 |
| 1801 |
 |
Fast Facts for the Critical Care Nurse [2nd Edition] |
Dina Hewett |
2 |
| 1802 |
 |
Mechanical Ventilation in Critical Care Transport |
Susan R. Wilcox, Jason Cohen, Michael Frakes |
|
| 1803 |
 |
Critical Care Nursing: Learning from Practice |
Suzanne Bench |
|
| 1804 |
 |
A Daybook for Critical Care Nurses [1 ed.] |
Eileen Gallen, RN Bademan |
1 |
| 1805 |
 |
Home Care of the Sick [9] |
Amy Elizabeth Pope |
9 |
| 1806 |
 |
Understanding the Essentials of Critical Care Nursing [3 ed.] |
Kathleen Perrin, Carrie MacLeod |
3 |
| 1807 |
 |
Health Care Finance, Economics, and Policy for Nurses: A Foundational Guide [Paperback ed.] |
Betty Rambur |
|
| 1808 |
 |
Antimicrobial Stewardship for Nursing Practice [Illustrated] |
Molly Courtenay (editor), Enrique Castro-Sánchez (editor) |
|
| 1809 |
 |
From beginner to expert: Gaining a differentiated clinical world in critical care nursing |
Patricia Benner, Christine Tanner, Catherine Chesla |
|
| 1810 |
 |
Springhouse Review for Critical Care Nursing Certification [Fourth ed.] |
Springhouse |
4 |
| 1811 |
 |
Critical Care Nursing: A Holistic Approach [Hardcover ed.] |
Patricia Gonce Morton, Dorrie K. Fontaine |
|
| 1812 |
 |
Lippincott Manual of Nursing Practice Pocket Guide: Critical Care Nursing [1st ed.] |
Springhouse |
1 |
| 1813 |
 |
Concept Mapping: A Critical-Thinking Approach to Care Planning [2 ed.] |
Dr Pamela Schuster |
2 |
| 1814 |
 |
INTENSIVE CARE |
Echo Heron |
|
| 1815 |
 |
Advanced Practice in Critical Care: A Case Study Approach [1 ed.] |
Sarah McGloin, Anne McLeod |
1 |
| 1816 |
 |
The AACN procedure manual for high-acuity, progressive, and critical care |
Belle, Margaret |
|
| 1817 |
 |
Davis Advantage for Pediatric Nursing Critical Components of Nursing Care [Third ed.] |
Kathryn Rudd, Diane Kocisko |
3 |
| 1818 |
 |
Davis Advantage for Maternal-Newborn Nursing Critical Components of Nursing Care [Fourth ed.] |
Durham, Roberta, Chapman, Linda, Miller, Connie |
4 |
| 1819 |
 |
Critical Care Nursing Care Plan [1 ed.] |
RN, MS, CCRN, Sheree Comer |
1 |
| 1820 |
 |
Health care finance, economics, and policy for nurses : a foundational guide [Second ed.] |
Betty Rambur |
2 |
| 1821 |
 |
Critical Thinking in the Intensive Care Unit: Skills to Assess, Analyze, and Act |
Shelley Cohen |
|
| 1822 |
 |
Intensive Care Nursing: A Framework For Practice [2 ed.] |
Philip Woodrow |
2 |
| 1823 |
 |
Angel of Bataan: The Life of a World War II Army Nurse in the War Zone and at Home |
Walter Macdougall |
|
| 1824 |
 |
Economics and Financial Management for Nurses and Nurse Leaders : Second Edition [2 ed.] |
Susan J. Penner, Susan J Rn Mn Mpa Drph Cnl Penner |
2 |
| 1825 |
 |
Health Care Finance, Economics, and Policy for Nurses [3 ed.] |
Rambur, Betty, |
3 |
| 1826 |
 |
Intensive care nursing : a framework for practice [Fourth edition.] |
Philip Woodrow |
4 |
| 1827 |
 |
Fostering a Research-Intensive Organization: An Interdisciplinary Approach for Nurses From Massachusetts General Hospital : An Interdisciplinary Approach for Nurses From Massachusetts General Hospital [1 ed.] |
Jeanette Ives Erickson, Marianne Ditomassi, Dorothy A. Jones |
1 |
| 1828 |
 |
Delmar's NCLEX-PN Review [2 ed.] |
Judith C. Miller |
2 |
| 1829 |
 |
Delmar's Practice Questions for NCLEX-PN [2nd ed.] |
Judith C. Miller, Janet Tompkins McMahon |
2 |
| 1830 |
 |
Neuroscience nursing: evidence-based practice |
Mestecky, Ann-Marie,Woodward, Woodward Susan Janet |
|
| 1831 |
 |
The person with HIV/AIDS : nursing perspectives [4 ed.] |
Felissa R. Lashley, Jerry D. Durham |
4 |
| 1832 |
 |
Legal Aspects Of Nursing, 4th Edition [4 ed.] |
Bridgit Dimond |
4 |
| 1833 |
 |
Nursing care of older people with diabetes |
Trisha Dunning |
|
| 1834 |
 |
Depression - a nurse's experience : shadows of life |
Veronica Burton, Paul Farmer(Foreword) |
|
| 1835 |
 |
Evidence-Based Geriatric Nursing Protocol for Best Practice |
Elizabeth A Capezuti, DeAnne Zwicker, Mathy Mezey |
3 |
| 1836 |
 |
Home health care provider : a guide to essential skills |
Emily Prieto |
|
| 1837 |
 |
Dictionary of Nursing Theory and Research [3rd ed] |
Bethel Ann Powers RN PhD, Thomas R. Knapp EdD |
3 |
| 1838 |
 |
TEACHING IN NURSING AND ROLE OF THE EDUCATOR, [THIRD ed.] |
MARILYN OERMANN |
3 |
| 1839 |
 |
Essentials of Clinical Genetics in Nursing Practice [1 ed.] |
Felissa R. Lashley RN PhD ACRN FAAN FACMG |
1 |
| 1840 |
 |
Ross-Kerr and Wood’s Canadian Nursing Issues & Perspectives 6th edition Test Bank [6 ed.] |
Lynn McCleary, Tammie R. McParland |
6 |
| 1841 |
 |
Always pack a candle: a nurse in the Cariboo-Chilcotin |
Marion McKinnon Crook |
|
| 1842 |
 |
Correctional nursing : scope and standards of practice [Third ed.] |
American Nurses Association. |
3 |
| 1843 |
 |
Clinical Consult to Psychiatric Mental Health Management for Nurse Practitioners [2 ed.] |
Laura A. Mandos, Jennifer A. Reinhold, Jacqueline Rhoads |
2 |
| 1844 |
 |
Nursing School Entrance Exams Prep 2021-2022 |
Kaplan Nursing |
|
| 1845 |
 |
Textbook of Microbiology for GNM Nursing Students [Second Edition] |
Mrinalini Bakshi |
2 |
| 1846 |
 |
Translation of evidence into nursing and healthcare [Third edition.] |
Mary F. Terhaar (editor), Kathleen Murphy White (editor), Sharon Dudley-Brown (editor) |
3 |
| 1847 |
 |
L'infirmier(e) et les soins palliatifs: Prendre soin : éthique et pratiques [6 ed.] |
Cicely Saunders |
6 |
| 1848 |
 |
Bien débuter - Neurologie-Neurochirurgie: Bonnes pratiques infirmières en fiches |
Blandine Chauvière, Audrey Oulebsir, Flore Baronnet-Chauvet |
|
| 1849 |
 |
Entrée en IFSI 2021-2022 - AS/AP et reconversion professionnelle: Sélection sur épreuves et/ou via Parcoursup - Toutes les clés pour réussir |
Ghyslaine Benoist |
|
| 1850 |
 |
Textbook of Midwifery and Obstetrical Nursing [First Edition] |
Sandeep Kaur |
|
| 1851 |
 |
Essentials of Basic Nursing Procedures [Second Edition] |
C. P. Thresyamma |
2 |
| 1852 |
 |
Nurses Contributions to Quality Health Outcomes |
Marianne Baernholdt, Diane K. Boyle |
|
| 1853 |
 |
Diagnóstico de Enfermería en el Perú. Una perspectiva histórica y de equidad de género |
Margarita Zegarra, Ybeth Arias, Claudia Núñez, Mariemma Mannarelli, Erika Figueroa, Paloma Rodríguez |
|
| 1854 |
 |
Travel health nursing : scope and standards of practice [1 ed.] |
American Travel Health Nurses Association, (editor), American Nurses Association, (editor) |
1 |
| 1855 |
 |
Introduction to Nursing Informatics [5 ed.] |
Pamela Hussey Margaret (editor), Ann Kennedy (editor) |
5 |
| 1856 |
 |
Integrative Health Nursing Interventions for Vulnerable Populations [1st ed.] |
Amber Vermeesch |
1 |
| 1857 |
 |
Davis Advantage for Basic Nursing: Thinking, Doing, and Caring: Thinking, Doing, and Caring [3 ed.] |
Leslie S. Treas PhD RN CPNP-PC NNP-BC, Karen L. Barnett DNP RN, Mable H. Smith PhD JD MN NEA-BC |
3 |
| 1858 |
 |
Interdisciplinary Nutritional Management and Care for Older Adults: An Evidence-Based Practical Guide for Nurses [1 ed.] |
Ólöf G. Geirsdóttir, Jack J. Bell |
1 |
| 1859 |
 |
Cardiac Nursing [7 ed.] |
Elizabeth M. Perpetua DNP, KEEGAN CONSULTING LLC |
7 |
| 1860 |
 |
Burn Care and Treatment: A Practical Guide [2nd Edition] |
Marc G. Jeschke, Lars-Peter Kamolz, Shahriar Shahrokhi |
2 |
| 1861 |
 |
PAX Study Guide Book 2020 & 2021: NLN PAX RN & PN Study Guide 2020 & 2021 and Practice Test Questions for the NLN Pre Entrance Exam [Updated for the NEW Outline] |
Test Prep Books |
|
| 1862 |
 |
The Healing Power of Touch – Guidelines for Nurses and Practitioners: External Applications in Pediatrics [1st ed. 2022] |
Georg Seifert (editor), Alfred Längler (editor) |
1 |
| 1863 |
 |
L'anatomie et la physiologie pour les infirmier(e)s [4 ed.] |
Sophie Dupont, Anne Muller |
4 |
| 1864 |
 |
Evidence-based geriatric nursing protocols for best practice [6 ed.] |
DeAnne Zwicker (editor), Marie Boltz (editor), Liz Capezuti (editor), Terry T. Fulmer (editor) |
6 |
| 1865 |
 |
Entrée en IFAS-IFAP: DOSSIER + ORAL - Aide-soignant et Auxiliaire de puériculture |
Ghyslaine Benoist |
|
| 1866 |
 |
Discipline of Nursing: Three–time Knowledge |
Michel Nadot |
|
| 1867 |
 |
Procedure Manual for Community Health Nursing [First Edition] |
N. Gowri &, G. Grace Jebakani Sweety |
|
| 1868 |
 |
Psychiatric Nursing: Contemporary Practice [7 ed.] |
Mary Ann Boyd, Rebecca Ann Luebbert |
7 |
| 1869 |
 |
The Royal Marsden Manual of Clinical Nursing Procedures, Student Edition [10th Edition] |
Sara Lister, Justine Hofland, Hayley Grafton, Catherine Wilson |
10 |
| 1870 |
 |
Altersgemischte Teams in der Pflege : Miteinander arbeiten - voneinander lernen [1. Aufl.] |
Jessica Schäfer |
1 |
| 1871 |
 |
Surgical Technology: Principles and Practice [8 ed.] |
Joanna Kotcher Fuller |
8 |
| 1872 |
 |
The Royal Marsden Manual of Clinical Nursing Procedures, Student Edition [10 ed.] |
Sara Lister, Justine Hofland, Hayley Grafton, Catherine Wilson |
10 |
| 1873 |
 |
Successful Doctoral Training in Nursing and Health Sciences: A Guide for Supervisors, Students and Advisors [1st ed. 2022] |
Debra Jackson, Patricia M. Davidson, Kim Usher |
1 |
| 1874 |
 |
Providing HIV Care: Lessons from the Field for Nurses and Healthcare Practitioners [1st ed.] |
Michelle Croston, Ian Hodgson |
1 |
| 1875 |
 |
Providing HIV Care: Lessons from the Field for Nurses and Healthcare Practitioners |
Michelle Croston, Ian Hodgson |
|
| 1876 |
 |
Principles and Practice of Palliative Care and Support Oncology [5 ed.] |
Ann M. Berger, Joseph F. O’Neill |
5 |
| 1877 |
 |
EKGS for the nurse practitioner and physician assistant [Third ed.] |
Maureen A. Knechtel |
3 |
| 1878 |
 |
Emotionsarbeit in der Pflege: Beitrag zur Diskussion über die psychische Gesundheit Pflegender in der stationären Altenpflege [1. Aufl.] |
Cornelia Schmedes |
1 |
| 1879 |
 |
Grundlagen der Kommunikation für Gesundheitsberufe: Leitfaden für Logopäden, Physiotherapeuten, Ergotherapeuten und Pflege [1 ed.] |
Ursula Herter-Ehlers |
1 |
| 1880 |
 |
the Art & science of nurse coaching : the provider's guide to coaching scope and competencies [2 ed.] |
Barbara Montgomery Dossey, Mary Elaine Southard, Linda Bark, Bonney Gulino Schaub |
2 |
| 1881 |
 |
Anatomie et physiologie en fiches pour les étudiants en IFSI: Avec un site Internet d'entraînements interactifs [2 ed.] |
Anne Muller, Julie Cosserat |
2 |
| 1882 |
 |
Ein Engel in der Hölle von Auschwitz: Das Leben der Krankenschwester Maria Stromberger |
Harald Walser |
|
| 1883 |
 |
Fast facts for the radiology nurse : an orientation and nursing care guide [Second ed.] |
Valerie G. A. Grossman (editor) |
2 |
| 1884 |
 |
Pharmacotherapeutics for Advanced Practice: A Practical Approach [5 ed.] |
Virginia Poole Arcangelo, Andrew M. Peterson, Veronica Wilbur, Jennifer A. Reinhold |
5 |
| 1885 |
 |
Davis's Comprehensive manual of laboratory and diagnostic tests with nursing implications [9 ed.] |
Mickey Lynn Bladh, Anne M. Van Leeuwen |
9 |
| 1886 |
 |
Research for Advanced Practice Nurses: From Evidence to Practice [4 ed.] |
Beth A. Staffileno (editor) |
4 |
| 1887 |
 |
Child and Adolescent Behavioral Health: A Resource for Advanced Practice Psychiatric and Primary Care Practitioners in Nursing [2 ed.] |
Edilma L. Yearwood, Geraldine S. Pearson, Jamesetta A. Newland |
2 |
| 1888 |
 |
Nursing: Scope and Standards of Practice [4 ed.] |
American Nurses Association |
4 |
| 1889 |
 |
Anatomy of Writing for Publication for Nurses [4 ed.] |
Cynthia Saver |
4 |
| 1890 |
 |
Sexual Function and Pelvic Floor Dysfunction: A Guide for Nurses and Allied Health Professionals |
Angie Rantell (editor) |
|
| 1891 |
 |
The nurse mentor's handbook : supporting and assessing students in clinical practice [Third ed.] |
Danny Walsh |
3 |
| 1892 |
 |
Chirurgie für die Pflege |
Burkhard Paetz |
|
| 1893 |
 |
Enfermería y covid-19 en el Perú. Enfrentando hegemonías, combatiendo una pandemia, construyendo una profesión |
José Iturri, Rutsmy Gallegos, Penélope Brou, Mario Rovere |
|
| 1894 |
 |
Transformational leadership in nursing from expert clinician to influential leader [Third edition.] |
Elaine S. Marshall, Marion Broome, Elaine S. Marshall (editor), Marion Broome (editor) |
3 |
| 1895 |
 |
基础护理技术(数字案例版) |
陈鲁,燕雪琴,左凤林主编 |
|
| 1896 |
 |
A Canadian Nurse in the Great War: The Diaries of Ruth Loggie, 1915-1916 [1 ed.] |
Ross Hebb |
1 |
| 1897 |
 |
CliffsNotes HESI A2 Science Cram Plan |
Michael Reid |
|
| 1898 |
 |
Saunders StrategieS for TesT SuCCeSS 2020 |
linda angela , silvestri |
|
| 1899 |
 |
Clinical Nursing Skills at a Glance (At a Glance (Nursing and Healthcare)) (Nov 8, 2021)_(1119035902)_(Wiley-Blackwell) |
|
|
| 1900 |
 |
Evaluation and testing in nursing education [Sixth edition.] |
Kathleen B. Gaberson, Marilyn H. Oermann |
6 |
| 1901 |
 |
Clinical Teaching Strategies in Nursing, Third Edition |
Dr. Kathleen Gaberson Ph.D. RN CNOR CNE ANEF, Dr. Marilyn Oermann Ph.D. RN FAAN ANEF |
3 |
| 1902 |
 |
A Nurse's War: A Diary of Hope and Heartache on the Home Front |
Patricia Malcolmson |
|
| 1903 |
 |
ATI TEAS Study Manual TEAS 6 Study Guide & Practice Test |
Test Prep Books |
|
| 1904 |
 |
Measuring Capacity to Care Using Nursing Data [1 ed.] |
Evelyn Hovenga RN PhD FACHI FACS FACN FIAHSI, Cherrie Lowe RN RM Dip Teaching (Nursing) PG Dip Hospital Admin AFACHM MACN |
1 |
| 1905 |
 |
Kozier & Erb's Fundamentals of Nursing: Concepts, Process and Practice [RENTAL EDITION] (11th Edition) [11 ed.] |
Audrey T. Berman, Shirlee Snyder, Geralyn Frandsen EdD MSN RN |
11 |
| 1906 |
 |
Health assessment & physical examination [3rd Australian and New Zealand edition.] |
Theresa Harvey, Karen Theobald, Mary Ellen Zator Estes, Pauline Calleja |
3 |
| 1907 |
 |
Clinical Psychomotor Skills [9 ed.] |
Joanne Tollefson, Elspeth Hillman |
9 |
| 1908 |
 |
Pharmacology for Nurses: A Pathophysiologic Approach [4th Edition] |
Michael Adams, Leland Holland Ph.D., Carol Urban |
4 |
| 1909 |
 |
Pharmacology for Nurses: A Pathophysiologic Approach [6 ed.] |
Michael P. Adams, Norman Holland, Carol Quam Urban |
6 |
| 1910 |
 |
Mosby's drug guide for nursing students [Fourteenth ed.] |
Linda Skidmore-Roth |
14 |
| 1911 |
 |
FLORENCE NIGHTINGALE: the courageous life of the legendary nurse |
Reef, Catherine |
|
| 1912 |
 |
Migrant Health Professionals and the Global Labour Market: The Dreams and Traps of Nepali Nurses |
Radha Adhikari |
|
| 1913 |
 |
Learning and Work and the Politics of Working Life : Global Transformations and Collective Identities in Teaching, Nursing and Social Work [1 ed.] |
Terri Seddon, Lea Henriksson, Beatrix Niemeyer |
1 |
| 1914 |
 |
Routledge Handbook on the Global History of Nursing NIP [1 ed.] |
Patricia D'Antonio, Julie A. Fairman, Jean C. Whelan |
1 |
| 1915 |
 |
2020 NCLEX-RN Test Prep Questions and Answers with Explanations: Study Guide to Pass the License Exam Effortlessly--Exam Review for Registered Nurses |
U.S. Exam Prep. Professionals, Ltd. |
|
| 1916 |
 |
Using Your Head to Land on Your Feet : A Beginning Nurse's Guide to Critical Thinking [1 ed.] |
Bonnie, Ph.D. Raingruber, Ann Haffer |
1 |
| 1917 |
 |
Better Breastfeeding: A Doctor's Guide to Nursing Without Pain and Frustration |
Linda D. Dahl, MD |
|
| 1918 |
 |
The Black Angels |
Maria Smilios |
|
| 1919 |
 |
Complexity Leadership: Nursing's Role in Health Care Delivery [3 ed.] |
Diana M Crowell, Beth Boynton |
3 |
| 1920 |
 |
Nurses and Families: A Guide to Family Assessment and Intervention [4 ed.] |
Lorraine M., Ph.D. Wright, Maureen, Ph.D. Leahey |
4 |
| 1921 |
 |
The New Leadership Challenge: Creating The Future Of Nursing, 2nd Edition [2 ed.] |
Sheila C., Ph.D. Grossman, Theresa M., Ph.D. Valiga |
2 |
| 1922 |
 |
Essentials of E-Learning for Nurse Educators [1 ed.] |
Tim Bristol, Ph.D. RN, Tim J. Bristol, JoAnn Zerwekh |
1 |
| 1923 |
 |
Advanced Practice Nursing Procedures [2nd Edition] |
Margaret R. Colyar |
2 |
| 1924 |
 |
ADVANCED PRACTICE NURSING PROCEDURES. [2 ed.] |
NOT AVAILABLE. |
2 |
| 1925 |
 |
Nurses and Families: A Guide to Family Assessment and Intervention - 5th edition [5 ed.] |
Lorraine M., Ph.D. Wright, Maureen Leahey |
5 |
| 1926 |
 |
Flying Out With the Wounded |
Anne Caston |
|
| 1927 |
 |
Population-based nursing : concepts and competencies for advanced practice [Third ed.] |
Ann L. Cupp Curley |
3 |
| 1928 |
 |
Emergency nursing : 5-tier triage protocols [Second ed.] |
Julie K. Briggs, Valerie G. A. Grossman |
2 |
| 1929 |
 |
Global Health Nursing: Narratives from the Field [1 ed.] |
Christina Harlan, Rn Christina Harlan Ma |
1 |
| 1930 |
 |
Clinical Simulations for the Advanced Practice Nurse: A Comprehensive Guide for Faculty, Students, and Simulation Staff |
Celeste M. Alfes, Elizabeth P. Zimmermann |
|
| 1931 |
 |
Tappero and Honeyfield’s Physical Assessment of the Newborn: A Comprehensive Approach to the Art of Physical Examination [7 ed.] |
Catherine L. Witt PhD APRN NNP-BC (editor), Carol Wallman DNP APRN NNP-BC (editor) |
7 |
| 1932 |
 |
Self-Neglect in Older Adults: A Global, Evidence-Based Resource for Nurses and Other Healthcare Providers |
Mary Rose Day, Geraldine McCarthy, Joyce J. Fitzpatrick (eds.) |
|
| 1933 |
 |
Global Health Nursing: Building and Sustaining Partnerships [1 ed.] |
Michele Upvall, Jeanne Leffers |
1 |
| 1934 |
 |
Proposal writing for clinical nursing and DNP projects [Third ed.] |
Katharine Vogel Smith, Wanda E. Bonnel |
3 |
| 1935 |
 |
Fast Facts for the Clinical Nursing Instructor [4 ed.] |
Eden Zabat Kan PhD RN, Susan Stabler-Haas MSN RN PMHCNS-BC |
4 |
| 1936 |
 |
Advanced pediatric assessment [Third ed.] |
Ellen M. Chiocca |
3 |
| 1937 |
 |
Project management for the advanced practice nurse [Second edition.] |
Carolyn Sipes |
2 |
| 1938 |
 |
Evidence-Based Physical Examination: Best Practices for Health & Well-Being Assessment (Paperback) – Comprehensive Book for Teaching Physical and Health Assessment Techniques [1 ed.] |
Kate Gawlik DNP APRN-CNP FAANP, Bernadette Melnyk PhD APRN-CNP FAANP FNAP FAAN, Alice Teall DNP APRN-CNP FAANP |
1 |
| 1939 |
 |
Adult-Gerontology Practice Guidelines [3 ed.] |
Jill C. Cash MSN APN FNP-BC (editor) |
3 |
| 1940 |
 |
Clinical Nurse Leader Certification Review, 3e (Sep 24, 2020)_(0826164560)_(Springer Publishing Company) |
|
|
| 1941 |
 |
Adult-Gerontology Practice Guidelines [Team-IRA] |
Jill C. Cash, MSN, APN, FNP-BC,, McQueen Blair, L.Douglas Smith Jr. |
|
| 1942 |
 |
Advanced Health Assessment of Women: Skills, Procedures, and Management [5 ed.] |
R. Mimi Secor, Helen A. Carcio |
5 |
| 1943 |
 |
Nursing Informatics for the Advanced Practice Nurse [3 ed.] |
Susan McBride, Mari Tietze |
3 |
| 1944 |
 |
Competency Based Nursing Education: Guide to Achieving Outstanding Learner Outcomes [1 ed.] |
Dr. Marion Anema Ph.D. RN, Dr. Jan McCoy PhD RN |
1 |
| 1945 |
 |
Clinical Teaching Strategies in Nursing, Third Edition [3 ed.] |
Dr. Kathleen Gaberson Ph.D. RN CNOR CNE ANEF, Dr. Marilyn Oermann Ph.D. RN FAAN ANEF |
3 |
| 1946 |
 |
Fast Facts for the New Nurse Practitioner: What You Really Need to Know in a Nutshell [1 ed.] |
Dr. Nadine Aktan Ph.D. RN FNP-BC |
1 |
| 1947 |
 |
School Nursing: The Essential Reference |
Janice Loschiavo |
|
| 1948 |
 |
Quality and Safety Education for Nurses: Core Competencies for Nursing Leadership and Care Management [3 ed.] |
Patricia Kelly, Beth A. Vottero, Gerry Altmiller |
3 |
| 1949 |
 |
Complementary Therapies in Nursing: Promoting Integrative Care [9 ed.] |
Ruth Lindquist PhD RN (editor), Mary Fran Tracy PhD RN APRN CNS FCNS FAAN (editor), Mariah Snyder PhD (editor) |
9 |
| 1950 |
 |
Psychiatric - Mental Health Nursing Scope and Standards of Practice [3 ed.] |
American Nurses Association |
3 |
| 1951 |
 |
Challenges in Nursing Education and Research-Proceeding of the Second Aceh International Nursing Conference 2019 (2nd AINC 2019), August 21-22, 2019, Banda Aceh, Indonesia [1 ed.] |
Teuku Tahlil (Editor), Hajjul Kamil (Editor), Asniar (Editor), Marthoenis (Editor) |
1 |
| 1952 |
 |
Environmental Health In Nursing [3 ed.] |
Ruth McDermott-Levy, Kathryn Jackman-Murphy, Jeanne Leffers |
3 |
| 1953 |
 |
Learning and Intellectual Disability Nursing Practice [2 ed.] |
Kay Mafuba |
2 |
| 1954 |
 |
Routledge Handbook of Philosophy and Nursing [1 ed.] |
Martin Lipscomb (editor) |
1 |
| 1955 |
 |
Maternal and Child Health Nursing: Care of the Childbearing and Childrearing Family [Hardcover] |
Joanne Flagg |
Hardcover |
| 1956 |
 |
A Textbook of Community Nursing [3 ed.] |
Sue Chilton (editor), Heather Bain (editor) |
3 |
| 1957 |
 |
Fundamentals of Nursing and Midwifery Research: A Practical Guide for Evidence-based Practice [2 ed.] |
Lisa McKenna, Beverley Copnell |
2 |
| 1958 |
 |
Nursing Practice: Knowledge and Care [3 ed.] |
Ian Peate (editor), Aby Mitchell (editor) |
3 |
| 1959 |
 |
Orthopaedic and Trauma Nursing: An Evidence-based Approach to Musculoskeletal Care [2 ed.] |
Sonya Clarke, Mary Drozd |
2 |
| 1960 |
 |
Stroke nursing [Second edition.] |
Jane E. Williams (editor), Lin Perry (editor), Caroline Leigh Watkins (editor) |
2 |
| 1961 |
 |
Advanced Clinical Practice at a Glance, 1e [1 ed.] |
Barry Hill, Sadie Diamond Fox, Ian Peate |
1 |
| 1962 |
 |
Independent and Supplementary Prescribing At a Glance (At a Glance (Nursing and Healthcare)) (Nov 14, 2022)_(111983791X)_(Wiley-Blackwell) |
|
|
| 1963 |
 |
Clinical Leadership in Nursing and Healthcare [3 ed.] |
David Stanley, Clare L. Bennett, Alison H. James |
3 |
| 1964 |
 |
Lower Limb and Leg Ulcer Assessment and Management |
Aby Mitchell, Georgina Ritchie, Alison Hopkins |
|
| 1965 |
 |
Routledge Handbook of Global Mental Health Nursing: Evidence, Practice and Empowerment [1 ed.] |
Edilma Yearwood (editor), Vicki Hines-Martin (editor) |
1 |
| 1966 |
 |
Birthing Outside the System : The Canary in the Coal Mine (Routledge Research in Nursing and Midwifery) [1 ed.] |
Hannah Dahlen (editor), Bashi Kumar-Hazard (editor), Virginia Schmied (editor) |
1 |
| 1967 |
 |
Curriculum development in nursing education [Fourth ed.] |
Dolly Goldenberg, Mary-Anne Andrusyszyn, Carroll L. Iwasiw |
4 |
| 1968 |
 |
Professional Nursing Concepts: Competencies for Quality Leadership [6 ed.] |
Anita Finkelman |
6 |
| 1969 |
 |
Olds' Maternal-Newborn Nursing & Women's Health Across the Lifespan: Pearson New International Edition [9 ed.] |
Michele C. Davidson RN Ph.D. CNM, Marcia L. London, Patricia W Ladewig |
9 |
| 1970 |
 |
Policy and politics for nurses and other health professionals : advocacy and action [Third ed.] |
Donna M. Nickitas (editor), Veronica D. Feeg (editor), Donna J. Middaugh (editor) |
3 |
| 1971 |
 |
Management and leadership for nurse administrators [Eighth edition.] |
James Leonard Harris (editor), Linda Roussel (editor), Patricia L. Thomas (editor) |
8 |
| 1972 |
 |
Kozier and Erb's Fundamentals of Nursing: Concepts, Process, and Practice (Global Edition) [11 ed.] |
Audrey Berman, Shirlee Snyder, Geralyn Frandsen |
11 |
| 1973 |
 |
How to Treat People: A Nurse's Notes |
Molly Case |
|
| 1974 |
 |
Orem’s Model in Action |
Stephen J. Cavanagh RGN, BA(Nurs.), MS, MPA, Ph.D., MBIM (auth.) |
|
| 1975 |
 |
Everyday Nursing Ethics |
Kath M. Melia B.Nurs. (Manc.), Ph.D. (auth.) |
|
| 1976 |
 |
Hildegard E. Peplau, Selected Works: Interpersonal Theory in Nursing |
Anita Werner O’Toole R.N., C.S., Ph.D., Sheila Rouslin Welt R.N., M.S. (eds.) |
|
| 1977 |
 |
Management of Pain, Fatigue and Nausea |
Sandra G. Funk Ph.D., Elizabeth M. Tornquist M.A., Mary T. Champagne Ph.D., R.N., Laurel Archer Copp Ph.D., R.N., F.A.A.N., Ruth A. Wiese M.S.N., R.N. (eds.) |
|
| 1978 |
 |
Care of Older People with Diabetes - A Manual for Healthcare Practice (Feb 10, 2025)_(1394205031)_(Wiley-Blackwell).pdf |
|
|
| 1979 |
 |
Renal Nursing: Care and Management of People with Kidney Disease [6 ed.] |
Nicola Thomas, Helen Noble |
6 |
| 1980 |
 |
Notes On... Nursing Leadership [1 ed.] |
Alison H. James, David Stanley |
1 |